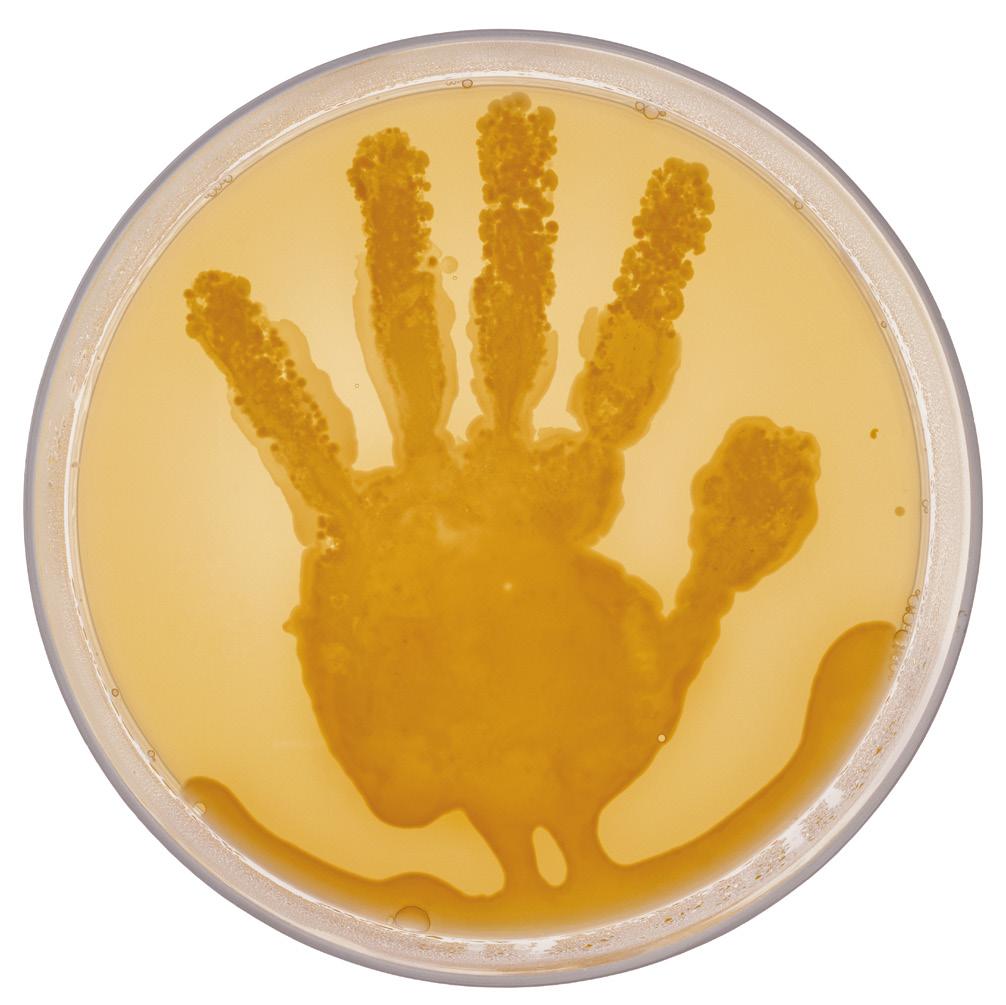

![]()


Mikhail Matveevich Plaksin geb. 1898, gest. 1965 in Russland
„Space Conquerors“, 1960er Gelatinsilberabzug, 60 × 51 cm
Sammlung SpallArt, Inv. Nr. S-1238, © Mikhail Matveevich Plaksin Estate
1 William A. Ewing, „Faszination Körper. Meisterfotografien der menschlichen Gestalt“, Leipzig 1994, S. 12–30
2
Jean Clair, ‚Form, Fragment und Fleisch‘, in: William A. Ewing (Hg.), „Das Jahrhundert des Körpers. Figürliches Fotografieren“, Berlin 2000, S. 13–28
Der menschliche Körper ist für Fotograf:innen ein vielschichtiges und faszinierendes Motiv. Seit den Anfängen der Fotografie im 19. Jahrhundert hat sich die Art und Weise, wie der Körper dargestellt wird, stetig gewandelt. Reflektiert werden gesellschaftliche Normen, Schönheitsideale sowie politische und kulturelle Strömungen. Bodies – körperbetonte Fotografie der Sammlung SpallArt widmet sich diesem Thema anhand unterschiedlicher Kategorien, die die Bandbreite fotografischer Körperdarstellungen ausloten. Die fotografische Darstellung des menschlichen Körpers reicht von klassischen Aktaufnahmen über dynamische Bewegungsstudien bis hin zu fragmentierten, inszenierten und verfremdeten Körperbildern. Künstler:innen spielen mit Licht, Perspektive und Inszenierung, um Bedeutungen zu schaffen.
In den Anfängen der Fotografie wurde der menschliche Körper klassisch und idealisiert dargestellt. Die ersten fotografischen Akte lehnten sich an die Traditionen der Malerei und Skulptur an, wobei Künstler:innen versuchten, klassische Ideale von Schönheit und Ästhetik mittels sanfter Lichtführung und weichen Kontrasten festzuhalten, um eine malerische Wirkung zu erzielen. Mit der Entwicklung neuer fotografischer Techniken begann sich die Darstellung des Körpers zu verändern. Im späten 19. und frühen 20. Jahrhundert führten Fotografen wie Eadweard Muybridge und Étienne-Jules Marey Studien zur Bewegung des menschlichen Körpers durch, die nicht nur wissenschaftliche Erkenntnisse förderten, sondern auch eine neue Art der Körperdarstellung ermöglichten.1 Künstler:innen der Avantgarde-Bewegungen nutzten die Fotografie, um mit ungewöhnlichen Perspektiven, Licht- und Schatteneffekten, sowie surrealen Elementen den Körper neu zu interpretieren. Für die Aktfotografie bedeutete die Erfindung und Verbreitung von Handkameras, verbesserten Objektiven und Filmmaterial, sowie die
Möglichkeit von künstlicher Belichtung, eine größere Freiheit und mehr Flexibilität im Umgang mit ihren Motiven. Die Aktfotografie etablierte sich als eigenständiges Genre, das sowohl künstlerisch als auch kommerziell genutzt wurde. Im Laufe des 20. Jahrhunderts wurde der Körper in der Fotografie zunehmend zum Ausdruck gesellschaftlicher, politischer und individueller Identitäten. Die dokumentarische Fotografie der 1960er und 1970er Jahre rückte den ungeschönten, realen Körper in den Mittelpunkt. Künstlerinnen, wie beispielsweise Nan Goldin, zeigten Menschen jenseits gängiger Schönheitsnormen und brachten damit gesellschaftliche Randgruppen ins Blickfeld der Öffentlichkeit. Diese realistische und oft schonungslose Darstellung des Körpers diente als Gegenpol zur idealisierten Ästhetik der Mode- und Werbefotografie.2 Der Körper wurde somit verstärkt als Medium der Selbstinszenierung und des Protests genutzt, beispielsweise in den Fotoarbeiten von Künstlerinnen wie Cindy Sherman und Francesca Woodman. In der zeitgenössischen Fotografie ist die Vielfalt der Körperdarstellungen größer denn je. Themen wie Body-Positivity, Geschlechtsidentität und Diversität prägen die aktuelle visuelle Kultur. Fotograf:innen setzen sich mit normativen Körperbildern auseinander und hinterfragen etablierte Schönheitsideale. Ihr Interesse liegt nicht mehr in der „traditionellen“ Darstellung des Körpers. Es geht vielmehr darum, den Körper als „Fleisch und Blut“, verwundbar und individuell zu zeigen. Von der künstlerischen Inszenierung über die Dokumentation bis hin zur Selbstrepräsentation in sozialen Medien, zeigt der fotografierte Körper, wie komplex und vielschichtig menschliche Identität und gesellschaftliche Normen sind. Die Auseinandersetzung mit dem Körper in der Fotografie bleibt daher ein zentrales Thema, das immer wieder neue Perspektiven eröffnet.
Cäcilia Steinkellner

George Segal
geb. 1924 in New York (US), gest. 2000 in New Brunswick (US)
Im Mai 1968 dokumentierte der deutsche Fotograf Stefan Moses die Ankunft einer Skulptur der Kraushaar Collection aus New York in München. Diese Sammlung wurde im Rahmen der Ausstellung Sammlung 1968: Karl Ströher in der Neuen Pinakothek im Haus der Kunst vom 14. Juni bis 9. August 1968 in München präsentiert. Die Ausstellung bot einen umfassenden Überblick über die zeitgenössische Kunst der 1960er Jahre, trug wesentlich zur Verbreitung und Anerkennung dieser Kunstrichtungen in Deutschland bei und hatte einen nachhaltigen Einfluss auf die Rezeption von Pop Art und Minimal Art im deutschsprachigen Raum.
Stefan Moses hielt sowohl den Aufbau als auch die Eröffnung der Ausstellung in München fotografisch fest, wodurch wertvolle Dokumente dieser bedeutenden Kunstveranstaltung entstanden. Besonders hervorzuheben sind dabei die Fotografien von Joseph Beuys während des Aufbaus seiner Werke. Diese Bilder haben einen hohen dokumentarischen Wert, da sie den Entstehungsprozess und die Präsentation von Beuys’ Arbeiten festhalten.
Unser Titelbild zeigt die Mitarbeiter des Haus der Kunst wie sie eine Skulptur des amerikanischer Künstlers George Segal im Garten platzieren. Die weibliche Figur stammt aus der Skulpturengruppe Rock and Roll Combo von 1964. In typischer Segal-Manier in Gips gehalten, zeigt die Skulpturengruppe eine Rock and Roll-Band.
Segals Arbeiten zeichnen sich durch ihre lebensnahen Darstellungen aus, die oft alltägliche Szenen einfangen und dabei eine gewisse Zeitlosigkeit vermitteln. Seine Verwendung von Gipsabdrücken realer Personen verleiht den Skulpturen eine besondere Authentizität und Präsenz.
Christoph Fuchs
•
Stefan Moses
geb. 1928 in Liegnitz (heute Legnica, PL), gest. 2018 in München (DE)
„Ankunft der Kraushaar-Collection N. Y., München“, 1968
Gelatinsilberabzug, 25,5 × 37 cm
Sammlung SpallArt, Inv. Nr. S-2878, © Stefan Moses

Die klassische Aktfotografie und somit das Interesse am menschlichen Körper als Experimentierfeld ist ein wichtiges Thema in der Fotografie. So widmet sich die Aktfotografie der Darstellung des nackten menschlichen Körpers und vereint technische Präzision mit künstlerischem Ausdruck.
In ihrer frühen Phase wurde die Aktfotografie oft als Studienmaterial für Maler:innen genutzt, doch schnell entwickelte sie sich zu einer eigenständigen Kunstform. Seit Beginn der Fotografie waren Darstellungen des nackten Körpers allgegenwärtig. Vor allem das Bild der Frau bewegte sich hierbei jedoch immer zwischen der schamhaften Darstellung von Schönheit und dem Frauentyp als Objekt der Begierde. Der nackte Mann wurde eher vernachlässigt, die ersten männlichen Aktaufnahmen entstanden aus wissenschaftlichem Interesse. Erst um 1900 tauchten erste erotische Aufnahmen von Männern auf. Häufig wurde die Aktfotografie als provokativ wahrgenommen und musste sich mit Fragen von Moral, Ethik und Voyeurismus auseinandersetzen. Doch gerade in dieser Spannung liegt ihre Kraft: Sie fordert den Blick heraus und öffnet Räume für Diskussionen über Körperlichkeit, Geschlecht und Identität.
Im Fokus der klassischen Aktfotografie steht die Betonung von
Licht und Schatten, Formen und Linien. Durch die Lichtführung werden die Konturen des Körpers betont, während gezielt eingesetzte Schatten eine gewisse Intimität und Mystik schaffen. Diese Technik verleiht den Fotografien eine zeitlose Eleganz und hebt die universelle Schönheit des menschlichen Körpers hervor.
In den 1920er Jahren erschlossen reformistische, freiheitliche Bewegungen im deutschsprachigen Raum auch der Aktfotografie neue Themenfelder. Neue Motive fanden Fotograf:innen wie Rudolf und Anna Koppitz oder Lotte Herrlich in der Freikörperkultur, die ebenso wie der Schönheits- und Ausdruckstanz mit einem neuen Körpergefühl und einem anderen Umgang mit Nacktheit experimentierte. Diese Bewegung fand ein Ende im Körperkult der Nationalsozialisten.
Pioniere wie Edward Weston brachten indes innovative Perspektiven ein, die den menschlichen Körper als Landschaft oder abstrakte Form interpretierten. Diese Werke überschreiten die Grenze zwischen Realität und Kunst und laden die Betrachter:innen ein, den Körper jenseits seiner physischen Erscheinung zu betrachten und sich mit Fragen der Identität auseinanderzusetzen.
Cäcilia Steinkellner
Rudolf Koppitz gilt nicht nur als einer der bedeutendsten österreichischen Fotografen der Zwischenkriegszeit, sondern auch als einer der wichtigsten Vertreter der Kunstfotografie im deutschsprachigen Raum. Sein Œuvre umfasst mehrere Jahrzehnte und ist geprägt von einer enormen Bandbreite an Stilen und Techniken.
Koppitz begann seine Karriere als Fotograf im Jahr 1908. In dieser Zeit war die Fotografie hauptsächlich auf die Dokumentation von Realität und Natur beschränkt, doch Koppitz zeigte bereits in seinen frühen Arbeiten eine Vorliebe für das Ästhetische und den Kunstcharakter der Fotografie. Ab den 1910er Jahren experimentierte Koppitz mit verschiedenen fotografischen Techniken und entwickelte seine eigene Bildsprache, die von der Ästhetik des Piktorialismus beeinflusst war. Dabei handelt es sich um einen Stil, der sich durch weiche Konturen, atmosphärische Stimmung und eine gewisse Unschärfe auszeichnet. Koppitz setzte diese Technik in seinen Landschaftsaufnahmen ein und schuf so Bilder von beeindruckender Schönheit und Intensität. In den 1920er Jahren wandte sich Koppitz immer mehr der Aktfotografie zu. Seine Aktstudien sind durch eine besondere Klarheit und Schärfe geprägt. Seine präzisen Kompositionen zeigen Frauen in dynamischen Posen, die Stärke und Schönheit vermitteln.
Parallel zur Aktfotografie beschäftigte sich Koppitz auch mit anderen Genres wie Porträt-, Landschafts- und Architekturfotografie. Dabei blieb er stets auf der Suche nach neuen technischen und künstlerischen Herausforderungen, die er mit großer Leidenschaft und Hingabe meisterte.
In der zweiten Hälfte der 1920er Jahre wandte sich Koppitz immer mehr dem Konstruktivismus und der Neuen Sachlichkeit zu. Diese zeichnen sich durch eine klare Formsprache und eine Reduktion auf das Wesentliche aus. Koppitz’ Bilder aus dieser Periode zeichnen sich durch eine perfekte Beherrschung von Licht und Schatten aus.
Koppitz’ künstlerisches Schaffen endete abrupt mit seinem frühen Tod im Jahr 1936. Dennoch hatte er zu Lebzeiten bereits einen enormen Einfluss auf die Fotografie und beeinflusste zahlreiche Künstler seiner Zeit und auch nachfolgende Generationen von Fotografen. Sein Einfluss auf die Fotografie ist bis heute spürbar und sein Vermächtnis wird auch in Zukunft ein wichtiger Teil der Fotogeschichte bleiben.
Brigitte Henninges 1
1
„Rudolf Koppitz: Photogenie“, Das Fotoportal, https://www.dasfotoportal.de/ rudolf-koppitz-photogenie (aufgerufen 24.2.2025)
• Rudolf Koppitz
geb. 1884 in Schreiberseifen (heute: Krbovice, CZ), gest. 1936 in Perchtoldsdorf (AT)
ohne Titel, um 1923
Pigmentdruck, 28 × 25 cm
Sammlung SpallArt, Inv. Nr. S-35

Lotte Herrlich war eine deutsche Fotografin, die sich in den 1920er Jahren vor allem mit Aufnahmen aus der noch jungen Naturistenbewegung einen Namen machte. Die autodidaktische Fotografin fertigte ihre ersten Aufnahmen nach der Geburt ihres Sohnes, sie bildete sich weiter und fand über Landschaftsaufnahmen und Porträtstudien zur Aktfotografie. Ihre Bilder wurden in Zeitschriften verschiedener Verlage, insbesondere dem Lichtkampf-Verlag und dem Verlag für Schönheit verwendet. Daneben veröffentlichte sie zahlreiche Bücher zum Thema Aktfotografie und Naturismus.1
„[…] und als ich auch in die Geheimnisse der bildmäßigen Landschaftsphotographie eingedrungen war und einige kleine Erfolge zu verzeichnen hatte, wagte ich mich an das Höchste und Schwerste: den Akt. Gleich meine ersten Versuche, die Halbsilhouetten Flötenbläser und Eitelkeit – erwarb Die Schönheit. Weitere folgten und bald war ich in der Lage, drei Sammelmappen mit Akten erscheinen zu lassen und drei Postkartenserien mit Kinderakten […] in erster Linie ist die Gestalt des reifen Menschen in ihrer vielseitigen interessanten Schönheit, die mich zu ernsterer Arbeit anregt […] an Modellen hat es mir dazu nie gefehlt, man brachte mir viel Vertrauen entgegen, und seltsamerweise gerade in gebildeten, vornehmen Kreisen weit mehr als von Seiten der Berufsmodelle, die ich aber auch bald ganz ausschalten konnte […] und wenn es auch nicht immer leicht ist, sich in Stellungen und Beleuchtungen nicht zu wiederholen, besonders, da ich nicht über ein Atelier verfüge, sondern die längste Zeit des Jahres nur auf zwei wenig große Zimmer angewiesen bin, so werde ich doch nicht müde werden,
die liebliche, keusche Anmut des Mädchenkörpers, die kraftvolle, interessante Schönheit des muskolösen Männerkörpers mit Hilfe meiner Kamera darzustellen.“2, schrieb Lotte Herrlich 1921 an Richard A. Giesecke, den Herausgeber der Zeitschrift Die Schönheit
Die Schönheit – mit Bildern geschmückte Zeitschrift für Kunst und Leben war eine deutsche Monatszeitschrift, die ab 1902 im gleichnamigen Verlag der Schönheit erschien. Die Zeitschrift war aufwändig gestaltet, auf Kunstdruckpapier hergestellt und bot die ersten „nacktkulturellen“ fotografischen Abbildungen. Ab 1914 war der Dresdner Verlagsbuchhändler Richard A. Giesecke Herausgeber und verschob die Zeitschrift ins rechte Spektrum der Lebensreformbewegung3. Es erschienen Aufsätze, kurze Essays, Novellen, Erzählungen und Gedichte, dazwischen zahlreiche fotografische Aktaufnahmen. Aus Furcht vor beruflichen Nachteilen, nutzten auffällig viele Autor:innen und Fotograf:innen ein Pseudonym. So veröffentlichte zum Beispiel der Fotograf Franz Fiedler mit dem Pseudonym F. Relief.
Mit Themen wie Körperhygiene, Leibesertüchtigung und Nacktheit erschienen Abhandlungen zu einstigen und zeitgenössischen Schönheitskulturen, politische oder wirtschaftliche Fragen blieben dagegen unberücksichtigt. Die Themen Jugend, Kunst und Literatur zeigten jedoch erste rassenhygienische Ansichten zu Nacktheit und Schönheit, aus denen sich perfekte Körper ergaben. So erschien eine der letzten Ausgaben 1932 mit dem Aufmacher „Gesunde Frau –gesundes Volk!“4
Christoph Fuchs
1 vgl. dazu wikipedia, Lotte Herrlich (https://de.wikipedia.org/wiki/ Lotte_Herrlich, aufgerufen 4.10.2024)
2 FKK Museum, online (https://www.michis-seiten.de/seite080.html, aufgerufen 4.10.2024)
3 Mit Lebensreform werden verschiedene soziale Reformbewegungen bezeichnet, die seit Mitte des 19. Jahrhunderts insbesondere von Deutschland und der Schweiz ausgingen.
4 vgl. dazu wikipedia, Die Schönheit (https://de.wikipedia.org/wiki/ Die_Sch%C3%B6nheit, aufgerufen 4.10.2024)
• Lotte Herrlich
geb. 1883 in Chemnitz (DE), gest. 1956 in Eutin (DE)
ohne Titel, 1920er
Gelatinesilberabzug, getont auf Karton, 16,3 × 9 cm
Sammlung SpallArt, Inv. Nr. S-2786



Der berühmte Pariser Fotograf Laryew (Stanislas Walery) war vor allem für seine gewagten Studien der Mädchen der Folies Bergère1 sowie für seine Porträts der High Society bekannt. Unter dem Anagramm Laryew veröffentlichte Walery 1923 eine Mappe mit hundert Aktstudien, die heute als Meisterwerke der Art-déco-Fotografie gelten. Walerys richtiger Name war Stanislaw Julian Ignacy, Graf Ostroróg. Das Fotostudio von Walery wurde von seinem Vater gegründet, der zwar in Litauen geboren wurde, aber in Wirklichkeit Pole war. Walery senior wurde 1862 britischer Staatsbürger und begann als Fotograf in Marseille und Paris, bevor er in London ein erfolgreiches Studio eröffnete, zunächst in der Conduit Street, dann in der Regent Street. Der Sohn übernahm das Geschäft 1890 und ging bis 1900 eine Partnerschaft mit Alfred Ellis ein, bevor er nach Paris zog.
Im Jahr 2005 zeigte die National Portrait Gallery in London eine Ausstellung mit Werken von Walery, Vater und Sohn, unter dem Titel Victorian Women. Alle Porträtierten waren streng korsettiert und höchst respektabel, ganz im Gegensatz zu unseren gewagten Art-déco-Schönheiten.
Neil Philip 2 1 Varietetheater in Paris, zwischen 1890 und Mitte der 1930er Jahre sehr populär 2 www.idburyprints.com (aufgerufen 2015, nicht mehr verfügbar)
• Laryew (Stanislas Walery) geb. 1863 in Litauen, gest. 1935 in Paris (FR)
aus der Mappe „NUS“, 1923 100 Heliogravüren, je 32 × 25 cm Sammlung SpallArt, Inv. Nr. S-198


• Trude Fleischmann
geb. 1895 in Wien (AT), gest. 1990 in Brewster (US)
„Maria de las Nieves“, 1929
Sammlung Simak, © Trude Fleischmann Nachlass
Adolf Katscher lässt sein Modell eine gängige Haltung für Aktaufnahmen in der Zeit einnehmen, verwendet aber kein diffuses Licht, wie etwa Trude Fleischmann, sondern betont durch den Schatten die Silhouette der Brust und des Kopfes.
Fritz Simak
Adolf Katscher wurde im mährischen Olmütz, im heutigen Tschechien geboren und war in den 1920er und 1930er Jahren als Amateurfotograf in Wien tätig. Seine Arbeiten zeichnen sich durch klare Bildkompositionen und ein feines Gespür für Licht und Schatten aus. Während des Zweiten Weltkriegs wurde der jüdische Adolf Katscher über Theresienstadt in das Konzentrationslager Lublin-Majdanek deportiert. Dort wurde er von den Nationalsozialisten ermordet. Nach dem Zweiten Weltkrieg geriet Katscher weitgehend in Vergessenheit. Es sind nur noch einige wenige Portät- und Aktaufnahmen bekannt. Seine tragische Lebensgeschichte spiegelt die Schicksale vieler jüdischer Künstler:innen und Intellektueller seiner Zeit wider.
Christoph Fuchs
•
Adolf Katscher
geb. 1881 in Olmütz (heute Olomouc, CZ), gest. 1942 in Lublin-Majdanek (PL)
„Akt“, um 1930
Bromöldruck auf Karton, 27 × 19 cm
Sammlung SpallArt, Inv. Nr. S-595

Der Rückenakt zeigt eine junge, schöne Frau, die offensichtlich leidend und in sich gekehrt vor einem Brandopfertisch auf ihr Ende wartet. Der bereits aufziehende Rauch der Opfergabe und der Titel Abendopfer zeichnen eine Parallele zu den Abendopfern im Tempel in Jerusalem, wo täglich am Morgen und Abend ein Brandopfer dargebracht wurde (Ex 29,38–42; Num 28,3–8). Fiedler zwingt uns damit eine eindeutig moralische Interpretation auf und ordnet sich mit seiner Komposition dem vorherschenden Symbolismus in der Kunstgeschichte zu.
„Das Motiv des Todes und der Jungfrau ist wohl eines der beliebtesten in der bildenden Kunst. Angefangen bei Werken der Renaissance, etwa von Hans Baldung Grien, über Werke von Egon Schiele und Musikstücke aus dem 19. Jahrhundert bis hin zu Werken der zeitgenössischen Kunst in Theater und Literatur, erscheint der Tod als Verführer und Liebhaber junger Frauen und erinnert sie auf groteske Weise an die Endlichkeit und Vergänglichkeit von Jugend, Schönheit und Leben. Die Bedrohlichkeit des Motivs ist der Ausgangspunkt für jene Darstellungsformeln, die vor allem mit moralischen Aspekten verbunden sind.“1
Franz Fiedler, als Schüler des bekannten deutschen Porträtfotografen Hugo Erfurth, beschäftigte sich unter anderem selbst
ein Leben lang mit dem fotografischen Porträt. Er veröffentlichte zahlreiche Lehrbücher über Bildkomposition und Lichtsetzung in der Porträtfotografie.
Franz Fiedler war zur Zeit der Entstehung der Aufnahme auch als Vertreter der künstlerischen Fotografie zur I. Internationale kunstphotographische Ausstellung in Wien 1929 geladen. Diese wichtige Fotoausstellung der Amateurfotografen zeigt die Bedeutung Fiedlers in der Szene im deutschsprachigen Raum. „Der Verband österreichischer Amateurphotagraphenvereine erachtet es nun als seine Pflicht, in der Bundeshauptstadt eine große Schau der Leistungen seiner Vereine und ihrer Mitglieder zu bringen und der Öffentlichkeit von seinen Zielen, Arbeiten und Erfolgen Kenntnis zu geben. Ist es doch sein Bestreben, vor allem die künstlerische Seite der Photographie zu fördern und so den guten Ruf der österreichischen Lichtbildkunst zu mehren.“2
Fiedlers Bildkompositionen und die symbolische Beladung des Bildes sowie die Tatsache, dass er sich in den 1920er Jahren in Wien aufgehalten haben muss, lassen den Schluss zu, dass er auch Kontakt zur Bewegung der Wiener Sezession hatte.
Christoph Fuchs
1 SKD, The Daulton Collection, Los Altos Hills, California (US), http://www.symbolismus.com/ franzfiedler.html
2
‚VI. Internationale Jubiläums-Ausstellung. Wien‘, Vorwort, Österreichisches Museum für angewandte Kunst/Gegenwartskunst, Wien, 1953.
• Franz Fiedler
geb. 1885 in Proßnitz (heute: Prostějov, CZ), gest. 1956 in Dresden (DE)
„Abendopfer“, 1920er
Gelatinesilberabzug, 28 × 22 cm
Sammlung SpallArt, Inv. Nr. S-18, © Franz Fiedler Nachlass

Charlotte Rohrbach fotografierte für Reportagen, unter anderem entstanden 1934 erste Modefotografien für die Zeitschrift Die Dame Berühmt wurde sie für ihre Aufnahmen der Werke des Architekten und Bildhauers Arno Breker. Er galt als einer der prominentesten Künstler des nationalsozialistischen Deutschen Reichs. Nach Adolf Hitlers Meinung gehörten seine Plastiken „wohl zum Schönsten, was in Deutschland je geschaffen wurde“1. Rohrbach verband mit Breker eine lebenslange Künstlerfreundschaft. Diese begann Anfang der 1930er Jahre, als der junge Breker von Paris nach Berlin übersiedelte.
Die Bilder der deutschen Fotografin wurden in Zeitschriften wie Die Kunst im Dritten Reich und in Büchern veröffentlicht. Charlotte Rohrbach hat es wie kaum eine andere Fotografin ihrer Zeit verstanden, in der Schwarz-Weiß-Fotografie neue Maßstäbe zu setzen. Sie wurde als Fotografin oft mit der Regisseurin Leni Riefenstahl verglichen. Rohrbach konnte mit ihrer zurückhaltenden Art jedoch keine ähnlich offizielle Rolle in der NS-Zeit einnehmen, wie ihre berühmte Kollegin. 1942 beteiligte sie sich an der SS-Hetzschrift
Der Untermensch. 2
Christoph Fuchs
1
„Bauten der neuen Zeit“ in: Alpenländische Rundschau. Unpolitische Wochenschrift für die gesamten Alpenländer/ Alpenländische Rundschau, 24. Dezember 1938, S. 8
2
vgl. dazu wikipedia, Charlotte Rohrbach (https://de.wikipedia. org/wiki/Charlotte_Rohrbach, aufgerufen 4.10.2024)
Die Skulptur „Der Verwundete“ aus dem Jahr 1938 von Arno Breker war als eine der vier männlichen Figuren gedacht, die eine monumentale Skulptur von Apollo mit seiner Quadriga umgeben sollten. Die Skulpturengruppe wurde nie verwirklicht. Sie sollte den Hauptkreisel des neuen nationalsozialistischen Berlin schmücken, der vom Architekt Albert Speer errichtet werden sollte.
Das komplexe, ikonographische Programm sollte den Beginn einer neuen nationalsozialistischen Ära verherrlichen. In dem 1942 von Charles Despiau anlässlich der Einzelausstellung von Arno Breker in der Orangerie des Tuileries in Paris veröffentlichten Buch trägt die Skulptur den Titel Le guerrier blessé (Der verwundete Krieger). Am muskulösen Körper des Verwundeten sind keine Verletzungen zu sehen. Lediglich das Vorhandensein eines Stirnbandes deutet auf eine körperliche oder höchstwahrscheinlich psychische Verletzung hin.
Die Skulptur könnte als Allegorie auf das Streben Deutschlands nach Wiedererlangung seiner Macht nach der Niederlage und Demütigung des Ersten Weltkriegs gelesen werden.
Obwohl Arno Breker den Verwundeten auf Befehl für ein öffentliches und allegorisches Denkmal konzipierte, gab er der Skulptur dennoch eine spezifische Identität und führte anekdotische Elemente in sein Projekt ein. Auch wenn der Gesichtsausdruck des Verwundeten für den Betrachter nicht sichtbar war, gab Arno Breker der Skulptur das Gesicht des französischen Radfahrers
André Leducq, das einige Jahre zuvor in den französischen Zeitungen veröffentlicht wurde.
Einige Jahre später goss er sogar eine separate Skulptur als Porträt: Der Kopf des Verwundeten. Der Kopf des Verwundeten fungiert als autonomes Porträt von Leducq, mit dem Arno Breker einem Mann huldigt, mit dem er bis mindestens Ende der 1960er Jahre in Kontakt blieb, wie Archivdokumente belegen.
Simon Delobel, Sammlung Hugo Voeten
Charlotte Rohrbach geb. 1902 in Malschöwen in Ostpreußen (heute Małszewo, PL), gest. 1981 in Pöcking (DE)
„Der Verwundete“, 1943
Skulptur von Arno Breker (1900–1991), 1938
Gelatinesilberabzug, 14 × 10 cm
Sammlung SpallArt, Inv. Nr. S-2787, © Charlotte Rohrbach Nachlass

1 https://www.getty.edu/art/collection/person/103KGV (aufgerufen 24.2.2025), übersetzt mit deepL
Die Familie von Albert Rudomine zog von Russland nach Paris und dann nach New York, wo er hebräische Theologie studierte. Im Jahr 1917 kehrte er nach Paris zurück und wurde Schneider. Innerhalb weniger Jahre begann er Tänzer zu fotografieren und arbeitete bald als Fotojournalist. 1923 gründete er sein eigenes Studio und spezialisierte sich auf Porträtfotografie und Akte.
Während des Zweiten Weltkriegs arbeitete Rudomine für die französischen Nationalmuseen. Im Musée Auguste Rodin fotografierte er die Werke des berühmten Bildhauers, die er 1950 veröffentlichte. Rudomine druckte auch eine Mappe mit Bildern von frühen Negativen verschiedener Hersteller ab, wobei er Fotopapiere verwendete, die zeitgleich mit den Negativen entstanden waren.
Getty Museum, Los Angeles1
• Albert Rudomine geb. 1892 in Kyjiw (UA), gest. 1975 in Paris (FR)
ohne Titel, 1920er
Gelatinesilberabzug, 28 × 22 cm
Sammlung SpallArt, Inv. Nr. S-271, © Albert Rudomine Estate

• Stephan Lupino
geb. 1952 in Varaždin (HR), lebt und arbeitet in New York (US) und Zagreb (HR)
„Desmond’s Back“, 1989 (Abzug 1996)
Gelatinesilberabzug, getont, 47 × 32 cm
Sammlung SpallArt, Inv. Nr. S-1500, © Stephan Lupino

Die österreichisch-amerikanische Fotografin Trude Fleischmann ist vor allem für ihre Porträtaufnahmen von namhaften Persönlichkeiten im Wien der 1920er und 1930er Jahre bekannt. Für Aufsehen sorgten ihre Bewegungsstudien von, zum Teil nackten, Tänzerinnen.
Sie zählte zu den ersten Fotografinnen, die sich dem Frauenakt widmeten. Sich als Frau künstlerisch mit Nacktheit zu beschäftigen, galt zu dieser Zeit mancherorts noch als unschicklich.
Aufgrund ihrer jüdischen Herkunft musste sie 1938 in die usa emigrieren, wo sie ab 1940 in New York wieder bekannte Künstler:innen und Intellektuelle fotografierte.
Die Kostüm-Studie der berühmten Tänzerin und Schauspielerin Tilly Losch (1903–1975) besticht durch die eigenwillige Körperhaltung, die ihre Entsprechung im entspannt melancholischem Gesichtsausdruck findet.
Christoph Fuchs
• Trude Fleischmann
geb. 1895 in Wien (AT), gest. 1990 in Brewster (US)
„Kostüm-Studie“, um 1929
Gelatinesilberabzug, 22 × 9 cm
Sammlung SpallArt, Inv. Nr. S-578, © Trude Fleischmann Nachlass

• Miroslav Hák
geb. 1911 in Nová Paka (CZ), gest. 1978 in Prag (CZ)
ohne Titel, 1944 (Abzug 1970er)
aus dem Portfolio „akt. v ceské fotografii“, Nr. 9
Gelatinesilberabzug, 17 × 12 cm
Sammlung SpallArt, Inv. Nr. S-1497, © Miroslav Hák Estate

Wie ich mit meinen Modellen arbeite ... Wir verbringen Zeit miteinander, kennen uns, von Familie zu Familie, seit Jahren. Wir sind Freunde. Und ab und zu machen wir auch Bilder zusammen ... Nach dem Einfühlungsvermögen glaube ich, dass es keinen wichtigeren Aspekt des Charakters eines Fotokünstlers gibt als Bescheidenheit. Unsere besten Bilder entstehen so oft durch Zufall. Wir sind völlig abhängig von dem, was außerhalb von uns, in der Welt, für unsere Kunst ist. Ohne ein Motiv, ohne Modelle sind wir nichts, und so betrachte ich mich in meiner eigenen Mathematik nie wichtiger als die Menschen, die ich fotografiere. Ohne sie existiere ich nicht. Nein.
Jock Sturges
1 Diane Broncaccio, „Photographer facing statutory rape charges“, Greenfield Recorder, 12.5.2017, (https://www.recorder.com/Photographer-arraignedon-statuatory-rape-charges-9866341, aufgerufen 28.1.2025)
Die Aufnahme entstand, wie viele Bilder des amerikanischen Fotografen Jock Sturges, am Nacktbadestrand von Montalivet an der französischen Atlantikküste. Sturges sieht seine Bilder nicht als sinnlich, erotisch oder gar pornografisch; sie sollen im Gegenteil in erster Linie die Schönheit, Unschuld, Jugend und Natürlichkeit thematisieren.
Seine Arbeiten waren jedoch immer wieder Gegenstand von Kontroversen, da sie Nacktheit insbesondere von Minderjährigen zeigen. Einige Kritiker werfen ihm vor, die Grenzen zwischen Kunst und Ausbeutung zu überschreiten. Die Bilder sind jedoch legal erstellt worden, seine Modelle (sowie deren Eltern) haben aktiv an seinen Projekten teilgenommen und sind oftmals Teil der Naturalisten Gemeinschaften an den Orten der Aufnahmen.
Im Jahr 1990 wurde Sturges Studio in San Francisco wegen Vorwürfen der Kinderpornografie vom FBI durchsucht und dabei seine Bilder und Ausrüstung beschlagnahmt. Sein erstes Buch The Last Day of Summer (1991) und das Buch Radiant Identities (1994) sollten einige Jahre später 1998 ebenfalls als kinderpornografisch eingestuft werden. Alle Vorwürfe konnten jedoch nicht aufrechterhalten werden. Dennoch bekannte sich Sturges im Jahr 2021 vor einem Gericht in Franklin County (US) der widernatürlichen und lasziven Handlungen mit einem Kind unter 16 Jahren schuldig, als er Mitte der 1970er Jahre Leiter eines Schlafsaals an der Northfield Mount Hermon School war. Er wurde zu drei Jahren auf Bewährung verurteilt.1
Christoph Fuchs
• Jock Sturges
geb. 1947 in New York (US), lebt und arbeitet in Seattle (US)
„Vanessa, Montalivet France“, 1998 Gelatinesilberabzug, 37 × 47 cm
Sammlung SpallArt, Inv. Nr. S-16, © Jock Sturges

Edward Weston verließ Mexiko im November 1926 in Richtung
Kalifornien und kehrte nicht mehr zurück, obwohl er dies gehofft hatte. Er zog zurück nach Glendale in Kalifornien und richtete sein altes Studio ein, blieb aber von seiner ersten Frau Flora (1879–1965) getrennt. Im Februar 1927 meldete sich die Tänzerin Bertha Wardell (1896–1974) enthusiastisch als sein Modell, nachdem sie eine Ausstellung von Westons Bildern an der Universität von Kalifornien in Los Angeles gesehen hatte. Sie wurde seine Geliebte und posierte nackt für ihn im Studio. Im Laufe mehrerer Sitzungen nahm Weston eine Reihe von Bildern von Wardell beim Tanzen auf. Über einen dieser Besuche schrieb er in sein Tagebuch: „Ihre Schönheit in der Bewegung ist ein exquisiter Anblick. Tanzen sollte immer nackt sein!“ Obwohl die Fotografien von ihren Bewegungen inspiriert waren, handelte es sich nicht um echte Action-Aufnahmen, denn das Licht in Westons Studio erforderte eine Belichtungszeit von
mehreren Sekunden. Wenn Weston eine Bewegung sah, die er festhalten wollte, forderte er Wardell auf, ihre Pose zu halten, während er das Bild aufnahm.
Wie schon bei seinen Aktstudien von Tina Modotti (1896–1942) in Mexiko füllte Weston den Rahmen mit Ausschnitten von Wardells Körper, isolierte sie vor einem schlichten Hintergrund und hielt ihre gleichzeitige Stärke und Eleganz fest. Da ihre Identität in diesen gesichtslosen Darstellungen jedoch verschleiert ist, wird Wardell zu einem eher neutralen Gegenstand für Westons Studie der menschlichen Form. Die dunklen Linien, die die Konturen ihres Körpers betonen, wurden nicht, wie einige von Westons Zeitgenossen meinten, mit dem Bleistift auf das Negativ geschrieben, sondern waren dünne Schatten, die durch geschickte Beleuchtung erzeugt wurden.
Brett Abbott 1
1 aus: ‚Edward
• Edward Weston geb. 1886 in Highland Park (US), gest. 1958 in Carmel (US)
„Nude“, 1927 (Abzug 1980er von Cole Weston) Gelatinesilberabzug auf Karton, 17 × 23 cm
Sammlung SpallArt, Inv. Nr. S-430, © Arizona Board of Regents, Center for Creative Photography


• Edward Weston
geb. 1886 in Highland Park (US), gest. 1958 in Carmel (US)
„Nude“, 1934 (Abzug 1970er von Cole Weston)
Gelatinesilberabzug auf Karton, 9 × 11 cm
Sammlung SpallArt, Inv. Nr. S-321, © Arizona Board of Regents, Center for Creative Photography

• Edward Weston
geb. 1886 in Highland Park (US), gest. 1958 in Carmel (US)
„Nude“, 1934 (Abzug 1970er von Cole Weston)
Gelatinesilberabzug auf Karton, 8 × 11 cm
Sammlung SpallArt, Inv. Nr. S-322, © Arizona Board of Regents, Center for Creative Photography
1934 lernte Weston Charis Wilson kennen, die gut ausgebildete, zwanzigjährige Tochter einer prominenten Familie aus Carmel. Sie diente dem Fotografen zunächst als Modell für seine Aktstudien, doch schon bald entwickelte sich eine romantische Beziehung zwischen den beiden. Im Gegensatz zu vielen seiner früheren Modell-Geliebten blieb Wilson fast zwölf Jahre mit Weston zusammen und sie waren von 1939 bis 1945 verheiratet. Sie war erst seine zweite Frau, obwohl er während und nach seiner ersten Ehe mit Flora Chandler zahlreiche Geliebte hatte. Westons Bilder von Wilson aus dem Jahr 1934 waren, wie seine Hände von Kreutzberg, Nahaufnahmen von Körperteilen. Vor einem tiefschwarzen Hintergrund, wie es bei den Stillleben mit Paprika und Muscheln oft der Fall war, sind Wilsons Arme und Schienbeine oder Gesäß und Füße eng umrahmt, oft aus der Mitte gerückt und aus dem Kontext ihres Körpers als Ganzes herausgelöst.

• „Hände von Kreutzberg“, 1932
1
Nicht lange nachdem Weston Wilson kennengelernt hatte, packte er sein Atelier in Carmel ein und zog in die 46 Mesa Road im Santa Monica Canyon, um mit Brett zusammenzuleben. Die Jahre der Depression waren schwierig gewesen, und Weston glaubte wohl, dass er im Los Angeles County bessere Verdienstmöglichkeiten haben würde als in der Gegend von Carmel, die stark vom Tourismus abhängig war. Wilson zog noch im selben Sommer hierher, gefolgt von Westons Söhnen Neil und Cole. Das Haus mit zwei Schlafzimmern, in dem alle fünf wohnten, verfügte neben dem Hauptschlafzimmer über eine geräumige Sonnenterrasse, auf der Weston Wilson fotografierte, so wie er Tina Modotti auf ihrem Dach in Mexiko fotografiert hatte. Das Foto, auf dem Wilson in eleganter Pose auf einer Wolldecke sitzt, das Gesicht nach unten gedreht, um das helle Sonnenlicht zu meiden, wurde dort aufgenommen, direkt in der Türöffnung.
Brett Abbott1
• Edward Weston geb. 1886 in Highland Park (US), gest. 1958 in Carmel (US)
„Nude, Charis Wilson“, 1936 (Abzug 1970er von Cole Weston) Gelatinesilberabzug auf Karton, 24 × 19 cm Sammlung SpallArt, Inv. Nr. S-432, © Arizona Board of Regents, Center for Creative Photography


•
„Ritorto“, 2017
Gelatinesilberabzug, 25,4 × 20,3 cm
Sammlung SpallArt, Inv. Nr. S-2871, © Kim Weston
Kim Weston lernte das Handwerk des Fotografen, als er seinem Vater Cole Weston in der Dunkelkammer bei der Herstellung von Galerieabzügen von den Originalnegativen seines Großvaters Edward Weston assistierte. Kim arbeitete auch viele Jahre lang als Assistent seines Onkels Brett Weston.
Im Gegensatz zu seinen Vorfahren fotografiert Kim Weston fast ausschließlich Aktstudien im Studio. Seine Fotografien entstehen in inszenierten Welten. „Mein Vater (Cole Weston) war der Meinung, es sei zu intellektuell und ich solle keine Sachen arrangieren. Darüber habe ich mit ihm gestritten. Welches sind die berühmtesten Bilder von Edward Weston? Die Paprikaschoten, die Muscheln, alle Aktbilder sind arrangiert. Das sind völlig legitime fotografische Motive. Das gilt auch für Landschaften, in Schwarzweiß oder in Farbe. Es ist egal, was man macht, solange man ein inneres Bedürfnis befriedigt, und für mich ist das Bedürfnis eher der Prozess als das fertige Produkt. Meine Fotografien sind Geschichten des Prozesses.“1
Die Pose erinnert an Aktstudien von Edward Weston.
Christoph Fuchs
• Kim Weston
geb. 1953 in Monterey (US), lebt und arbeitet in Carmel (US)
„Abstract Nude“, 2011
Gelatinesilberabzug, 25,4 × 20,3 cm
Sammlung SpallArt, Inv. Nr. S-2872, © Kim Weston

• Werner Schnelle
geb. 1942 in Wien (AT), lebt und arbeitet in Salzburg (AT)
„Rückenakt 1“, 1995
Gelatinesilberabzug, 0 × 0 cm
Sammlung SpallArt, Inv. Nr. S-2805, © Schnelle Photographie

Des instants, sans cesse
Des moments, oubliés
Des sourires, des soleils
Des fruits posés là…
Et Elle
Qui passe,
Comme le vent
Comme la vie
Juste un centième de seconde
L’éternité
Par peur de mourir
Ou d’oublier
Par peur de ne pas être sûre…
Besoin de posséder le temps
Ces instants, comme des papillons
Emprisonnés dans leur vitrine
Objets du souvenir
Pièces à conviction
Sabrina Biancuzzi
Die Serie She ist eine endlose Sammlung von Momenten des Lebens ... wenn wir Briefmarken oder Postkarten sammeln, wird das Objekt der Erinnerung selbst gesammelt, um nach und nach ein Spiegelbild eines vergangenen Lebens, eines Traums oder der Wirklichkeit zu erhalten. In dieser Serie ist es die Schönheit des Vergänglichen, die Angst vor dem Verschwinden und das Schöpfen aus dem Nichts, die die Serie bestimmen. Die analog ausgearbeiteten Fotografien auf Barytpapier werden in einem weiteren Schritt bearbeitet und übermalt. Jedes Bild ist so eine einzigartige Arbeit, eine einzigartige Erinnerung.
Christoph Fuchs
Sabrina Biancuzzi
geb. 1978 in Tournai (BE), lebt und arbeitet in Paris (FR)
ohne Titel, 2010–2017 aus der Serie „She“
Gelatinesilberabzug (analog) auf Baryt, mixed Media, 8,5 × 13 cm
Sammlung SpallArt, Inv. Nr. S-2077, © Sabrina Biancuzzi


•
„Zebra Nude, New York“, 1997
Die Aufnahme entstand in White Sands in New Mexico, einem Naturschutzgebiet in der Chihuahua-Wüste, wo der französische Fotograf Lucien Clergue Anfang der 1980er Jahre zum ersten Mal fotografierte. Mit Sicherheit hat ihn der weiße Sand als Kulisse für seine Bilder fasziniert, einige Male hat Clergue diesen Ort besucht. Die weißen Sanddünen boten die perfekte Kulisse, um mit Texturen, Schatten und der menschlichen Figur zu spielen, ähnlich wie in seinen früheren Arbeiten aus der Camargue in seiner Heimat. Die Verbindung von Körper und Landschaft, die in seinen Fotografien oft zu sehen ist, kommt hier besonders zur Geltung. Bekannt ist eine Serie an farbigen Aktaufnahmen mit weißem Sand und blauem Himmel, die ebenfalls in White Sands entstanden ist.
Mit der markanten Schattenstruktur des Wüstengewächs nimmt Clergue in dieser Aufnahme etwas vorweg, was er erst ab 1997 gezielt in seinen Zebra Nudes einsetzt.
Christoph Fuchs
• Lucien Clergue
geb. 1934 in Arles (FR), gest. 2014 in Nimes (FR)
„Nude at White Sands“, 1988
Gelatinesilberabzug, 36 × 25 cm
Sammlung SpallArt, Inv. Nr. S-298, © Atelier Lucien Clergue

Die Verbindung von Körper und Natur ist eines der ältesten und kraftvollsten Motive in der Fotografie. Wenn der menschliche Körper in natürlichen Landschaften dargestellt wird, entsteht ein intensives Wechselspiel zwischen Mensch und Umwelt. Dabei wird der Körper nicht nur als physisches Subjekt betrachtet, sondern auch als Symbol für Verbundenheit und Verletzlichkeit.
In vielen Fotografien verschmilzt der Körper nahezu mit der Umgebung. Diese Inszenierungen betonen die Einheit zwischen Mensch und Natur und erinnern daran, dass wir Teil eines größeren Ganzen sind. Gleichzeitig wird der Körper durch die Kontraste hervorgehoben – weich und verletzlich gegen hartes Gestein, geschmeidig gegen die raue Struktur von Erde oder Rinde.
Historisch diente der Körper in der Natur oft als Symbol für Ursprünglichkeit und Freiheit. Die Aktfotografie in der freien Natur,
wie sie im frühen 20. Jahrhundert von Künstlerinnen und Künstlern wie Edward Weston praktiziert wurde, betonte die Harmonie zwischen Mensch und Landschaft. Zeitgenössische Fotograf:innen greifen dieses Motiv auf und erweitern es, um Themen wie Umweltzerstörung, Identität oder die Isolation des modernen Menschen in einer bedrohten Natur zu reflektieren.
Körperfotografie in der Natur thematisiert auch den Raum zwischen Mensch und Umwelt. Der Körper wird zum Fremdkörper, wenn er in unwirtliche oder überwältigende Landschaften gesetzt wird, aber auch zur Erweiterung der Natur, wenn er organisch in diese eingebettet ist.
Cäcilia Steinkellner

• „An der Adria (Selbstporträt)“, 1923
Das Bild entstand als eine der ersten Aktaufnahmen des bereits vierzigjährigen Rudolf Koppitz auf der Hochzeitsreise mit seiner Frau Anna Koppitz im Jahr 1923 an der italienischen Adria bei Venedig. „Die beiden fotografierten einander nackt, auf Felsen im Meer hingestreckt. Die Haltung, die alles andere als natürlich oder bequem erscheint, ist weniger innige Liebesbekundung, denn mühsam erarbeitete Kunstfotografie. Statt Nähe und Zuneigung zueinander bildlich darzustellen, wie man es auf einer Hochzeitsreise erwarten würde, entschied sich das Paar für eine anonymisierte Pose, in der man sie weder gemeinsam noch intim oder erotisch aufgeladen erlebt.“1
Anna Koppitz wurde 1895 als Anna Arbeitlang in Österreich oder Deutschland geboren. Wie Rudolf studierte sie Fotografie an der vom Fotochemiker Josef Maria Eder gegründeten Graphischen Lehrund Versuchsanstalt in Wien, wo sie 1917 Assistentin wurde. Rudolf war bereits 1913 zum Assistenten ernannt worden, bevor er in den Krieg eingezogen wurde und als Feld- und Luftbildfotograf diente. 1920 gründete Anna ein Atelier im fünften Wiener Gemeindebezirk, in dem Rudolf Koppitz ab 1921 Teilhaber war. Die beiden heirateten im Sommer 1923 und das Atelier firmierte nur mehr unter seinem Namen. Sie arbeiteten gemeinsam an künstlerischen Aufträgen, Publikationen und Projekten. Anna war auch Rudolfs Assistentin bei dessen künstlerischen Arbeiten, seine Fotoretuscheurin und arbeitete mit ihm an seinen ersten Aktstudien, einigen seiner Selbstporträts, und stand ihm oft Modell. Sie dürfte einen wesentlichen Einfluss darauf gehabt haben, dass ihr Mann sich der Aktfotografie widmete und sogar vor nackten Selbstporträts nicht zurückschreckte.
Christoph Fuchs
• Rudolf Koppitz
geb. 1884 in Schreiberseifen (heute: Krbovice, CZ), gest. 1936 in Perchtoldsdorf (AT)
Akt am Meer, 1923
Pigmentdruck, 22 × 38 cm
Sammlung SpallArt, Inv. Nr. S-22


• „Der getreue Eckart“, Seite 352–353, 1924
Zeitschrift hergestellt im Lichtdruckverfahren (Heliogravur)
Sammlung SpallArt, Inv. Nr. S-320
1 zu Anna Koppitz siehe den Text auf Seite 48
2
Anmerkungen zum Bild in: „Der getreue Eckart. Halbmonatsschrift für das deutsche Haus“, 2. Jg, S. 353
3
Magdalena Vukovic, ‚Die Kunst des Körpers‘, in: Monika Faber (Hg.), „Rudolf Koppitz. Photogenie. 1884–1936“, Wien 2013, S. 34
Das Selbstporträt Im Schoß der Natur ist wohl eines der bekanntesten Bilder von Rudolf Koppitz. Die Aufnahme entstand in der Natur im Toten Gebirge in Oberösterreich, vermutlich mit Hilfe seiner Frau Anna1. Das symbolträchtige Bild spiegelt neben seiner Begeisterung für die Natur auch seine Sicht eines perfekten Körpers wider. „Aufnahme im Sonnenlicht mit Gelbscheibe. Dadurch gute Durchzeichnung und Plastik des prachtvollen Männeraktes und dennoch zugleich richtige Luftperspektive und Wiedergabe des fernen Dachsteinmassivs.“2 Die Kunsthistorikerin und KoppitzExpertin Magdalena Vukovic schreibt in ihrem Essay zur Beziehung Koppitz und dem Körper folgendes: „Das Bild ist von pathetischer Melancholie, Selbstverliebtheit und Anti-Urbanismus geprägt.
Während der gekrümmte Körper mit dem gebeugten Kopf und dem verbogenen Gesicht Erinnerungen an eine embryonale Haltung vermittelt und somit direkt auf den Titel verweist, lässt der Blick auf das muskulöse Gesäß und die vom Wandern wohlgeformmten Waden eine nicht nur passive Naturverbundenheit vermuten.“3
Wie viele der in den 1920er Jahren tätigen Fotografinnen und Fotografen veröffentlichte Rudolf Koppitz seine Kunstfotografien in Monatszeitschriften um ein breiteres Publikum zu erreichen. So zum Beispiel in der Halbmonatszeitschrift „Der getreue Eckart“ im Jahr 1924.
„Der getreue Eckart“ war eine österreichische Zeitschrift, erschienen von 1923 bis 1955. Sie verstand sich als Zeitschrift für deutsche Kultur und wurde in der Zeit des Nationalsozialismus von Bruno Brehm im Adolf Luser Verlag herausgegeben. Auch die nachfolgenden Zeitschriften „Eckartbote“, „Der neue Eckartbote“ und „Der Eckart“ sind mit deutsch-nationalen Inhalten dem rechtskonservativen Lager zuzuordnen.
Christoph Fuchs
• Rudolf Koppitz
geb. 1884 in Schreiberseifen (heute: Krbovice, CZ), gest. 1936 in Perchtoldsdorf (AT)
„Im Schoß der Natur“, 1923

1 Cole Weston in conversion with John Paul Caponigro, 2000, https://www.johnpaulcaponigro.com/blog/photographer-convos/ cole-weston/ (aufgerufen 18.2.2025)
Cole Weston ist der jüngste der vier Söhne von Edward Weston. Er spielte eine wichtige Rolle bei der Erhaltung und Verbreitung des fotografischen Erbes seines Vaters. Ab 1946 fertigte Cole Abzüge für seinen an Parkinson erkrankten Vater. Daneben entwickelte er seinen ganz eigenen fotografischen Stil, insbesondere seit 1957 mit seiner ersten Farbaufnahme von Big Sur. Die Filmproduktionsfirma Eastman Kodak sandte ihre neuen Farbfilme Kodachrome und Ektachrome an Edward Weston, weil sie wollten, dass er „Point Lobos in Farbe fotografiert“.1 Cole nutzte die Gelegenheit und begann mit den damals neuartigen Farbfilmen zu experimentieren.
Obwohl Cole Weston nie so berühmt wurde wie sein Vater oder sein älterer Bruder Brett Weston, sind seine Landschafts- und Aktfotografien hoch angesehen. Seine Werke zeichnen sich durch intensive Farben und eine sorgfältige Komposition aus. Viele seiner Bilder zeigen die kalifornische Küste, insbesondere die Region um Big Sur, wo er lebte und arbeitete.
Diese Arbeit stammt noch aus der Zeit vor der Farbfotografie, entstand aber mit Sicherheit auch an der Küste der wunderbaren Naturlandschaft bei Point Lobos, unweit des Zuhause der Familie Weston im kalifornischen Carmel.
Christoph Fuchs
• Cole Weston geb. 1919 in Los Angeles (US), gest. 2003 in Carmel (US)
ohne Titel, 1954
Gelatinesilberabzug auf Karton, 24 × 19 cm
Sammlung SpallArt, Inv. Nr. S-193, © Cole Weston Estate

1 Charis Wilson, in: „Edward Weston Nudes“, New York, 1977, n. p., übersetzt mit deepL
Im Frühjahr 1938, nach einem zweijährigen Guggenheim-Stipendium und einer damit verbundenen Reise, ließen sich Edward Weston und seine damalige Frau Charis Wilson in den Carmel Highlands nieder. Neil, ein Sohn aus erster Ehe Edwards, baute ein kleines Häuschen für die beiden, mit nur einem großen Raum, einer Dunkelkammer und einem Badezimmer an einem Ende, sowie einem Dachboden darüber als Lagerraum – Wildcat Hill. Das Haus ist heute immer noch im Besitz der Familie Weston. „Die ersten Aktfotos, die Edward in dieser Umgebung machte, waren von Maudelle Bass, einer jungen Schwarzen, die nach Carmel gekommen war, um ein Programm mit afrikanischen Tänzen zu veranstalten.“1
Maudelle Bass Weston (1908–1989) war eine amerikanische Tänzerin und ein professionelles Aktmodell, die für Diego Rivera, Manuel Álvarez Bravo und andere Künstler gearbeitet hatte. Im Juli 1939 posierte sie erstmals für Edward Weston. In diesen Aktstudien zeigt Weston ihren ganzen Körper, der sich charakteristisch in die natürliche Umgebung einfügt. Weston bewahrte 18 Negative von Maudelle auf, von denen mindestens 12 veröffentlicht worden sind. Frühe Abzüge dieses Bildes sind sehr selten. Dieser Abzug (Nr. 28/100) stammt aus dem Portfolio „Desnudos“, dass 1972 mit den elf großartigsten Aktstudien von Edward Weston von seinem Sohn Cole Weston herausgegeben wurde. Die Abzüge wurden nach dem testamentarischen Willen und der Anleitung Edwards von Cole gefertigt.
Christoph Fuchs
• Edward Weston
geb. 1886 in Highland Park (US), gest. 1958 in Carmel (US)
„Nude“, 1939 (Abzug 1972 von Cole Weston) Gelatinesilberabzug auf Karton, 19 × 24 cm
Sammlung SpallArt, Inv. Nr. S-1463, © Arizona Board of Regents, Center for Creative Photography


•
„Sand and Stone“, 2016 aus dem Portfolio „Resurgence“, Nr. 5
Wenn ich die Arbeiten anderer und meine eigenen betrachte, achte ich auf drei Dinge: Wahrheit, Ehrlichkeit und Klarheit. Wahrheit: Der eigenen Vision und sich selbst treu bleiben. Michelle hat dies in ihrem neuen Werk erreicht. Sie hat das wunderbar hinbekommen, denn ohne den ersten Baustein werden die anderen beiden weniger wichtig. Man muss seine Arbeit betrachten und sich fragen: Warum mache ich dieses Foto? Dies ist ein Gespräch, das nur zwischen dem Künstler und seiner Vision stattfindet. Klarheit: Ein ehrliches Verständnis dafür, wie man den Rahmen füllt, ist so wichtig, es definiert unsere Vision. Es ist die Grundlage eines Bildes, es ist unsere Stimme. Jeder von uns sieht anders. Wenn wir unsere Stimme oder Sprache beherrschen, stehen wir allein da, und Michelle hat das mit großem Geschick geschafft. Ehrlichkeit: Wenn man sich der Welt öffnet, indem man seine Bilder zeigt, ist es so wichtig, wie man mit diesem Austausch umgeht. Michelle ist wunderbar selbstbewusst, aber nicht übermäßig selbstsicher. Sie ist bescheiden und stolz, und ihre Ehrfurcht vor ihrer Arbeit und ihr Respekt davor sind wirklich erfrischend. Sie hat alles: Wahrheit, Klarheit und Ehrlichkeit.
Kim Weston1
• Michelle Magdalena Maddox geb. 1985 in San Diego (US), lebt und arbeitet in Pacific Grove (US)
„Adrift“, 2016 aus dem Portfolio „Resurgence“, Nr. 6
Gelatinbesilberabzüge, je 20,3 × 20,3 cm
Sammlung SpallArt, Inv. Nr. S-2781, S-2782, © Michelle Magdalena Maddox


„Am Samstag, den 7. April 1984 um ca. 14 Uhr begann sich die Venus von Willendorf für ihre letzte Reise vorzubereiten. Nach 75-jähriger Gefangenschaft wollte sie an ihren Heimatort zurückkehren. Kurz dachte sie an jenen Tag im Jahre 1908, an dem ihre Jahrtausende währende Ruhe plötzlich gestört wurde. Nun, sie musste es tun. Langsam schlich sie sich beim Wärter vorbei und schlüpfte mit hastenden Schritten ins nahe gelegene Grün. So irrte sie an diesem Aprilsamstag in der Großstadt herum. Am Sonntag endlich fand sie die Gelegenheit, bis zu ihrem Heimatort zu gelangen. Überglücklich fand sie ihr Zuhause. Nach einem kurzen Blick in die Umgebung begann sie rasch, sich ihre Ruhestätte zu schaufeln. Sie legte sich hinein und war eins mit der Erde.“1
In einer eigenen kleinen satirischen Fotoserie würdigt Robert Zahornicky das weltbekannte Artefakt der Venus von Willendorf. Die altsteinzeitliche, rund 11 cm große und etwa 29.500 Jahre alte Venusfigurine ist Österreichs bekanntester archäologischer Fund. Eine neue geologische Analyse des Naturhistorischen Museums Wien ergab, dass die Figurine mit großer Wahrscheinlichkeit aus norditalienischem Gestein hergestellt worden war, am ehesten aus dem Gebiet um den Gardasee. Die Auslegung der Venus als Fruchtbarkeits- und Sexgöttin ist mittlerweile überholt und ein Resultat des gesellschaftlichen Rollenbildes des 19. Jahrhunderts, genauso wie der Begriff „Venus“, der aus einer Zeit stammt, in der Nacktheit noch als sehr skandalös empfunden wurde. Die moderne Wissenschaft sieht in der Figurine eine Repräsentation der weisen, alten Frau – der Großmutter. Mittlerweile nehmen wir an, dass während die Großmütter die Kinder auf das steinzeitliche Leben vorbereiteten, die jungen Frauen mit den Männern auf Jagd gingen.2 Christoph Fuchs • „Venus 01, Naurhistorisches Museum“, 1984 aus der Serie „Die letzte Reise der Venus von Willendorf“
1 Robert Zahornicky, http://www.zahor.net/aktionen.html (aufgerufen 23.1.2025)
2 THE DISSIDENT GODDESSES‘ NETWORK ist ein interdisziplinäres Forschungsprojekt, das sich, ausgehend von den bedeutenden Funden weiblicher Figurinen aus Niederösterreichs Früh- und Urgeschichte, der Fragestellungen annimmt, die sich aus heutiger Sicht an diese Funde anschließen lassen. https://www.tdgn.at
• Robert Zahornicky
geb. 1952 in Wien (AT), lebt und arbeitet in Pressbaum (AT)
„Venus von Willendorf“, 1989 Gelatinesilberabzug, 23 × 17 cm
Sammlung SpallArt, Inv. Nr. S-859, © Robert Zahornicky / Bildrecht, Wien

• Elfriede Mejchar
geb. 1924 in Wien, gest. 2020 in Wien (AT)
ohne Titel, 1988
Gelatinesilberabzug auf PE-Papier, 30 × 30 cm
Sammlung SpallArt, Inv. Nr. S-2249, © Elfriede Mejchar Nachlass

Hannes Kilian arbeitete als freier Fotograf für zahlreiche renommierte Zeitschriften und Magazine. Er war jedoch nicht nur Chronist und Pressefotograf. Ob imposante Architektur- oder ästethische Modefotografien: Entscheidend waren stets sein Blick auf eine künstlerische Bildkomposition und das besondere Gespür für Licht und Schatten. Kilians Reisereportagen aus Italien, Spanien, Ägypten, Israel, Portugal oder Frankreich sind legendär. Im Laufe seines Schaffens entwickelte Kilian in seinem fotografischen Werk eine unverwechselbare Bildsprache, die sich durch einen gekonnten Einsatz von Licht und Schatten und eine oft ungewöhnliche Perspektive auszeichnet.
Johanna Breede, photokunst, Berlin
• Hannes Kilian geb. 1909 in Ludwigshafen (DE), gest. 1999 in Wäschenbeuren (DE)
„In den Dünen von Alicante“, 1965
Gelatinesilberabzug, 40 × 30 cm
Sammlung SpallArt, Inv. Nr. S-2511, © Hannes Killian / Bildrecht, Wien

Landschaften sind für mich stets Bühne und Kulisse meiner fotografischen und filmischen Interventionen und Inszenierungen. Diese Interventionen stehen für ein individuelles, subjektives Handeln eines einzelnen, queer definierten Körpers als Akteur:in in der Natur. Sie werfen einen Blick vom Naturbild zurück auf die Betrachter:innen und thematisieren zentrale Fragen zu Raum, Territorium und dessen identifikatorischer Aneignung.
Die Foto- und Videoarbeit im Schilf ist Teil der übergeordneten Werkserie solitude and wilderness. In dieser bevölkern seltsam anmutende Wesen die Landschaft. Ihre Verkleidungen bestehen meist aus vor Ort gefundenem Material. Die Tarnung funktioniert jedoch nur halb – der Mensch darunter wird unweigerlich als solcher entlarvt. Wir können unsere menschliche Identität nicht verleugnen. Die naiv anmutende Geste, der Natur so nahe wie möglich sein zu wollen, soll jedoch nicht über den dringlichen Wunsch dahinter hinwegtäuschen. Im Schilf richtet sich gegen das dualistische Denken zwischen Natur und Kultur – ein Denken, das uns zwar aus technologischer Sicht beeindruckende Errungenschaften beschert hat, uns aus ökologischer Perspektive jedoch in ein tiefes Zerwürfnis im Verhältnis zu unserer Umwelt geführt hat.
Markus Guschelbauer
Markus Guschelbauer geb. 1974 in Friesach (AT), lebt und arbeitet in Wien (AT)
„Im Schilf“, 2020/2024 aus der Serie „solitude and wilderness“ Video, 1:22 min
Sammlung SpallArt, Inv. Nr. S-2773, © Markus Guschelbauer / Bildrecht, Wien

Die Fotografie ist ein Spiel mit Perspektiven, Interpretationen und Bedeutungen. Im Zentrum dieses Spiels steht der Blick – der Blick der Fotograf:in, der fotografierten Person und der Betrachter:in. Der Blick lenkt die Aufmerksamkeit, definiert Beziehungen, erzeugt Spannung und Intimität.
Der Blick der fotografierten Person bildet oft das zentrale Element einer Fotografie. Er kann herausfordernd, verführerisch oder verletzlich wirken. Direkt in die Kamera gerichtet, stellt er eine Verbindung her, die die Betrachter:in förmlich in das Bild mit einbezieht und einen Dialog eröffnet. Ein abgewandter Blick hingegen kann Distanz schaffen, Rätsel aufwerfen oder eine Geschichte andeuten, die außerhalb des Bildrahmens liegt.
Genauso entscheidend ist der Blick hinter die Kamera. Die Wahl des Ausschnitts, der Perspektive und der Fokussierung bestimmt, wie ein Bild gelesen wird. Der fotografische Blick reflektiert nicht nur die technische und künstlerische Absicht der Fotograf:in,
sondern auch die Haltung gegenüber dem Subjekt. Ist der Blick dokumentarisch, inszeniert, wertend oder neutral? Jede Fotografie trägt die Handschrift der Person, hinter der Kamera.
Auch der Blick der Betrachter:innen spielt eine Rolle. Er komplettiert das Bild, indem er dessen Inhalte interpretiert und neue Bedeutungen hinzugefügt. Dabei wird der Blick in der Fotografie oft politisch: Wer schaut wen an? Wer hat die Kontrolle über den Blick? In der Porträt- und Dokumentarfotografie beispielsweise wird der Blick häufig mit Fragen von Macht, Identität und Repräsentation verknüpft.
Durch den Einsatz des Blicks in Fotografien werden Dynamiken zwischen Nähe und Distanz, Macht und Verletzlichkeit erzeugt. Der Blick wird zu einem unsichtbaren Faden, der Bild und Betrachter:innen miteinander verknüpft – ein stiller, aber intensiver Dialog über das Sehen und Gesehenwerden.
Cäcilia Steinkellner

Die österreichische Künstlerin Elke Krystufek ist bekannt für ihre Arbeiten in den Bereichen Malerei, Fotografie, Performance und Installationskunst. Ihre Werke beschäftigen sich oft mit Themen wie Identität, Sexualität, Feminismus und gesellschaftliche Normen.
Die mehrteilige Arbeit Pain(ting)?! zeigt Krystufek in einer Art von Selbstinszenierung, die ihren eigenen Körper und dessen Verletzlichkeit thematisiert. Es könnte als eine Art Selbstporträt verstanden werden, das nicht nur ihren Körper, sondern auch die damit verbundenen emotionalen und physischen Erfahrungen widerspiegelt. Der Titel Pain(ting)?! stellt eine provokante Verbindung zwischen Pain (Schmerz) und Painting (Malerei) her, was darauf hinweist, dass Kunst – insbesondere in Krystufeks Fall – sowohl mit körperlichem als auch mit emotionalem Schmerz verbunden ist.
Der Körper ist in vielen von Krystufeks Arbeiten ein zentrales Element und in Pain(ting)?! ist er gleichzeitig Subjekt und Objekt der Darstellung – die Grenze zwischen Kunstwerk und Künstlerin verschwimmt dabei. Die Art und Weise, wie Krystufek ihren Körper abbildet, ist oft durchdrungen von einer Mischung aus Verletzlichkeit und Stärke. Dieser Körper kann als eine Art von Leinwand betrachtet werden, auf der Schmerz als künstlerisches Medium verarbeitet wird.
Christoph Fuchs
Elke Krystufek
geb. 1970 in Wien (AT), lebt und arbeitet in Wien und Berlin (DE)
„Pain(ting)?!“, 1998
C-Prints, je 100 × 70 cm
Sammlung SpallArt, Inv. Nr. S-1084 und S-1085, © Elke Krystufek

Da stehen zwei Nackte im Badezimmer und blicken in den Spiegel. […] Beide blicken sie aus dem Spiegel heraus auf das Publikum. Dieses denkt: „Was auf den ersten Blick wie ein neckisches Spiel zwischen Liebenden aussieht, ist in Wirklichkeit etwas ganz anderes.“ Und in der Tat, so erkennen wir auf den zweiten Blick, wird hier ein bekanntes Thema aus der Kunstgeschichte zitiert: Adam und Eva. nicht nur bei Dürer, Cranach und van Eyck ein beliebtes Motiv.
Unter Rückgriff auf bekannte, vor allem malerische Werke von der Renaissance bis zur Pop Art durchforstet das österreichische Künstlerpaar Rosa Brueckl und Gregor Schmoll die Kunstgeschichte und kleidet dabei so manchen Klassiker in ein modernes, zeitgemäßes Gewand. Im Gegensatz zu Cindy Shermans History Portraits
stülpen sie sich aber keine Maske über, sondern stellen allein in Mimik und Pose die Figuren ihrer Vorbilder nach. Auch ist die narzisstische Selbstinszenierung nicht nur im Sinne des Selbstporträts oder des Rollenspiels mit fiktiven Charakteren zu sehen. Denn der zumeist kühle, distanzierte Blick macht deutlich, dass Brueckl und Schmoll in ihren Rollen nicht aufgehen, sondern ganz bewusst vor der Kamera posieren. Und wenn Rosa und Gregor als Adam und Eva in den Badezimmerspiegel blicken, so machen sie nicht nur die Klischeehaftigkeit bildwirksamer Posen deutlich, sondern betreiben auch Selbstreflexion. […] Dadurch ist auch den Betrachter:innen von Adam und Eva (hier „Im Garten Eden“) eine Rolle im Paradies zugedacht: Indem wir selbst in den fotografierten Spiegel blicken.
Manisha Jothardy1
1 aus: Manisha Jothardy, ‚Kunstgeschichte als Rollenspiel‘, FRAME 06, März/April 2001
Rosa Brückl
geb. 1970 in Graz (AT), lebt und arbeitet in Wien (AT)
Gregor Schmoll
geb. 1970 in Bruck a.d. Mur (AT), lebt und arbeitet in Wien (AT)
aus der Serie „Im Garten Eden“, 1998
C-Print, 20 × 20 cm
Sammlung SpallArt, Inv. Nr. S-1097, © Rosa Brueckl & Gregor Schmoll

Die narzisstische Gegenüberstellung von „Ich“ und Selbstbild findet sich auch im Werk der österreichisch-amerikanischen Fotografin
Lillian Birnbaum. Ihr Foto Hannah und Spiegel von 1992 zeigt eine komplexe Fragmentierung von Identität und Körper. Birnbaum schafft das außergewöhnliche Porträt der Schauspielerin Hanna Schygulla durch eine ineinander verwobene Komposition aus Kamera, Wand und Kosmetikspiegelreflexen. Es ist das gebrochene Selbst, das Birnbaum in den Blick nimmt – die Dekonstruktion unseres Bildes von Persönlichkeit.
Johanna Brede, Photokunst
• Lillian Birnbaum
geb. 1955 in New York (US), lebt und arbeitet in Paris (FR)
„Hannah und Spiegel“, 1992
Gelatinesilberabzug, 26 × 40,5 cm
Sammlung SpallArt, Inv. Nr. S-516, © Lillian Birnbaum / Bildrecht, Wien

Die österreicher Fotografin Inge Morath kam in den 1950er Jahren nach New York und arbeitete dort für die bekannte Fotoagentur Magnum, dabei lernte sie auch Helena Rubinstein kennen. Rubinstein war eine Kosmetikmogulin – eine Vorgängerin von Estee Lauder, Bobbi Brown und Kevyn Aucoin – und legte den Grundstein für eine Schönheitsindustrie, die heute ein Milliardengeschäft ist. Bereits Mitte der 1920er Jahre war das Unternehmen, das ihren Namen trug, 7,5 Millionen Dollar wert. Damit war Rubinstein eine der ersten Selfmade-Frauen, die ein sechsstelliges Vermögen anhäuften. Offensichtlich hatten Morath und Rubinstein ein gemeinsames Auge für die Freude, die man beim Betrachten schöner Dinge empfinden kann. 1957 fotografierte Morath die Geschäftsfrau zu Hause, wie sie liebevoll ein Stück aus ihrer Kunstsammlung betrachtete. Im darauffolgenden Jahr besuchte sie einen von Rubinsteins Salons in der 5th Avenue in New York, um das tägliche Geschehen zu dokumentieren, unter anderem eine Lektion über die perfekte Augenbraue und eine Schulung zu Rubinsteins Produkten.
Inge Morasths späterer Ehemann, der Schriftsteller Arthur Miller schrieb zu diesem ikonischen Bild einst: „An army of women undergoing the painstaking ritual of a facial care at Helena Rubinstein, the procedure accompanied by quasi-scientific drawings on the board, in the end, the final result successfully demonstrated by the maestro on the ‚experimental object‘ “1
Moraths Fotografien aus dem Schönheitssalon sind einzigartig, da sie den Fokus nicht nur auf die Schönheitsprodukte und -behandlungen legen, sondern auch auf die Frauen und ihre individuellen Persönlichkeiten. Die Bilder zeigen Frauen, die sich entspannt und selbstbewusst in ihrer Haut wohlfühlen. Moraths Arbeit im Kosmetiksalon von Helena Rubinstein hat dazu beigetragen, die Idee von Schönheit und Weiblichkeit in den 1950er Jahren zu verändern und die Vielfalt der Frauen in der amerikanischen Gesellschaft zu zeigen.
Christoph Fuchs
1 Hannah Tindle, „Inside Madame Helena Rubinstein’s Beauty School“, Magnum Photos, 2018, https://www.magnumphotos.com/arts-culture/society-arts-culture/ inge-morath-inside-helena-rubinsteins-beauty-salons/ (aufgerufen am 4.2.2025)
Inge Morath
geb. 1923 in Graz (AT), gest. 2002 in New York (US)
Ausbildung im Kosmetiksalon von Helena Rubinstein in der 5th Avenue, New York, 1958
Gelatinesilberabzug, 32 × 47,5 cm
Sammlung SpallArt, Inv. Nr. S-1838, © Inge Morath / Magnum Photos


•
„The Fifty Faces of Juliet“, 1981 Buch von Man Ray
Das Foto zeigt Juliet Browner (1911–1991, ab 1946 Juliet Man Ray), die spätere Frau des bekannten amerikanischen Künstlers Man Ray. Man Ray siedelte 1940 von Paris zurück nach Amerika. Wenige Tage nach seiner Ankunft in Los Angeles lernte er Juliet Browner kennen. Sie hatte eine rumänisch-jüdische Abstammung und war ausgebildete Tänzerin, die bei Martha Graham studierte, sowie ein erfahrenes Künstlermodell, das den Malern des Abstrakten Expressionismus als Inspiration diente. „After dinner we went to a night club where some of the best jazz of the period was being played. We danced. Juliet was like a feather in my arms.“1 (Nach dem Abendessen gingen wir in einen Nachtclub, in dem einer der besten Jazzsongs der damaligen Zeit gespielt wurde. Wir tanzten. Juliet war wie eine Feder in meinen Armen).
1946 heirateten sie in einer Doppelhochzeit zusammen mit Max Ernst und Dorothea Tanning in Beverly Hills. Von 1940 bis 1955 fertigte Man Ray zahlreiche Aufnahmen von Juliet, die er Anfang der 1950er Jahre mit einer Auswahl von 50 Aufnahmen in einem Buch als Hommage an Juliet vergeblich zu realisieren versuchte. Diese fünfzig Fotografien sind „eine Botschaft und Man Rays Liebeserklärung“ an Juliet, die seine letzte Geliebte, seine Gefährtin, seine Freundin, seine Frau, aber auch sein Modell und seine Muse darstellte. Ihr Gesicht ist unvergesslich.2 Erst 1981 anlässlich einer Ausstellung in der Fondazione Mazzotta in Mailand, fünf Jahre nach dem Tod von Man Ray, wurde das Buch in Zusammenarbeit mit Juliet veröffentlicht.
Christoph Fuchs
1
„Juliet Dancing (PDF)“, Performing Arts in Art, J. Paul Ghetty Museum, https://www.getty.edu/education/teachers/classroom_resources/ curricula/performing_arts/downloads/juliet_dancing.pdf (aufgerufen 18.10.2024)
2
Fondazione Marconi, „Man Ray. The Fifty Faces of Juliet“, Pressemeldung, https://www.fondazionemarconi.org/en/exhibition/manray-the-fifty-faces-of-juliet/press-release (aufgerufen 18.10.2024)
• Man Ray
geb. 1890 in Philadelphia (US), gest. 1976 in Paris (FR)
„Juliet“, 1945 (Abzug 1991)
Gelatinesilberabzug, 27,3 × 18,6 cm
Sammlung SpallArt, Inv. Nr. S-2792, © Man Ray Trust /ADAGP

Sheila Rocks fotografische Karriere begann mit Aufträgen für das legendäre britische Lifestyle- und Modemagazin The Face. Ende der 1970er Jahre wurden dort Sheila Rocks Fotografien von den bekannten Punkbands The Clash und Generation X veröffentlicht und sie arbeitete bis Ende der 1980er Jahre regelmäßig für die Zeitschrift. Rock genoss die künstlerische Freiheit, die in ihren Dokumentarfotografien zum Ausdruck kommt.
Die Arbeit Girl in Bath, London ist eines ihrer ikonischen Werke. Sie zeigt ein junges Mädchen in einer Badewanne und verkörpert eine Mischung aus Intimität, Verletzlichkeit und zeitloser Eleganz. Die Fotografie wird oft mit dem New Wave-Look in Verbindung gebracht, einer Ästhetik, die Sheila Rock durch ihre Arbeit in den 1980er Jahren maßgeblich geprägt hat. Das Bild ist ein Symbol für die Freiheit und die Spontanität der künstlerischen Szene Londons in den späten 1970er und frühen 1980er Jahre. Sheila Rock hat oft den Nerv einer Ära getroffen und Girl in Bath, London gehört zu jenen Arbeiten, die sowohl die Stimmung als auch die Ästhetik dieser Zeit einfangen.
Christoph Fuchs
• Sheila Rock geb. in Chicago (US), lebt und arbeitet in London (GB)
„Girl in Bath, London“, 1980er Gelatinesilberabzug, 30,4 × 24,2 cm Sammlung SpallArt, Inv. Nr. S-466, © Sheila Rock


Voyeuristische Schnappschüsse des tschechischen Fotografen und Erotomanen Miroslav Tichý. Drei Jahrzehnte lang war er mit selbst gebastelten Kameras in seiner tschechischen Heimatstadt Kyjov unterwegs. Diese Kameras waren oft aus Schachteln, Plastikrohren und anderen ungewöhnlichen Materialien gefertigt, die er mit einfachen Linsen und anderen improvisierten Komponenten ausstattete. Unter dem Mantel hervor, durch Zäune und Gitter hat Tichý dann abgedrückt, täglich hundert Mal, immer in der Hoffnung, einen Blick auf eine Frau zu erhaschen. Die so entstandenen, meist verschwommenen und verwaschenen Fotografien entwickelte er selbst. Auf ihnen finden sich so gut wie immer Flecken der Fotochemie, Fingerabdrücke und sonstiger Schmutz. Nach Tichýs Meinung ist die Imperfektion Teil seiner Kunst. Die Bilder selbst klebte er häufig auf gefundenes Papier oder Karton und verzierte diesen mit unterschiedlichen Stiften. Einzelne Partien der Fotografien, die er betonen wollte, zeichnete er nach und verstärkte so die gewünschte Bildwirkung. So entstanden aus allen seinen Arbeiten begehrte Unikate.
Tichý lebte die ganze Zeit über in Kyjov und behielt seine Bilder für sich, erst spät wurde seine Arbeit entdeckt und anerkannt. In den 2000er Jahren erlangten seine Bilder internationale Aufmerksamkeit und wurden in großen Museen und Galerien ausgestellt.
Christoph Fuchs
Miroslav Tichý
geb. 1926 in Netcice (CZ), gest. 2011 in Kyjov (CZ)
ohne Titel, n.d.
Gelatinesilberabzüge auf Karton, bearbeitet, 27 × 15 cm / 17 × 12 cm
Sammlung SpallArt, Inv. Nr. S-785 und S-786, © Jana Hebnárová

Doisneau arbeitete zunächst für den Werbefotografen André Vigneau, in dessen Studio er Künstler:innen und Schriftsteller:innen mit avantgardistischen Ideen kennenlernte. Er arbeitete dann während der Depressionsjahre der 1930er Jahre als Industriefotograf für den Automobilkonzern Renault. In dieser Zeit fotografierte Doisneau auch auf den Straßen und in den Stadtvierteln von Paris, in der Hoffnung, seine Arbeiten an die Bildzeitschriften zu verkaufen, die zunehmend Fotografien zur Illustration einsetzten.
Holden Luntz Gallery, Palm Beach
• Robert Doisneau
geb. 1912 in Gentilly (FR), gest. 1994 in Paris (FR)
„Créatures de Rêve“, 1952 (Abzug 1975)
Gelatinesilberabzug, 26,3 × 17,6 cm
Sammlung SpallArt, Inv. Nr. S-1870, © Atelier Doisneau / Bildrecht, Wien


• David Hockney
geb. 1937 in Bradford (GB), lebt in US und GB
„Portrait of an Artist (Pool with Two Figures)“, 1972
Acryl auf Leinwand, 213,5 × 305 cm
© David Hockney
1
dpa, „Maler David Hockney wird 80“, Monopol. Magazin für Leben und Kunst, 2017 (https://www.monopol-magazin.de/david-hockney-wird-80, aufgerufen 3.10.2024)
Der britische Künstler David Hockney, geboren 1937 in der nordenglischen Stadt Bradford, ist bekannt für sein heiteres und lebensfrohes Gemüt. Das Bild eines unbekannten Fotografen/einer unbekannten Fotografin zeigt Hockney von hinten mit nacktem Hintern während er sich die Hose herunterzieht.
Die komische Situation spielt sich auf einer Art Holzterrasse oder ähnlichem ab. Die herumliegenden Holzlatten und der Schlauch am Boden sowie die Zigarette in der rechten Hand des Mannes in der Mitte lassen vermuten, dass es sich bei der Szene um eine Pause während der Arbeiten an der Terrasse handelt. Die Szene könnte sich auch am Rand eines der zahlreichen in Hockneys malerischem Werk festgehaltenen Schwimmbecken abspielen, wie zum Beispiel im bekannten Gemälde Portrait of an Artist (Pool with Two Figures) aus dem Jahr 1972.
Das Bild zeigt Hockneys offenen Umgang mit Nackheit und Sexualität. Hockney macht nie ein Geheimnis daraus, dass er schwul ist, selbst als Homosexualität in Großbritannien noch illegal war. Beim Studium an der besten Kunsthochschule des Landes malt er zwei Jungs, die sich umarmen. Ein kinderähnliches Gekritzel, verziert mit den Worten „We Two Boys Together Clinging“. Sein Lehrer kommentiert damals nur trocken: „Ich hoffe, Sie kommen sich nicht noch näher.“ Auch in den 1980er Jahren, als viele seiner Freunde an Aids sterben, bleibt er seinen lebensfrohen Motiven treu – vielleicht um dem Tod etwas entgegenzusetzen?1
Christoph Fuchs
unbekannt
David Hockney, 1980er Gelatinesilberabzug auf Karton, 25 × 20 cm
Sammlung SpallArt, Inv. Nr. S-2783

Der Schweizer Hugo Jaeggi absolvierte eine Berufslehre zum Fotografen in Solothurn. Nach dem Besuch der Kunst- und Gewerbeschule in Vevey, war er ab 1961 als freischaffender Fotograf in Basel tätig, wo er bis 1974 auch ein Fotogeschäft betrieb. Parallel zu kommerziellen Auftragsarbeiten, verfolgte Jaeggi stets eigene Projekte von hohem künstlerischen Anspruch, die er seit den 1980er-Jahren in zahlreichen Ausstellungen gezeigt hat. Bis 2016 unterrichtete er zudem an einer Rudolf Steiner-Schule im Raum Basel. Seine früheren Arbeiten geben Einblick in den Alltag von Fabrik- und Landarbeitern der Schweiz aus den 1950er- und 1960erJahren. Später führten ihn diverse Reportage-Auftragsarbeiten in verschiedene Teile der Welt, von Belarus über Indonesien nach Südamerika. Im Rahmen von Langzeitporträtstudien, begleitete er Menschen über Jahrzehnte hinweg mit seiner Kamera. Entstanden sind Fotografien, die von einer hohen Sensibilität für die Gunst des Augenblicks zeugen und zugleich eine expressive und experimentelle künstlerische Handschrift tragen.
Fabian & Claude Walter Galerie, Zürich1
• Hugo Jaeggi
geb. 1936 in Solothurn (CH), gest. 2018 in Burg im Leimental (CH)
„Der 18. Geburtstag, Basel“, 1983
Gelatinesilberabzug, 30 × 40 cm
Sammlung SpallArt, Inv. Nr. S-2450, © Fotostiftung Schweiz

Der amerikanische Fotograf George S. Zimbel ist für seine klassische Streetphotography in den 1940er und 1950er Jahren vor allem in New York bekannt, das zu dieser Zeit einen Wandel der Urbanisierung erlebte.
Das Bild Boys on 93rd Street, New York City vermittelt sowohl das unbeschwerte Gefühl der Kindheit als auch die Hektik der Großstadt. Zimbel fängt die Dynamik der Stadt und das lebendige Leben auf den Straßen ein. Die Aufnahme gehört zu jenen, die das Leben in New York City nach dem Zweiten Weltkrieg dokumentieren, eine Zeit des wirtschaftlichen Aufschwungs und sozialen Wandels. Es ist eine frühe Arbeit, die durch einen unaufdringlichen, dokumentarischen Stil geprägt ist. Ein hervorragendes Beispiel für den Einfluss, den die Fotojournalisten und Street-Fotografen der Mitte des 20. Jahrhunderts auf die Darstellung des städtischen Lebens und der sozialen Landschaft hatten. Zimbel hatte die Fähigkeit, alltägliche Szenen in Momentaufnahmen zu verwandeln, die sowohl poetisch als auch realistisch waren.
Christoph Fuchs
• George S. Zimbel
geb. 1929 in Woburn (US), lebt und arbeitet in Montreal (CA)
„Boys on 93rd Street, New York City“, 1949 (Abzug 1992)
Gelatinesilberabzug, 19,7 × 18,5 cm
Sammlung SpallArt, Inv. Nr. S-1303, © George S. Zimbel

Horst P. Horst hat einige ikonische Modebilder geschaffen, das Corset, Paris – auch bekannt mit dem Titel Mainbocher-Korsett – ist sein berühmtestes Foto. Es ist zu einer der bekanntesten Modefotografien des 20. Jahrhunderts geworden.
Die Aufnahme erweitert die traditionelle Modefotografie um eine weitere Ebene der Raffinesse, indem sie das Motiv des nackten Rückens des Modells verwendet und sich auf mehrere Vorbilder aus der Pariser Kunstgeschichte bezieht, darunter die Akte von Ingres und Man Rays Le Violin d’Ingres von 1924.
Im Jahr 1939, als Horst diese Fotografie komponierte, galt die Pariser Unterwäsche als sehr begehrenswert und das Korsett war nach einer Zeit der Unpopularität wieder in Mode gekommen. Als Kleidungsstück war es jedoch mit offensichtlichen sexuellen Konnotationen behaftet, was Horsts Bild eine gewisse Berühmtheit einbrachte. Das Originalnegativ zeigte die linke Seite des Korsetts, die von der Seite des Modells weghing. Dies wurde für die Veröffentlichung als zu gewagt erachtet, und so wurde das Negativ so retuschiert, dass es aussah, als würde das Korsett eng am Körper des Modells anliegen.
Das Bild ist nicht nur emblematisch für eine Schlüsselperiode der Mode, sondern markiert auch das Ende einer Ära – sowohl
für Horst als auch für seine Heimat Europa. Horst hatte seit den frühen 1930er Jahren als Hauptfotograf für die französische Vogue in Paris gearbeitet, doch im Sommer 1939 war die Bedrohung durch die Nazis so groß geworden, dass er sich gezwungen sah, Paris in Richtung New York zu verlassen. Dieses Bild, das in den Studios der französischen Vogue aufgenommen wurde, entstand noch am Abend seiner Abreise, wie er später erklärte: „Es war das letzte Foto, das ich in Paris vor dem Krieg gemacht habe. Ich verließ das Atelier um 4 Uhr morgens, ging zurück ins Haus, holte mein Gepäck und nahm den Zug um 7 Uhr nach Le Havre, um an Bord der Normandie zu gehen. Das Foto ist für mich etwas Besonderes. Während ich es aufnahm, dachte ich an all das, was ich hinter mir ließ.“
Das Foto markiert also nicht nur das Ende eines wichtigen Abschnitts in Horsts früher Karriere, sondern auch das Ende eines goldenen Zeitalters für Paris als Zentrum der Kultur und Mode. Die Welt von Picasso, Man Ray, Hemingway und Coco Chanel war im Begriff, von viel dunkleren Zeiten überschattet zu werden und die Avantgarde zog über den Atlantik in den Hafen von New York.
Huxley-Parlour Gallery, London
• Horst P. Horst
geb. 1906 in Weißenfels an der Saale (DE), gest. 1999 in Palm Beach Gardens (US)
„Corset, Paris“, 1939 (Abzug 1980)
Gelatinesilberabzug, 25,5 × 20 cm
Sammlung SpallArt, Inv. Nr. S-2771, © Horst Estate

Max Lohr war ein deutscher Ingenieur und Amateurfotograf, der als Pionier der Fotokunst gilt. Seine puristischen und zugleich experimentellen Arbeiten gerieten lange Zeit in Vergessenheit, erfahren jedoch in den letzten Jahren eine Wiederentdeckung.
Zwischen 1926 und 1931 schuf Lohr eine Vielzahl ausdrucksstarker Fotografien, darunter Stadt- und Architekturansichten, Landschaften, Stillleben, Porträts und Aktstudien. Ein charakteristisches Merkmal seiner Arbeiten ist die bewusste Verwendung von Unschärfe als Stilmittel. Die so erzielte malerische Wirkung erinnert an den zu dieser Zeit bereits ausklingenden Piktorialismus. Nach 1931 wandte sich Lohr verstärkt seiner Tätigkeit als Ingenieur zu.
Hautnah fühlt man sich dem männlichen Rückenakt. Gleichzeitig ist jedoch der Interpretation jener Dinge, die der Protagonist in der Ferne sieht, viel Raum gegeben.
Christoph Fuchs und Fritz Simak
• Max Lohr
geb. 1909 in Regensburg (DE), gest. 1992 in Weilheim (DE)
„Der Rücken“, 1920er
Gelatinesilberabzug, 23 × 17 cm
Sammlung SpallArt, Inv. Nr. S-563, © Max Lohr Nachlass

1
Miloš Heyduk war ein tschechischer Fotograf, der vor allem für seine experimentelle Herangehensweise an die Fotografie bekannt war. In den 1950er bis 1980er Jahren arbeitete Heyduk in verschiedenen Genres der Fotografie, wobei er oft die Grenzen zwischen Fotografie und Kunst auslotete.
Venuše a Kupido (Venus und Amor) greift das mythologische Motiv von Venus und Amor auf, ein klassisches Motiv in der Kunstgeschichte, das seit der Antike in verschiedenen Medien und von vielen berühmten Künstler wie Rubens, Tizian und Boucher dargestellt wurde. Venus, die römische Göttin der Liebe und Schönheit und ihr Sohn Amor (oder Cupido) sind häufige Figuren in mythologischen Darstellungen, die sich mit Themen der Liebe, Begierde und menschlichen Beziehungen befassen.
Im Bild blickt die nackte liegende Frau auf das Gemälde Venus vor dem Spiegel von Diego Velázquez aus den Jahren 1647–1651. Velázquez stellt Venus ohne weitere Attribute mit dem Rücken zur Betrachter:in auf einem Bett liegend dar. Sie blickt in einen Spiegel, der von einem geflügelten Wesen, Amor, gehalten wird. Daran wird der göttliche Zusammenhang erkennbar. Das im Spiegel gezeigte Gesicht wird nur mehr verschwommen sichtbar. Daneben eröffnet Heyduk mit der Verdoppelung der liegenden Venus weitere Themenfelder wie Selbstwahrnehmung, Kunstbetrachtung und Kunstinterpretation.
Ein kleines Detail am Rande: die geometrische Position des Spiegels im Bild von Velázquez würde nicht das Gesicht der Venus zeigen – das wurde auch in einem Experiment nachgestellt.1
Vielleicht könnte es das Gesicht der Frau in der Fotografie sein?
Christoph Fuchs
Miloš Heyduk
geb. 1933 in Kuřimi (CZ), gest. 2012 in CZ
„Venuše a Kupido“, 1971
Gelatinesilberabzug, 9 × 18,5 cm
Sammlung SpallArt, Inv. Nr. S-2251, © Miloš Heyduk Estate

Die amerikanische Fotografin und Aktivistin Nan Goldin ist bekannt für ihre einfühlsamen Porträts, die oft intime und persönliche Momente festhalten. Ihre Arbeiten bieten einen tiefen Einblick in das Leben ihres Freundeskreises und reflektieren Themen wie Identität, Beziehungen und die lgbtq+ Kultur.
In vielen ihrer Bilder, so auch in Simon in his blue pyjamas, nyc fängt Goldin einen ruhigen, persönlichen Moment ein, der die enge Beziehung zwischen Fotografin und ihrem Gegenüber widerspiegelt. Dies jedoch vor dem Hintergrund, dass die meisten ihrer abgebildeten Freund:innen und Bekannten aus den 1970er und 1980er Jahren Anfang der 1990er bereits tot waren, entweder an einer Überdosis Drogen oder an aids gestorben. Über den Protagonisten Simon, der auch noch auf einigen späteren Fotografien abgebildet ist, wissen wir jedoch gar nichts.
Christoph Fuchs
• Nan Goldin
geb. 1953 in Washington (US), lebt und arbeitet in Paris (FR) und New York (US)
„Simon in his blue pyjamas, NYC“, 1996
Cibachrome, 67 × 99 cm
Sammlung SpallArt, Inv. Nr. S-1763, © Nan Goldin / courtesy of the artist and Marian Goodman Gallery

Die Darstellung von Körperpaaren in der Fotografie eröffnet ein facettenreiches Spiel aus Nähe, Dynamik und Beziehung. Zwei Körper im Bild erzählen immer eine Geschichte und stehen zueinander im Dialog, oft ohne Worte, allein durch Haltung, Berührung und Präsenz.
Die Fotografie von Paaren fängt die feinen Nuancen der Interaktion ein. Hände, die sich finden, Blicke, die sich treffen oder Bewegungen, die sich spiegeln. Sie zeigen die Anziehung und Spannung zwischen Individuen, aber auch die Verletzlichkeit und Intimität, die in diesen Begegnungen liegt.
Historisch spiegeln Fotografien von Körperpaaren gesellschaftliche Normen und Veränderungen wider. In der frühen Porträtfotografie standen oft Ehepaare oder Geschwister im Fokus, deren starre Posen von den Zwängen ihrer Zeit und den technischen Gegebenheiten zeugten. Später brachten Künstler:innen wie Robert Map-
plethorpe oder Nan Goldin eine neue Offenheit in die Darstellung, indem sie Liebe und Sexualität, aber auch Konflikte und Einsamkeit zwischen Paaren unverblümt einfingen. In der modernen Fotografie greifen Künstler:innen oft auf experimentelle Ansätze zurück, um die Komplexität zwischenmenschlicher Beziehungen zu verdeutlichen. Sei es durch ungewöhnliche Perspektiven, die Betonung bestimmter Körperteile oder symbolische Requisiten – jede Darstellung lädt zu Reflexionen über Nähe, Distanz und die Dynamik des Miteinanders ein.
Körperpaare sind nicht immer harmonisch. Ihre Darstellung kann Spannung und Gegensätze betonen, die Frage nach Machtverhältnissen aufwerfen oder die Verletzlichkeit von Beziehungen zeigen. Gleichzeitig geht es um Resonanz: die physische und emotionale Verbindung zweier Menschen.
Cäcilia Steinkellner

Félix Bonfils und seine Frau Lydie stammen aus dem Süden Frankreichs. Félix wurde als Fotograf von einem Neffen des Fotopioniers Joseph Nicéphore Niépce ausgebildet und hielt sich im Jahr 1860 während der französischen Militärexpedition im Libanon auf. Bald beschloss er, seine Tätigkeit dorthin zu verlegen und so wurde 1867 in Beirut das erste professionelle Fotostudio der Region gegründet. Seine Frau, die bald vom gemeinsamen Sohn Adrien unterstützt wurde, fertigte Porträts und Genreszenen an, während sie den Libanon, Palästina, Ägypten, die Türkei und Griechenland bereisten und ihre Aufnahmen zurückbrachten. Das Atelier Bonfils war vor allem für seine Landschaften, Sehenswürdigkeiten und Architekturansichten bekannt, die zunächst für Künstler:innen, wohlhabende Reisende, Kunsthistoriker:innen, Archäolog:innen und später für eine wachsende Zahl von Touristen angefertigt wurden. Zu Beginn der 1870er Jahre umfasst der Katalog des Ateliers etwa 15.000 Aufnahmen aus Ägypten, Palästina, Syrien und Griechenland sowie 9.000 stereoskopische Ansichten. Im Jahr 1876 kam Konstantinopel hinzu. Das gesamte Werkverzeichnis der Firma Bonfils ist ebenso umfangreich wie interessant, vor allem weil diese Bilder ein dokumentarisches Anliegen mit einer ästhetischen Herangehensweise an Komposition und Rahmung verbinden. Die große Zahl der Fotografen erklärt die offensichtlichen Qualitätsschwankungen. Die große Nachfrage, die Anforderungen des Handels und das Interesse der Kundschaft am offensichtlich Pittoresken erklären, warum ein Teil der Produktion als eher mittelmäßig eingestuft werden kann und zu Unrecht die Werke von großer Qualität verdunkelt.
Sylvie Aubenas, Bibliothèque Nationale de France
•
Félix Bonfils
geb. 1831 in Saint-Hippolyte-du-Fort (FR), gest. 1885 in Alès (FR)
„Femmes musulmanes syriennes, costume de ville“, 1868–1878 aus dem Reisealbum „Naher Osten“ Albuminabzug, 28 × 21 cm
Sammlung SpallArt, Inv. Nr. S-703

František Drtikol war der erste bedeutende tschechische Fotograf. Nach einer Fotografenlehre in seiner Heimatstadt Příbram besuchte er die Lehr- und Versuchsanstalt für Photographie in München (später Bayerische Staatslehranstalt für Lichtbildwesen bzw. Staatliche Fachakademie für Fotodesign). 1907 bis 1935 betrieb Drtikol ein eigenes Studio, zunächst in Příbram, später in Prag. In den 1920er und 1930er Jahren prägten der Stummfilm, die Avantgarde und Art déco sein Schaffen. Schwerpunkt seiner Arbeit war die Aktfotografie im Stil des Art déco. In seinen frühen Werken lässt sich der Einfluss des Prager Symbolismus und des Jugendstils erkennen. Noch vor dem Zweiten Weltkrieg gab František Drtikol die Fotografie auf und widmete sich der Malerei. Sein Ruhm schwand und er starb 1961 einsam und vergessen. Erst in jüngerer Zeit nimmt sein Werk wieder einen hohen Stellenwert in der Geschichte der tschechischen Fotografie ein.
Seine Aktfotografien der 1920er Jahre wurden international gefeiert und prämiert. Sie beeinflussten viele spätere Fotograf:innen
und Künstler:innen und gelten als bahnbrechend, da sie die Fotografie als eigenständige Kunstform etablierten, die über rein dokumentarische Zwecke hinausgeht. Auch heute werden seine Arbeiten als visionär betrachtet, da sie Themen wie Modernität, Weiblichkeit und Ästhetik miteinander verbinden. Obwohl Drtikol mit seinem Werk die graziösen Linien des weiblichen Körpers anhimmelt, ist sein persönliches Urteil über das weibliche Geschlecht und dessen Gleichberechtigung weniger aufgeschlossen, wie aus seinem Tagebuch ersichtlich ist: „In einem Mann ist ein halber Gott und ein halbes Tier. Eine Frau ist gänzlich ein Tier, denn eine Frau kann nie eine selbständige, originelle und großartige Tat zustande bringen. Sie kann nicht gestalten. Alles bei ihr ist eine Kopie, eine erlernte Pose, eine gedankenlose Maschine … Nur in der Liebe kann eine Frau groß sein. Nur im Bett kann eine Frau originell sein.“1
Christoph Fuchs
1
Lucie Drahonovska, „Frantisek Drtikols Fotografien im Kunstgewerbemuseum“, 2004, https://deutsch.radio.cz/frantisek-drtikols-fotografienim-kunstgewerbemuseum-8086262 (aufgerufen am 28.1.2025)
• František Drtikol
geb. 1883 in Příbram (CZ), gest. 1961 in Prag (CZ)
ohne Titel, um 1927
Gelatinesilberabzug auf Karton, 13 × 8 cm
Sammlung SpallArt, Inv. Nr. S-191, © František Drtikol Estate / Bildrecht, Wien

Die Familie von Albert Rudomine zog von Russland nach Paris und dann nach New York, wo er hebräische Theologie studierte. Im Jahr 1917 kehrte er nach Paris zurück und wurde Schneider. Innerhalb weniger Jahre begann er Tänzer zu fotografieren und arbeitete bald als Fotojournalist. 1923 gründete er sein eigenes Studio und spezialisierte sich auf Porträtfotografie und Akte.
Während des Zweiten Weltkriegs arbeitete Rudomine für die französischen Nationalmuseen. Im Musée Auguste Rodin fotografierte er die Werke des berühmten Bildhauers, die er 1950 veröffentlichte. Rudomine druckte auch eine Mappe mit Bildern von frühen Negativen verschiedener Hersteller ab, wobei er Fotopapiere verwendete, die zeitgleich mit den Negativen entstanden waren.
Getty Museum, Los Angeles
• Albert Rudomine geb. 1892 in Kyjiw (UA), gest. 1975 in Paris (FR)
ohne Titel, 1920er
Gelatinesilberabzug, 29 × 21 cm
Sammlung SpallArt, Inv. Nr. S-214, © Albert Rudomine Estate


•
Auch wenn ein Frauenkörper eine erotische Komponente aufweist, die für einen heterosexuellen Mann immer von Bedeutung ist, wirkt der männliche Akt durch die Muskelstrukturierung visuell bei weitem interessanter.
Im Jahr 2004 wurde ich eingeladen, Bilder für die Ausstellung „Sport Eros Kunst“ beizusteuern. Jeder der teilnehmenden Fotografen konnte sich dafür eine Sportart aussuchen. Sofort entschied ich mich für Ringen. Martin Schlagenhaufen, Michael Prenner, Horst Mahn und Norbert Simnovcic erklärten sich bereit, für meine Aufnahmen zu kämpfen.
Spannend wurde es, als es darum ging, die Würfe während des Kampfgeschehens einzufangen, denn beim Auslösen des Verschlusses hatte ich über das entstehende Bild keine Kontrolle: Die Würfe passierten geradezu blitzschnell. Ich konnte nur erahnen, wie das Bild aussehen würde. Eigentlich habe ich die Würfe also „blind“ fotografiert und erst bei der Durchsicht der Kontaktabzüge das passende Bild gewählt.
Im Gegensatz dazu stehen jene Bilder, bei denen die Ringer, kraftvoll verkeilt, gleichsam innezuhalten scheinen. Manchmal bat ich sie auch, kurz zu verharren. Da wusste ich dann genau, wie das Bild aussehen würde, und meine Vorstellungen von kraftvoll verzahnten Muskelpaketen wurden erfüllt.
Fritz Simak1
• Fritz Simak
geb. 1955 in Wien (AT), lebt und arbeitet in Wien und Niederleis (AT)
„Ringer, Nr. 2“, 2004
Gelatinesilberabzüge, je 23 × 29 cm
Sammlung SpallArt, Inv. Nr. S-1046 und S-1047, © Fritz Simak / Bildrecht, Wien

Der deutsche Fotograf Wilhelm von Gloeden wird der Piktorialismus-Bewegung zugerechnet und ist für seine einflussreiche und kontroverse Arbeit in der Porträt- und Aktfotografie bekannt, besonders für seine Fotografien junger Männer. Aufgrund gesundheitlicher Probleme ließ er sich dauerhaft in Taormina in Sizilien nieder. Die Landschaft, das Licht und die mediterrane Kultur inspirierten ihn zu seiner Arbeit. Taormina war damals eine beliebte Destination für europäische Intellektuelle, Künstler:innen und Reisende.
Von Gloeden wurde durch seine inszenierten Fotografien bekannt, die oft junge Männer aus der Region darstellten, teils unbekleidet oder in antiken Gewändern. Diese Bilder sind von der Ästhetik der Antike geprägt und erinnern an klassische Gemälde oder Skulpturen. Er benutzte dabei Requisiten wie Lorbeerkränze, Amphoren und Säulen, um die Szenen antikisierend zu gestalten. Seine Fotografien zeichnen sich durch sorgfältige Komposition und Beleuchtung aus, die seine Werke kunstvoll und malerisch wirken lassen. Von Gloeden arbeitete mit einer damals üblichen Plattenkamera, die eine lange Vorbereitungs- und Belichtungszeit erforderte. Die Szenerie musste daher sorgfältig geplant und inszeniert werden. Dies mag zur großen, fast archaischen Ruhe beigetragen, die seine Bilder ausstrahlen. Er war einer der ersten Fotografen, die Aktaufnahmen im Freien machten. Das verwendete Kollodium-Nassverfahren erforderte, dass die Glasplatte vor Ort, unmittelbar vor der Aufnahme sensibilisiert werden mussten. Nach
der Belichtung musste das nur kurz haltbare latente Bild auf den Glasplatten sofort entwickelt werden, so dass von Gloeden eine Art mobile Dunkelkammer mitführte. Er hinterließ etwa 3.000 Fotografien, von denen der größte Teil nach seinem Tod während des faschistischen Regimes unter Mussolini zerstört wurde, da sie als unsittlich und pornografisch galten.
In den 1960er-Jahren wurde Gloeden im Zuge der sexuellen Revolution wiederentdeckt. Seine Fotografien wurden unter anderem 1977 auf der documenta 6 in Kassel ausgestellt. Künstler wie Robert Mapplethorpe, Cecil Beaton, Andy Warhol und Bruce Weber schätzten und sammelten seine Fotografien. 1978 fertigte der Künstler Joseph Beuys ein Multiple unter dem Titel Von GloedenPostkarten, bestehend aus 13 Motiven, von Gloeden mit Bleistiftzeichnungen versehenen und signierten Exemplaren, nummeriert als Postkarten.
Wilhelm von Gloeden gilt heute als Pionier der künstlerischen Aktfotografie. Seine Arbeiten haben einen wichtigen Platz in der Geschichte der Fotografie und bilden eine Schlüsselrolle in der lgbtq+ Kunstgeschichte. Von Gloeden wird als Künstler angesehen, der die Grenze zwischen Kunst und Tabu überschritt und einen wichtigen Beitrag zur Entwicklung der Fotografie als Kunstform geleistet hat. Dieser Abzug stammt aus der Sammlung des deutschen Fotografen und Fotohistorikers Franz Toth.
Christoph Fuchs
• Wilhelm von Gloeden
geb. 1856 in Volkshagen (DE), gest. 1931 in Taormina (IT)
„Taormina“, 1919
Mattalbuminabzug auf Büttenpapier, 39 × 28 cm
Sammlung SpallArt, Inv. Nr. S-636

Während die Bilder der Serie Seeing Red: The Rapture of Redheads unbestreitbar Rothaarige zeigen, ist das eigentliche Thema Begeisterung – eine Begeisterung der besonderen Art, die bei denjenigen auftritt, die von der gewaltigen Magie der Kamera verzaubert sind.
Nicht alle Fotograf:innen sind von dieser Magie berührt. Im Zentrum von Howard Schatzs Arbeit steht die Art von kompromissloser, weitsichtiger Begeisterung, die Fotograf:innen seit den Tagen von Julia Cameron und Jacques Henri Lartigue beflügelt hat. Ob Rothaarige der Grund für diese Serie sind oder nur ein Vorwand, um zu fotografieren und seine Begeisterung zu zeigen? Howard Schatz zeigt im gleichnamigen Buch zur Serie dreiundneunzig Variationen dieses chromatisch illustrieren Themas, elegant und ein virtuoser Balanceakt zwischen Methodik und feinem Wahnsinn.
Über den Rausch der Fotografie, die Grenzen der Methode und die Besessenheit von einem Thema hinaus, hat Howard Schatz das ultimative Ziel des Porträtisten erreicht: Er hat Respekt und echtes Interesse geboten und im Gegenzug Wahrheit erhalten. Seine Rothaarigen sind heroisch und unvergesslich. Abgesehen von der offensichtlichen Schönheit der Farbe, sowohl der fotografischen als auch der menschlichen, tut Schatz das, was die besten Fotograf:innen tun: Er öffnet unsere Augen und bringt uns dazu, noch einmal zu sehen, was wir bereits zu sehen glauben.
Owen Edwards
• Howard Schatz geb. 1940 in US, lebt und arbeitet in New York (US)
„Sarah & Chanteal“, Juni 1991 aus der Serie „Seeing Red: The Rapture of Redheads“ Cibachrome, 22 × 18 cm
Sammlung SpallArt, Inv. Nr. S-1498, © Howard Schatz and Beverly Ornstein

Die Serie muscles & bones zeigt junge Erwachsene an öffentlichen Badestellen der Alten Donau in Wien. Es geht darum, wie (Geschlechter-)Stereotypen, Medien und Werbung die gewählten Posen beeinflussen.
Ohne Titel (Schwestern) verkörpert die Einflüsse der modernen Medien perfekt. Die jüngere Schwester lehnt kühl an einem Baum. Ihr Blick oszilliert zwischen Gleichgültigkeit und Ernsthaftigkeit.
Ihre Teenager-Schwester hat typische Geschlechterrollen und Schönheitskonzepte bereits verinnerlicht. Dieser direkte Vergleich der beiden Schwestern in einem einzigen Bild zeigt, was der Altersunterschied von ein paar Jahren ausmacht.
Die alte Technik der Nassplattenfotografie verändert die Posen der Modelle. Ich mache nur ein Foto pro Person, keine Wiederholungen. Die Modelle müssen ihre Posen sehr ruhig halten. Dadurch entsteht eine besondere Atmosphäre.
Agnes Prammer
• Agnes Prammer
geb. 1984 in Wien (AT), lebt und arbeitet in Wien
„ohne Titel (Schwestern)“, 2013 aus der Serie „muscles & bones“ pigmentbasierter Tintenstrahldruck (gescannt von original Ferrotypie im Kollodium-Nassplatten-Verfahren), 88 × 66 cm Sammlung SpallArt, Inv. Nr. S-2834, © Agnes Prammer

Colette ist einer der lebenden nationalen Kunstschätze New Yorks. Ihre bahnbrechenden Straßenperformances in den 1970er Jahren brachten diese avantgardistische Kunstrichtung ins Licht der Öffentlichkeit. Ihre wunderschönen Installationen im Fiorucci-Geschäft in der 59th Street in Manhattan, im Clocktower und im PS I wie in Berlin und Rom, verschafften dieser wichtigen künstlerischen Gattung entscheidende Aufmerksamkeit. Und sie hatten einen enormen Einfluss auf die Popkultur – ohne Colette hätten wir zum Beispiel viele Aspekte von Madonna nicht kennengelernt. Ihre verfremdeten Fotografien wurden vielfach ausgestellt und von der Kritik hoch gelobt.
Der Einfluss ihrer Living Tableaux ist in den Werken unterschiedlicher Künstler:innen wie Cindy Sherman (die ihre Fantasiegestalten auf die Zweidimensionalität ihrer Fotografien beschränkt) und Matthew Barney (dessen Verwendung der Mythologie, insbesondere seine Satyr-Imitationen, das Kostümspiel auf eine ähnliche Ebene der Extravaganz hebt) zu spüren. Auch die aufwändig inszenierten Performances der japanischen Künstlerin Mariko Mori scheinen sich in ihrer Aneignung kultureller und mythologischer Ikonen an Colette zu orientieren.
Ihre Figuren sind allegorisch. Sie berufen sich auf eine höchst theatralische Symbolik, um die Sozialgeschichte zu erforschen und Geschlechterklischees zu hinterfragen. Ihr Werk ist eine ständige Auseinandersetzung mit ihrer eigenen persönlichen Geschichte und ihren Assoziationen mit Kunst und Kunstgeschichte. In den letzten drei Jahrzehnten hat Colette zahlreiche Nachbildungen legendärer Frauen inszeniert, darunter Delacroix’ Freiheitsfigur Marianne, Mata Hari (1984 verwandelte die Künstlerin ihre Berliner Wohnung in das Boudoir der verführerischen Spionin) und die Gräfin Reichenbach (1986), eine fiktive Adelige aus der Zeit des extravaganten König Ludwig.
Obwohl Colette in Europa mehr geschätzt wird als in den USA, ist sie dort eine der bedeutendsten und originellsten Künstlerinnen.
Alexandra Anderson-Spivy1
Colettes im Grunde fröhliche Ästhetik feierte Aspekte des Weiblichen in einer Zeit, in der der akademische Feminismus alles für verdächtig erklärte, was konventionell mit der Freude am Mädchensein verbunden ist. Dazu gehören hohe Absätze, Mode und Make-up, aber auch gute Manieren, Eleganz und Romantik. In ihren Stücken wird auch ein ambivalentes Verhältnis zu Häuslichkeit und Mode unterstellt und es werden Fragen zum Wesen der weiblichen Rolle in Kunst und Leben gestellt, ohne dass die Weiblichkeit jemals abgelehnt wird. Durch die Manipulation und Dramatisierung ihrer weiblichen Archetypen verwandelt Colette die Stereotypen ständig in etwas Neues, Provokantes und Glamouröses.
1 Alexandra Anderson-Spivy, 6. März 2007, https://collectcolette.com (aufgerufen am 28.1.2025), übersetzt mit deepL
• Colette geb. in Tunis (TN), lebt und arbeitet New York (US)
„In Bed in Enno“, 1970er Tempera, Lack auf C-Print , 31 × 31 cm
Sammlung SpallArt, Inv. Nr. S-834, © Colette Maison Lumiere


„Die Erschaffung Adams“, 1508–1512
Deckenfresko, Sixtinische Kapelle, Rom
Jan Saudek ist ein tschechischer Fotograf, bekannt für seine oft provokant inszenierten Motive. Er hat eine einzigartige Ästhetik entwickelt, die von den Themen Liebe, Sexualität, Alter und menschliche Zerbrechlichkeit geprägt ist. Viele seiner Fotografien spielen in einer traumähnlichen Atmosphäre und zeigen Figuren in intimen, oft surrealen Szenarien. Saudek ist besonders für seine handkolorierten Schwarz-Weiß-Fotografien bekannt, die eine starke visuelle Wirkung erzeugen.
Alle Bilder der Serie Deep Devotion zeigen eine Frau in sitzender Haltung, die eine von oben kommende nackte Männerhand hingebungsvoll küsst. Die Frauen sind dabei mehr oder weniger bekleidet oder nackt wie in dieser Arbeit Deep Devotion Nr. 363/V. Das Arrangement erinnert an den Ausschnitt Die Erschaffung Adams in Michelangelos Deckenfresko in der Sixtinischen Kapelle (1508–1512). Michelangelo stellt die Verbindung zwischen Gott und Mensch dar, die eine übernatürliche Ebene erreicht. Die Hände sind ein Symbol für Schöpfung, Macht und Perfektion. Saudek reduziert diese Symbolik auf die Verbindung zwischen Mann und Frau, obwohl der Mann nur teilweise erkennbar ist und dadurch auch rätselhaft bleibt. Seine Hände stehen für Hingabe, Macht und Verletzlichkeit in einer imperfekten, intimen Welt. Beide Werke nutzen die universelle Symbolik der Hand, aber während Michelangelo nach dem Göttlichen strebt, feiert Saudek die Menschlichkeit – in all ihrer Schönheit und Zerbrechlichkeit.
Christoph Fuchs
• Jan Saudek geb. 1935 in Prag (CZ), lebt und arbeitet in Prag
„Deep Devotion Nr. 363/V“, 1990 Gelatinesilberabzug, getont, handkoloriert, 39 × 29 cm
Sammlung SpallArt, Inv. Nr. S-840, © Jan Saudek / Bildrecht, Wien

1 Jane Albert, ‚Controversial Photographer Bill Henson Makes His Long-Awaited Return to Sydney‘, in: Broadsheet, 2019, https://www.broadsheet.com.au/sydney/ art-and-design/article/after-seven-years-controversial-photographer-billhenson-makes-his-long-awaited-return-sydney (aufgerufen 18.2.2025)
Bill Henson ist ein renommierter australischer Fotograf, der für seine stimmungsvollen, oft düsteren Bilder bekannt ist. Seine Arbeiten bewegen sich zwischen Malerei und Fotografie, mit einem starken Fokus auf Licht, Schatten und Textur. Besonders charakteristisch sind seine Darstellungen von Jugendlichen in geheimnisvollen, oft urbanen oder naturbelassenen Umgebungen.
Henson nutzt den Chiaroscuro-Effekt von Licht und Schatten, ähnlich wie in der klassischen Malerei, um Dramatik und Tiefe zu erzeugen. Viele seiner Bilder wirken dabei in der Komposition wie barocke Gemälde, zeigen jedoch junge Menschen an der Schwelle zum Erwachsenwerden, in nachdenklichen, melancholischen, sexualisierten oder dystopischen Szenerien und Posen.
Henson war mehrfach in der Kritik, insbesondere wegen der sexualisierten Darstellung von Jugendlichen. Einige seiner Werke wurden als grenzwertig wahrgenommen, insbesondere eine 2008 beschlagnahmte Ausstellung in Sydney.1 Nach einem öffentlichen Diskurs wurde die Ausstellung jedoch wieder freigegeben, und die Arbeiten gelten als kunstvolle Erkundungen von Identität und Körperlichkeit.
Eine Gruppe von Jugendlichen verbrachte den Sommer 1992 selbstbestimmt und freizügig inmitten der Wracks eines Autofriedhofs. Die dabei entstandenen Bilder, wie viele von Hensons Werken, sind unbetitelt. Er nummeriert sie, um den Fokus auf die Bildsprache zu lenken.
Christoph Fuchs
• Bill Henson
geb. 1955 in Mellbourne, lebt und arbeitet in Melbourne (AU)
ohne Titel (4T M.D. SM 33 N.29 A), 1992–1993
C-Print, 189 × 126 cm
Sammlung SpallArt, Inv. Nr. S-2617, © Bill Henson

Anstatt den Körper in seiner Ganzheit zu zeigen, konzentrieren sich diese Aufnahmen auf einzelne Teile, wie beispielsweise die Hände, Füße oder das Gesicht. Diese fragmentierte Sichtweise zeigt Blickwinkel auf, die das Gewohnte verfremden und den Fokus auf die Details lenken.
Körperfragmente erzählen Geschichten, ohne den gesamten Kontext preiszugeben. Ein isolierter Blick auf eine Hand kann Stärke oder Zärtlichkeit vermitteln, während ein Ausschnitt eines Gesichts Emotionen wie Trauer oder Freude in konzentrierter Form ausdrücken kann. Diese Bilder fordern die Vorstellungskraft der Betrachter:innen.
Künstler:innen nutzen die fragmentarische Darstellung, um die Beziehung zwischen Körper und Identität zu hinterfragen. Der Körper wird dekonstruiert, in Formen, Linien und Texturen
aufgelöst, wodurch neue ästhetische Möglichkeiten entstehen. Gleichzeitig betont diese Herangehensweise die Anonymität und Universalität des Körpers, indem sie individuelle Merkmale in den Hintergrund rückt.
In der zeitgenössischen Fotografie dient die Fragmentierung oft dazu, Themen wie Gender, Körpernormen oder Verletzlichkeit aufzugreifen. Die Abstraktion durch Fragmente wird zum Mittel, um Fragen nach Ganzheit, Verlust und Transformation zu stellen.
Dadurch entstehen neue Erzählungen, die uns die Schönheit und Vielschichtigkeit des Körpers auf überraschende Weise näherbringen. Sie zeigt, wie das Fragment zum Schlüssel werden kann, um das Ganze neu zu verstehen.
Cäcilia Steinkellner
1 vergleiche dazu:
Eine Aufnahme des Rückens von Neil Weston im Alter von neun Jahren. Neil Weston (1916–1998), der dritte der vier Söhne von Edward und Flora Weston, war in den frühen 1920er Jahren eines der Lieblingssujets seines Vaters, vielleicht weil er, wie Edward in seinem Tagebuch schrieb „absolut natürlich und unbewusst vor der Kamera“ war. Edward zufolge schien Neil nackt „am meisten er selbst zu sein“. So spielte Neil zwischen 1922 und 1925 mehrfach die Muse für das wachsende Interesse seines Vaters an Aktstudien.
Die Bilder von Neil sollten sowohl als Familienerbstücke als auch als ästhetische Aussagen dienen, die mit anderen Künstlern geteilt werden konnten.1
Dieser Rückenakt lebt nicht nur von der Binnenstruktur des Körperfragments mit seiner haptischen Qualität, sondern vielmehr vom eigenwilligen Bildausschnitt, der eine besondere Spannung zwischen den schwarzen Flächen im Hintergrund und der hellen Fläche des Körpers erzeugt.
Dieses Bild ist ein früher Abzug von Cole Weston, der nach dem testamentarischen Willen und der Anleitung Edwards Abzüge der Originalnegative seines Vaters fertigte. Auf der Rückseite ist das Bild mit Hand signiert, ab etwa 1970 verwendete Cole einen Stempel (Negative by Edward Weston, Print by Cole Weston).
Christoph Fuchs
• Edward Weston
geb. 1886 in Highland Park (US), gest. 1958 in Carmel (US)
„Nude“, 1925 (Abzug 1960er von Cole Weston) Gelatinesilberabzug auf Karton, 23 × 17 cm
Sammlung SpallArt, Inv. Nr. S-223, © Arizona Board of Regents, Center for Creative Photography


• Kleomeles der Athener
„Statue des Marcellus“, 1. Jhd. Louvre, Paris
Die Werke des amerikanischen Fotografen Ralph Gibsons stellen einen bewussten Bruch mit der traditionellen Auffassung von Fotografie als präzises Mittel zur Dokumentation der Realität dar. Statt die Welt detailgetreu abzubilden, betrachtet er die Fotografie selbst als eine eigenständige ästhetische Realität. Ein zentrales Motiv seines Schaffens liegt in der ursprünglichen Bedeutung des Begriffs Fotografie, dem Zeichnen mit Licht. Dabei dient Licht für Gibson nicht nur als essenzielle Voraussetzung für das Medium, sondern wird selbst zum gestalterischen Element und Untersuchungsgegenstand, ebenso wie der Schatten, als Gegenpart.
Neben intensiven Schwarz-Weiß-Kontrasten, die seinen Bildern eine abstrakte Wirkung verleihen, spielt die präzise Wahl des Bildausschnitts eine entscheidende Rolle. Durch die bewusste Selektion seiner Motive, entstehen Fragmente der Wirklichkeit, die geheimnisvoll und rätselhaft bleiben. Auf den ersten Blick scheinen seine Bilder aufgrund ihrer klaren grafischen Komposition schnell erfassbar. Doch genau in dieser scheinbaren Deutlichkeit liegt eine tiefere Vieldeutigkeit verborgen: Gibsons Werke verweigern sich einer eindeutigen Lesart und entfalten stattdessen eine surreale, traumhafte Rätselhaftigkeit, die sich der konkreten Verortung entzieht. Es bleibt ein Rätsel, ob es sich im Bild tatsächlich um eine Statue handelt.
Auf dem Beiblatt zur Mappe der Serie Artefacts schreibt Gibson: Photographs then too become artifacts in their own right … concrete evidence of a fixed gesture or mood emanating from certain objects … a low frequency hum. Therefore: art + factus = photography.
Christoph Fuchs
• Ralph Gibson
geb. 1939 in Los Angeles (US), lebt und arbeitet in New York (US)
„Marcellus, Louvre, Paris“, 1984 aus der Serie „Artifacts“
Gelatinesilberabzug, 31 × 20 cm
Sammlung SpallArt, Inv. Nr. S-261, © Ralph Gibson


• Ralph Gibson
geb. 1939 in Los Angeles (US), lebt und arbeitet in New York (US)
ohne Titel, 1982
aus der Serie „Infantagravure“
Heliogravur, 14 × 21 cm
Sammlung SpallArt, Inv. Nr. S-352, © Ralph Gibson
Von Zeit zu Zeit interessierte sich Fritz Simak auch für seinen eigenen Körper. In jungen Jahren, mit Anfang 20, gut gebaut und muskolös, gibt es einige Aufnahmen dazu. Besonderes Interesse entwickelt er dabei für die Schlüsselbein-Partie. Im Kunsthistorischen Museum in Wien findet er dazu im Gemälde Dornenkrönung
Christi, 1601 von Michelangelo Merisi (Caravaggio genannt, 1571–1610) ein interessantes Phänomen: „Wird ein Körper in einem dunklen Raum allein von einer kleinen, aber starken Lichtquelle beleuchtet, so treten nicht nur helle, halbschattige und schattige Partien zum Vorschein; vielmehr wird der eigene Körper selbst zur Lichtquelle und beleuchtet die im Vollschatten liegenden Stellen. Der Hals in vollem Licht reflektiert zur Schlüsselbeinpartie und erhellt sie damit ein wenig.“1
Vergleiche dazu Ralph Gibsons Aufnahme, der denselben Ausschnitt der Schulter mit Schlüsselbein zeigt. Bei Gibson wird dieser Körperteil jedoch durch das weiche Licht, sowie durch die Anwendung der Technik der Fotogravur zu einem abstrakten flächigen Gebilde. Im Gegensatz zu Simak, wo die Körperformen durch das harte Licht besonders in ihrer Plastizität hervorgehoben werden.
Christoph Fuchs
• Fritz Simak
geb. 1955 in Wien (AT), lebt und arbeitet in Wien und Niederleis (AT)
„Körperlandschaft“, 1978
Gelatinesilberabzug auf Karton, 23 × 35 cm
Sammlung SpallArt, Inv. Nr. S-264, © Fritz Simak / Bildrecht, Wien


• Josephus Daniel
unbekannt
„Figure“, 1986
Gelatinesilberabzug, 14,8 × 20,9 cm
Sammlung SpallArt, Inv. Nr. S-2784, © Josephus Daniel
• Lucien Clergue
geb. 1934 in Arles (FR), gest. 2014 in Nimes (FR)
„Les Gèautes, Camargue“, 1978 ( Abzug 1990)
Gelatinesilberabzug, 24,4 × 35,9 cm
Sammlung SpallArt, Inv. Nr. S-2814, © Atelier Lucien Clergue

Auf ironisch-spielerische Art vereint Anna Jermolaewa in diesem kurzen, geschmeidig geschnittenen Video zwei der beliebtesten Klischees erotischer Männerfantasien: schöne Frauen und schnelle Autos. Weitab von Bildern, die durch mediale Vermarktungsstrategien geprägt sind, kurvt in Jermolaewas Video ein roter SpielzeugSportwagen über die sanften Hügel weiblicher Körperlandschaften und vermisst so Stück für Stück den Frauenkörper in einer Endlosschleife. Durch die fragmentierte Sicht des Leibes und den Verzicht auf eine Personalisierung durch das Zeigen des Gesichtes entzieht sich das Video ganz bewusst der erwarteten Sexualisierung und verharrt spielerisch im sinnlichen „Erfahren“ der Körpergrenzen.
Alexandra Hennig
• Anna Jermolaewa
geboren 1970 in St. Petersburg (RU), lebt und arbeitet in Wien (AT)
„Kurvenreich“, 2002
Video (DVD), 3 min, loop
Sammlung SpallArt, Inv. Nr. S-975, © Anna Jermolaewa / Bildrecht, Wien




Der Schwerpunkt der Arbeit von Alessa Grande ist die „Entfaltung und Enthüllung des authentischen Selbst“ und „die Symbiose von Gegensätzen“. Ihr größtes Interesse gilt dabei dem Menschen, dessen innere Welt sie erforschen und mit der äußeren Welt teilen möchte. Ihre Werke sind intuitiv, emotional, direkt und unverblümt. Sie nutzt die Nacktheit als zentrales und wiederkehrendes Element in ihren Arbeiten. Die Nacktheit in Grandes Werken verkörpert eine vielschichtige Symbolik, die eng mit ihrer künstlerischen Vision verknüpft ist. Für die Künstlerin ist der nackte Körper ein Symbol für Freiheit und Authentizität. In einer Welt, in der Menschen oft gezwungen sind, sich den Erwartungen anderer anzupassen und verschiedene Rollen zu spielen, steht der nackte Körper in ihrer Kunst für die Ablegung von Masken und Fassaden. Er repräsentiert die reine, unverfälschte Natur des Menschen, die sich jenseits gesellschaftlicher Normen und Konventionen entfaltet.
Durch die Darstellung von nackten Körpern, die sowohl Kraft als auch Zerbrechlichkeit, sowohl Sinnlichkeit als auch Stärke ausstrahlen, erforscht Grande auch die fließenden Grenzen zwischen Geschlechtern und Identitäten. Grande betrachtet die Nacktheit als direkten Ausdruck einer befreiten Seele. In ihren Fotografien wird
der nackte Körper zu einer Leinwand, auf der die inneren Emotionen, Gedanken und Träume des Menschen sichtbar werden. Diese Darstellung erlaubt es dem Betrachter, sich mit der inneren Welt des Dargestellten zu verbinden und fördert ein tieferes Verständnis der menschlichen Erfahrung.
Ihre Bilder laden die Betrachter:in ein, eigenen Vorstellungen von Nacktheit, Scham und Schönheit zu hinterfragen und sich auf eine ehrliche Auseinandersetzung mit dem menschlichen Körper einzulassen. Durch diese Herangehensweise schafft Grande eine Plattform für Diskussionen über die Rolle von Nacktheit in Kunst und Gesellschaft.
Die Nacktheit in den Werken von Alessa Grande ist viel mehr als ein künstlerisches Element. Sie ist ein Schlüssel zur Erforschung der tiefsten Schichten des menschlichen Daseins. Durch die bewusste und einfühlsame Darstellung nackter Körper schafft Grande Räume, in denen das authentische Selbst sichtbar wird. Ihre Kunst lädt uns ein, die Schönheit und Komplexität der menschlichen Existenz in all ihren Facetten zu entdecken und zu feiern.
Leica Galerie, Salzburg
• Alessa Grande geb. 1989 in Salzburg (AT), lebt und arbeitet in Salzburg
„Ukiyo 浮世 – The floating world“, 2024 pigmentbasierter Tintenstrahldruck, 90 × 60 cm Sammlung SpallArt, Inv. Nr. S-2788, © Alessa Grande

Eine wesentliche Werkgruppe in den 1970er Jahren bilden die zärtlich-poetischen Arbeiten von Renate Bertlmann. In ihnen entwickelt sie abstrahierte und reduzierte Formen für innige Empfindungen einer zärtlichen Körperlichkeit. In den Zeichnungen mit dem Titel Berührungen von 1974 bilden zart schattierte Umrisslinien organische Formen, Formen, die sich berühren und umschlingen. Ein Äquivalent zu diesen findet Renate Bertlmann in aufgeblasenen
Präservativen und Latexschnullern. Durch die Art der Verwendung, einen gezielt auf die weiche Materialität der Oberfläche gelenkten Blick und die Titel der Werke, werden diese Gegenstände zum Synonym für Zärtlichkeit. Ihre Zugehörigkeit zu den Sphären des Sexuellen und Kindlichen fügt der abstakten Sicht der Zeichnungen eine weitere Bedeutungsebene hinzu, lässt Sexualität, Verhütung, Mutterschaft und kindliche Erfahrungen mitschwingen. Ab 1975 entsteht eine große Anzahl an Schnuller- und Präservativarbeiten: Aufgeblasene Präservative in Glasbehältern, die leicht aneinander
liegen, inklusive Anleitung zum Aufblasen bei „Erschlaffen“, Schnullermatten und -objekte mit eingedrückten und ausgestülpten Saugern, die sich als weibliche und männliche Genitalien lesen lassen, die Fotoserie und der Film Zärtliche Berührungen, die die aufgeblasenen Enden zweier sich liebkosender und schlussendlich penetrierender Kondome zeigen, Zärtliche Hände, ein Zärtlicher Christus mit einer Dornenkrone aus Schnullern, die erste Serie inszenierter Fotografien Zärtliche Pantomime, die die maskierte Künstlerin in intimer Beschäftigung mit sich selbst und ihrer Sexualität zeigt. Gleichzeitig versieht Renate Bertlmann Schnuller und Kondome in anderen Objekten und Zeichnungen mit Skalpellen und erzeugt damit Bilder einer Verweigerung und einer aggressiven Wehrhaftigkeit angesichts der Verletzlichkeit der zarten Intimität sowie Bilder einer aggressiven Sexualität. Magdalena Felice1
1 aus: Magdalena Felice, „Love & Sex. Renate Bertlmanns Kunst der 1970er Jahre“, 2009 (https://bertlmann.com/pdf/felice_d.pdf, aufgerufen 30.1.2025)
• Renate Bertlmann geb. 1943 in Wien (AT), lebt und arbeitet in Wien
„Zärtliche Berührungen“, 1976 (Abzug 2018)
C-Print, 30 × 45 cm
Sammlung SpallArt, Inv. Nr. S-2125, © Renate Bertlmann / Bildrecht, Wien


Erst mit 60 Jahren begann der Kunstkritiker und Kurator John Rivers
Coplans einen neuen Lebensabschnitt als Fotograf und Künstler und beschäftigte sich jahrelang mit seinem eigenen, nun alternden und keineswegs den gängigen Vorstellungen eines Aktmodells entsprechenden Körper.
Fritz Simak
• John Rivers Coplans geb. 1920 in London (GB), gest. 2003 in New York (US)
„Soles of Feet“, 1985
Gelatinesilberabzug, 29 × 36 cm
Sammlung SpallArt, Inv. Nr. S-445, © John Rivers Coplans Estate •

In ihren intimen und anrührenden Porträts und Körperdetails nackter Menschen sucht Mona Kuhn nach dem Selbstbild ihrer Modelle. Viele der Fotografien entstanden im Sommer in einer Kommune in Frankreich, aber auch in ihrer Heimat Brasilien.
Durch die Konzentration auf die Hände im Vordergrund bekommen diese ein dynamisches Eigenleben und werden dadurch als Kleinskulptur wahrgenommen. Die expressive Haltung der Finger steht im Gegensatz zu der klaren und einfach lesbaren Umrandung durch den Körper dahinter.
Fritz Simak
Mona Kuhn
geb. 1969 in São Paulo (BR), lebt und arbeitet in Los Angeles (US)
„Menta“, 2000
aus der Serie „Entangled“
Gelatinesilberabzug, 37 × 37 cm
Sammlung SpallArt, Inv. Nr. S-XXX, © Mona Kuhn

Auf der menschlichen Hautoberfläche existieren Bakterienkulturen unterschiedlichster Art. Indem ich meinen Körper in einer Agarnährlösung abdrücke, werden meine körpereigenen Bakterien übertragen und wachsen nach einigen Tagen so meine Körperkonturen nach. Auf diese Weise entsteht ein biologisches Abbild meines Körpers durch meinen Körper.
Diese naturwissenschaftliche Versuchsanordnung wird anschließend unter einer speziellen Beleuchtung fotografisch dokumentiert und in einen Bilderkontext überführt. Die gewachsenen Bakterienbilder selbst müssen aufgrund der Entwicklung toxischer Stoffe sorgfältig vernichtet werden.
Edgar Lissel
• Edgar Lissel
geb. 1965 in Northeim (DE), lebt und arbeitet in Wien (AT)
„Myself (Hand)“, 2005 pigmentbasierter Tintenstrahldruck auf Alu-Dibond, 80 × 80 cm
Sammlung SpallArt, Inv. Nr. S-434, © Edgar Lissel
Durch Eindrücken seiner linken Hand in einen mit warmem Teer gefüllten Eimer, erzielt Todd Watts de facto einen Abdruck seiner Hand, also ein konkaves Gebilde. Für die Betrachter:in jedoch kann der Abdruck konkav oder konvex gelesen werden. Ein Vexierbild also, das gänzlich ohne Manipulation durch den Künstler von selbst entstanden ist.
Fritz Simak
• Todd Watts geb. 1949, lebt und arbeitet in Blanchard (US)
„The Left Side“, 1973
Gelatinesilberabzug auf Karton, 100 × 70 cm
Sammlung SpallArt, Inv. Nr. S-428, © Todd Watts

Über den britischen Fotografen John Everard ist nicht viel bekannt. Sein bürgerlicher Name ist Edward Ralph Forward. Er diente bei der britischen Infanterie im Ersten Weltkrieg und nahm nach dem Krieg eine Stelle in Malaysia an, um für die American Rubber Co. eine Kautschukplantage zu leiten. Während eines Urlaubs in der Schweiz lernte er 1928 Kathleen Stanley aus Margate kennen, die er noch im selben Jahr heiratete. Nach seiner Rückkehr nach England im Jahr 1932 wurde er als Aktfotograf bekannt. Sein erstes Buch Adam’s Fifth Rib wurde 1935 veröffentlicht.
Der Autodidakt Everard war Mitglied des British Institute of Professional Photography (fbipp) und hatte ein Studio in London. Trotz seines Alters gelang es ihm, sich zu Beginn des Zweiten Weltkriegs als offizieller Fotograf bei der Royal Air Force zu melden. Er überlebte zwei Abstürze und wurde 1946 in Durban entlassen, wo er mit seiner Frau und zwei Kindern zu dieser Zeit lebte.
Er veröffentlichte zahlreiche Fotobücher hauptsächlich mit Aktfotografien. Im Jahr 1963 darauf wurde sein letztes Buch Model in Shadow veröffentlicht. Man nimmt an, dass er im Dezember 1964 an Krebs starb.
Christoph Fuchs
• John Everard
geb. 1898 in Kingston Upon Hull (GB), gest. 1964 in GB
ohne Titel, 1950er
Gelatinesilberabzüge auf Karton, 26 × 33 cm
Sammlung SpallArt, Inv. Nr. S-643, © John Everard

Siegfried Enkelmann kam nach eigener Aussage 1921 nach Berlin. Er arbeitete von 1927 bis 1929 als Gehilfe im, auf Reklamefotos spezialisierten, Fotoatelier von F. H. Nolte und war anschließend Mitarbeiter im Atelier von Hans Robertson. Hier arbeitete er vor allem als Tanz- und Porträtfotograf.
Nach der Machtergreifung der Nationalsozialisten wurde Hans Robertson als Jude aus dem Landesverband Berlin der Bildberichter ausgeschlossen und entschloss sich, nach Dänemark zu emigrieren. Daher übergab er sein Atelier im Juni 1933 mit seinem Negativarchiv an Enkelmann. Das Archiv enthielt auch den zuvor von Robertson mit der Übernahme des Ateliers von Lili Baruch erhaltenen Bestand. Enkelmann arbeitete noch kurze Zeit unter Robertsons Namen weiter, um das Atelier dann ab 1935 unter eigenem Namen mit seiner späteren Ehefrau, der von Robertson ausgebildeten jüdischen Fotografin Irene Krämer fortzuführen. Nach der Zerstörung von Wohnung und Atelier bei einem Luftangriff lebten und arbeiteten Enkelmann und Krämer ab 1942 bei dem Fotografen Hans Rama.
wikipedia
• Siegfried Enkelmann
geb. 1905 in Krasnopol (BY), gest. 1978 in München (DE)
ohne Titel, 1950er
Gelatinesilberabzug, 31 × 22,2 cm
Sammlung SpallArt, Inv. Nr. S-2826, © Siegfried Enkelmann / Bildrecht, Wien

1
Jan Pieter Ekker, in: „Het Parool“, 14.7.2022, Amsterdam (https://www.bildhalle.ch/usr/documents/press/download_url/ 103/14.07.22-parool-nl.pdf, aufgerufen 30.1.2025), übersetzt mit deepL
„Ich löse alles aus dem Zusammenhang, sammle, arrangiere neu, setze lose Teile zusammen, mische Materialien und Techniken. Ich schaffe meine eigene Ordnung aus dem Chaos des Überflusses. Ich bin eine Flaneurin. Deshalb lebe ich auch in der Stadt. Ich liebe es, Menschen zu studieren, Gesichter, Gesten, Bewegungen. Die Natur gibt mir den Horizont. Sei naiv in allem, was du tust. Die Bilder sind da – man muss nur zuhören.“
Miriam Tölke
Als die deutsche Fotografin Miriam Tölke zu Beginn dieses Jahrhunderts ihr Studium an der Staatlichen Akademie der Bildenden Künste in Stuttgart aufnahm, begann sie ausrangierte Dinge zu sammeln: Zeitschriften, Hefte, Bücher, Kataloge. Mit diesen Fundstücken, Papierschnipseln, losen Blättern und Fragmenten aus ihrem angesammelten Fotoarchiv begann sie, Collagen zu erstellen. Gesichter werden halbiert und mit Teilen von anderen Gesichtern und Landschaften kombiniert, die den Frieden und die Harmonie der Natur widerspiegeln. Fotos aus Hochglanz- und Modemagazinen werden mit Bildern verschmolzen, die die hektische Anonymität ihrer geschäftigen, überfüllten Heimatstadt Berlin ausdrücken. So entstehen „spirituelle Landschaften“, die sowohl den Zeitgeist als auch Tölkes poetische Denkweise widerspiegeln.
Jan Pieter Ekker1
• Miriam Tölke
geb. 1977 in Bielefeld (DE), lebt und arbeitet in Berlin (DE)
„Transformation“, 2000
pigmentbasierter Tintenstrahldruck, 72 × 55,5 cm
Sammlung SpallArt, Inv. Nr. S-2876, © Miriam Tölke

Im Jahr 2017 habe ich die Collage als Medium für mich entdeckt. Durch meine Arbeit in der Suchthilfe, war und bin ich viel in den Straßen Berlins unterwegs. Ich habe schon immer gerne fotografiert, allerdings erschien mir das Ergebnis meines Fotografierens immer zu nah an der abgebildeten Realität; mir fehlte das spielerische Element. Irgendwann habe ich angefangen, zunächst meine eigenen Fotos und später zufällig gefundenes Material zu zerschneiden und neu zusammenzusetzen. Als kreative Ausdrucksform erschien mir das direkter und unmittelbarer als meine Fotografien. Ich interessiere mich für Papier als haptisches Material, vielleicht weil ich durch meine Ausbildung als Handweberin einen textilen Hintergrund habe. Ich löse Bildelemente aus ihrem Kontext, schneide, reiße, verschiebe sie, bis in einer Montage verschiedener Komponenten ein einheitliches Bild entsteht, das eine neue Geschichte erzählt. Ein wesentlicher Teil des kreativen Prozesses ist hierbei, im wahrsten Sinne des Wortes: mit dem Zufall spielen. Manchmal scheinen die Blätter von selbst an ihren Platz zu fallen.
Unser Leben ist zu einer kontinuierlichen Collage aus allen möglichen Elementen geworden. Wir leben in einer Welt, in der wir von bildlichen Reizen überflutet werden, in der sich die Grenzen zwischen Wahrheit und Lüge zunehmend auflösen. Die Collage vermag es, in spielerischer Natur, unterschiedliche Referenzen zusammenzuführen. Oftmals geht es hierbei um die Spannung zwischen Figurativem und Abstraktem. Die Irritation, die hieraus entsteht, ist das, was die Collage in ihrem Ergebnis erst anregend macht.
Jede Bildquelle hat ihre Geschichte, ist durch die Zeit entstanden, ob sie nun gebleicht, zerknittert, nass geworden, zerrissen ist – oder anderes. Das gefundene Material entscheidet den Prozess des Zusammenfügens wesentlich mit. All dies sind anregende Merkmale der analogen Arbeit: Ich nehme es, wie es kommt!
Die Schönheit der Collage besteht in ihrer Fähigkeit, einen fruchtbaren Boden für vielfältige Interpretationen zu bieten. everything includes nothing!
Ismene Grebe
• Ismene Grebe
geb. 1973 in Herdecke (DE), lebt und arbeitet in Berlin (DE)
„Jokers we know“, 2019
Fotocollage auf Papier, 42 × 29,7 cm
Sammlung SpallArt, Inv. Nr. S-2737, © Ismene Grebe

1 Elfriede Mejchar, in: Alfred Fogarassy (Hg.), „21. Reportagen. Betrifft: Fotografien. Nora Schoeller. Interviews von Ruth Horak“, Salzburg 2008, S. 125
2
Ruth Horak, ‚Vom Zusammenfall der Gegensätze in der Phantasie – Elfriede Mejchars Arbeiten aus dem Atelier‘, in: „Elfriede Mejchar. Fotografie“, Weitra 2014, S. 142ff
Elfriede Mejchars Schere stellt frei und trennt Umrisse so lange von der Fläche, bis sich etwa eine Hand verschieben lässt und schwarze Spuren über das Dekollete zieht. Der Akt des Herauslösens, Herausreißens, Verschiebens oder Vertauschens stört die ursprüngliche Perfektion, eine Kollision verschiedener Elemente, die bis dahin in keiner gemeinsamen Einheit steckten, findet statt – wie sie charakteristisch für die Collage ist: Ein Kopf schwebt körperlos vor schwarzem Grund, ein Leopard hat seine Pranke in einem Auge versenkt, ein Mund spuckt Worte, ein anderer schluckt ein Auge. Mann und Frau treffen aufeinander, schwarz und weiß. Gesichter verformen sich zu flachen Masken, durch deren Öffnungen der Hintergrund dringt, offene und geschlossene Augen wechseln einander ab oder werden von einem dritten Über-Auge überragt, das aber weniger als moralische Instanz, denn als forderndes Es agiert. Haben Augen und Mund das Gesicht endgültig verlassen, tummeln sie sich etwa vor einer Mauer. „Ich baue mir Bilder an der Wand, aus Materialien, die in der Öffentlichkeit liegen, aus dem, was öffentlich hergezeigt wird, entblöße aber die makellose Schönheit, die uns immerfort als Ideal unter die Nase gehalten wird, indem ich sie zerstückle oder verdecke. Es sind böse Collagen. Kurzfristige, lustvolle Eingriffe, die nach dem Abfotografieren wieder dahin sind.“1 Sämtliche der rund 300 Collagen sind nur gelegt oder lose zusammengesteckt und werden nach dem Fotografieren wieder auseinandergenommen, einzelne Elemente wie eine grüne Schlange oder eine Hand mit Pistole bleiben im Repertoire, andere werden schlicht entsorgt.
Ruth Horak2
Elfriede Mejchar
geb. 1924 in Wien (AT), gest. 2020 in Wien
ohne Titel, 2001 aus der Serie „Nobody is perfect“ Gelatinesilberabzüge, 21 × 17,3 cm
Sammlung SpallArt, Inv. Nr. S-2738, © Elfriede Mejchar Nachlass

Warhols Dokumentationen von glamourösen Selbstdarsteller:innen aus dem internationalen Jet Set und dem Umkreis der Factory zitiert Robert Zahornicky, wenn er in der Serie Puzzle Polaroids zu hybriden Ansichten von Menschen aus seinem Bekanntenkreis collagiert. „Kati B.“, die sich als Mannequin an-, um- und auszieht, zelebriert die Lust an der Inszenierung des Selbst. Aus den separaten Aufnahmen einzelner, unterschiedlich bekleideter Körperpartien fügt der Künstler anschließend die vielteilige Ansicht eines ganzen Menschen zusammen. Jede Partie ist (im Gegensatz zur unbewussten Wahrnehmung) gleichberechtigt im Fokus. Als Nahtstelle der einzelnen Darstellungen trennt der weiße Rahmen der Polaroids und eint doch gleichzeitig die Fragmente zum Bild einer differenzierten Persönlichkeit. Das Individuum erscheint als ein vielgestaltiges Wesen, das sich nicht in einem einzigen fotografischen Moment vermittelt. Identität wird bereitwillig zur gespielten Rolle.
Barbara Lauterbach
• Robert Zahornicky
geb. 1952 in Wien (AT), lebt und arbeitet in Pressbaum (AT)
„Puzzle“, 1985
Sofortbilder (Polaroid) auf Karton, je 45 × 17 cm
Sammlung SpallArt, Inv. Nr. S-1154 und S-1155, © Robert Zahornicky / Bildrecht, Wien


Könnte nicht alles auch ganz anders sein? Wie kann man sich „auf die Suche nach dem richtigen Bild“ begeben, und wann ist ein Bild „richtig“? Wir kennen zwar Bilder, die als „wahr“ gelten, das sind Ikonen mit dem Antlitz Jesu Christi. Aber ist das, was der österreichische Künstler Bernhard Hosa aus Versatzstücken zusammengesetzt hat, überhaupt ein Gesicht? Das menschliche Gesicht ist ein Urtext, dessen Merkmale Augen, Nase und Mund unendlich variantenreich sind. Wir haben gelernt, diesen Text zu lesen. Darüber ist uns das Gesicht zum Repräsentanten der Person geworden, denn wir sprechen nicht zu einem Knie oder einer Hüfte, sondern schauen unserem Gegenüber ins Gesicht, um seine Emotionen zu entschlüsseln.
Das Porträt stellt eine Art Königsdisziplin der Fotografie dar. Denn das fotografische Porträt beweist die Existenz eines Menschen, ein Umstand, der innerhalb der Menschheitsgeschichte einzigartig ist. Ihm kommt ein unschätzbarer ideeller Wert zu. Aber die Fotografie besitzt noch ein zweites Gesicht.
So großartig ihre Rolle als dokumentarisches Medium auch ist, verdingte sie sich doch in der Frühzeit ihrer Entwicklung schon als Agentin der Macht. Diese Fotocollagen thematisieren das von Alphonse Bertillon in den 1880er Jahren entwickelte anthropometrische System zur Personenidentifizierung. Es handelt sich um
eine erste Form von Gesichtserkennung, die zunächst als Hilfsmittel der Kriminologie gedacht war. Bertillon nutzte es aber auch 1894 während des Prozesses gegen Alfred Dreyfus, um in seinem Gutachten einen falschen Verdacht auf den Angeklagten zu lenken.
Bernhard Hosa durchkreuzt jede Möglichkeit einer Personenfahndung, indem er sein dokumentarisches Material zerschneidet. Eine anarchische Geste, die umso brutaler wirkt, als die Bruchstücke grob wie eine eilig versorgte Wunde aneinander getackert wurden. Wir sehen weder Augen noch Nase oder einen Mund, dafür aber ein Ohr. Statt dem Blick, mit dem uns die Porträtierten üblicherweise anschauen, rückt die Akustik ins Zentrum der Aufmerksamkeit. Hier ist offenbar jemand ganz Ohr auf das, was wir zu sagen haben. Hosa verhehlt nicht, dass es sich bei seinem nur noch ungefähr als Kopf zu erkennendem Gebilde um eine Collage handelt. Die Collage ist nicht wie das Foto dem Moment geschuldet und damit immer an die Realität der Gegenwart ihrer Entstehung gekettet. Dass sie etwas Gemachtes ist, zeigen uns ihre sichtbaren Schnittkanten. Die Collage will interpretiert werden, auch wenn sie sich gegen alle Konzepte sträubt, die Bedeutung generieren, wie diese Fotocollage, die uns im Titel schon auf die Fragwürdigkeit von Kategorien wie „richtig“ und „falsch“ verweist.
Thomas Linden1 1
Ausschnitt aus Thomas Linden, „Bernhard Hosa: Auf der Suche nach dem richtigen Bild. Der Essay zum Bild“, 2024, https://www.sammlung-spallart.at/ z/files/Diverse/S_1331_BernhardHosa-Auf%20der%20Suche%20nach%20 dem%20richtigen%20Bild.pdf
Bernhard Hosa
geb. 1979 in Amstetten (AT), lebt und arbeitet in Wien (AT)
„Auf der Suche nach dem richtigen Bild“, 2011 pigmentbasierter Tintenstrahldruck auf Karton auf Holz-Mehrschichtplatte, 39 × 29 cm
Sammlung SpallArt, Inv. Nr. S-1331, © Bernhard Hosa / Bildrecht, Wien

Das Geheimnis des Gesichts1
Das menschliche Gesicht ist ein ganz besonderer Körperteil. Jedes Gesicht verfügt über dieselben Komponenten, jedoch sind diese in ihrer ähnlichen Anordnung so nuanciert, dass kaum jemals eines dem anderen gleicht. Darüber hinaus – so bemerkt der Psychiater, Verhaltensbiologe und Neurowissenschaftler Eric Kandel – können wir uns im Vergleich zu einem vergrößerten Fingerabdruck Hunderte oder sogar Tausende Gesichter einprägen und diese in Sekundenbruchteilen wiedererkennen.2 Es ist uns selbst unmöglich, unser eigenes Gesicht direkt zu betrachten, sondern wir sind angewiesen auf Spiegel, Abbilder oder Beschreibungen. Somit ist unser Eindruck davon stets ein indirekter. Wir tragen ein Gesicht und dieses Tragen ist ein „vor sich Hertragen“3. „Ich trage es vor mir her wie ein Geständnis, von dem ich nichts weiß, und es sind im Gegenteil die Gesichter der anderen, die mich über das meine belehren.“4 „Man schlüpft eher in ein Gesicht hinein, als dass man eines besitzt.“5 Wir lesen in Gesichtern, fühlen uns zu den einen hingezogen, lehnen andere wiederum ab. Sie können uns unter Drogeneinfluss oder im Wahn entgleiten, wir haben Angst, unser eigenes zu verlieren, oder wollen uns in anderen Gesichtern
verlieren, wie Roland Barthes die Wirkung des Abbilds Greta Garbos schildert, in dem die Menschen sich verloren „wie in einem Liebestrank“. Ihr Gesicht scheint wie ein organischer, „absoluter Zustand“6, der zugleich Anziehungskraft und Unerreichbarkeit ausstrahlt. Das Gesicht ist, so Jean-Paul Sartre, „natürlicher Fetisch“7. Es ist, bevor es zum Bedeutungsträger wird, eine weiße Fläche, in die man Bedeutungen einschreibt. Das bewegungslose Gesicht ist zunächst Ding und nichts als eine Projektionsfläche – eine weiße Wand8 –, doch keineswegs eine zweidimensionale, wenn man erst beginnt, „schwarze Löcher“9 hineinzuschneiden, und dadurch eine Tiefendimension entsteht. Das Gesicht ist mehrdimensional, opak und polyphon. Ein Typus kann „wie eine durchschimmernde Maske ein ganz anderes, verborgenes Gesicht allmählich durchblicken lassen“10. Eine Miene wird nach und nach in eine andere übergeblendet. Wie in der Musik hallt im gegenwärtigen Ausdruck noch der vergangene nach, während bereits ein zukünftiger hineindringt. Das Gesicht zeigt nicht nur „die einzelnen Seelenzustände, sondern den geheimnisvollen Prozess der Entwicklung selbst“11. Ein menschliches Gesicht existiert nicht einfach wie jenes eines Tieres, sondern es entsteht.
1 Karin Fisslthaler, „I‘ll be Your Mirror. Mediale körperliche Konstruktionen als selbstrefelktive Techniken“, Harpune Verlag 2019
2 Vgl. Eric Kandel, „Das Zeitalter der Erkenntnis. Die Erforschung des Unbewussten in Kunst. Geist und Gehirn von der Wiener Moderne bis heute“, München 2012, S. 335
3 Vgl. Gilles Deleuze, Félix Guattari, „Tausend Plateaus: Kapitalismus und Schizophrenie“, Berlin 2005.
4 Christa Blümlinger, Karl Sierek (Hg.), „Das Gesicht im Zeitalter des bewegten Bildes“, Wien 2002, S. 258
5 Gilles Deleuze, Félix Guattari, „Tausend Plateaus“, S. 243
6 Roland Barthes, „Mythen des Alltags“, Frankfurt/M. 1964, S. 73
7 Vgl. Christa Blümlinger, Karl Sierek (Hg.), „Das Gesicht im Zeitalter des bewegten Bildes“, S. 258
8 Vgl. Gilles Deleuze, Félix Guattari, „Tausend Plateaus“, S. 230
9 Ebd.
10 Bela Balázs, „Der sichtbare Mensch oder die Kultur des Films“, Frankurt/M. 2001, S. 42
11 Ebd., S. 45
• Karin Fisslthaler
geb. 1981 in Oberndorf bei Salzburg (AT), lebt und arbeitet in Linz und Wien (AT)
„Echoes“, 2017
Fotocollage aus gefundenen Fotografien, bearbeitet auf Karton, 65 × 50 cm
Sammlung SpallArt, Inv. Nr. S-2350, © Karin Fisslthaler / Bildrecht, Wien

Saul Leiters Interesse an der Kunst begann in seinen späten Teenagerjahren, und 1946, als er 23 Jahre alt war, verließ er Cleveland und zog nach New York, um sich der Malerei zu widmen. In diesem Jahr lernte er den abstrakt-expressionistischen Maler Richard PousetteDart kennen, der auch mit der Fotografie experimentierte. Leiters Freundschaft mit Pousette-Dart und bald darauf mit W. Eugene Smith sowie die Fotoausstellungen, die er in New York sah, insbesondere die von Henri Cartier-Bresson im Museum of Modern Art im Jahr 1947, weckten sein wachsendes Interesse an der Fotografie.
Leiters erste Schwarz-Weiß-Fotografien [Anm. wie die Aufnahme mit dem Titel Joanna] zeigen eine außergewöhnliche Affinität zu diesem Medium, und ab 1948 begann er, mit Farbe zu experimentieren. Edward Steichen nahm Leiters Schwarz-Weiß-Fotografien 1953 in die Ausstellung Always the Young Stranger im Museum of Modern Art auf. In den späten 1950er Jahren veröffentlichte der Art-Director Henry Wolf Leiters farbige Modefotografien in Esquire und später in Harper’s Bazaar. Leiter arbeitete in den nächsten 20 Jahren weiter als Modefotograf, seine Bilder wurden in zahlreichen einflussreichen Modemagazinen veröffentlicht.
Leiter hat einen enormen und einzigartigen Beitrag zur Fotografie geleistet. Seine abstrahierten Formen und radikal innovativen Kompositionen haben eine malerische Qualität, die sich von den Arbeiten seiner Zeitgenossen der New York School abhebt. Vielleicht liegt das daran, dass Leiter über die Jahre hinweg sowohl als Fotograf als auch als Maler gearbeitet hat. Seine malerische Sensibilität kommt in seinen gemalten Aktfotografien zum Tragen, auf die er auf skurrile und sinnliche Weise Schichten von Gouche und Aquarellfarbe aufgetragen hat. Seine meisterhafte Verwendung der beiden Medien ist in diesen bemerkenswerten Werken offensichtlich.
Howard Greenberg Gallery, New York
• Saul Leiter
geb. 1923 in Pittsburgh (US), gest. 2013 in New York (US)
„Joanna“, um 1947
Gelatinesilberabzug, 22,3 × 32,1 cm
Sammlung SpallArt, Inv. Nr. S-1899, © Copyright

1
Für diejenigen, die das Werk von Sissi Farassat kennen, ist Revelation vor allem eine Überraschung. Als Pionierin der Eingriffe in ihre fotografischen Abzüge mit Perlenstickerei und vielen anderen Möglichkeiten, das Bild durch eine manuelle Bearbeitung seiner Oberfläche zu vergrößern, schlägt Sissi Farassat hier eine umgekehrte Methode vor. Das Ausgangsbild wird gefunden und dann übermalt. Wir sehen es nur in Fragmenten und müssen es erahnen. Das gewünschte Objekt gibt sich nur durch Verbergen. Es geht um den Körper, das Gesicht und die Verführung. Was wir wahrnehmen, erinnert an eine Zeit, in der die Attribute von Schönheit durch die Codes von Filmen und Magazinen definiert wurden, man findet noch die etwas altmodische Eleganz von Hollywood-Frauen und inszenierten Küssen. Aber genau genommen ist Revelation auch dem Ansatz von Sissi Farassat vollkommen treu. Indem sie volkstümliche Fotografien verwendet, auf denen sie stickt oder webt (Stitch, Pin Up, Contactsheet…), setzt sie die zeitgenössische Praxis des Foto-Upcyclings fort. Hier liegt die Besonderheit vor allem in der Tatsache, dass die Überdeckung des Bildes durch die Arbeit des Zuschneidens oder, genauer gesagt, durch das Spiel des Versteckens erfolgt: Das Bild zu zeigen, geht von einer Strategie der Blindheit aus. Das, was wir nicht sehen, nimmt eine herausragende Stellung ein. Was hier vor allem gewidmet wird, ist der Off-Screen als Raum, der gleichzeitig real und imaginär ist.
Michel Poivert1
• Sissi Farassat
geb 1969 in Teheran (IR), lebt und arbeitet in Wien (AT)
„Lee“, 2023
aus der Serie „Relevation“
Gelatinsilberabzug mit Passepartout, 13 × 18 cm
Sammlung SpallArt, Inv. Nr. S-2797, © Sissi Farassat / Bildrecht, Wien 2024


• Roberto Cavalli
geb. 1971 in Leno (IT), lebt und arbeitet in Brescia (IT)
„Malena, Venezia“, 2023 Gelatinesilberabzug, 29 × 41 cm
Sammlung SpallArt, Inv. Nr. S-2777, © Roberto Cavalli
• Claudio Monteccuco geb. in Perugia (IT), lebt und arbeitet in Italien
„La Maison n. 15“, 2009 pigmentbasierter Tintenstrahldruck, 26 × 19 cm
Sammlung SpallArt, Inv. Nr. S-2778, © Claudio Montecucco

Vivian Maier stammte aus einer amerikanischen Einwandererfamilie mit österreichisch-französischen Wurzeln. Sie war eine ambitionierte Amateurfotografin: Zeit ihres Lebens hielt sie mit ihrer Kamera mehr als 100.000 Eindrücke auf New Yorks und später Chicagos Straßen fest. Niemand wusste von ihrer großen Leidenschaft. Einsam und verarmt lebte sie sehr zurückgezogen als Kindermädchen und Haushälterin. Erst nach ihrem Tod wurde ihr Nachlass entdeckt und durch den preisgekrönten Film Finding Vivian Maier von John Maloof erlangte sie internationale Aufmerksamkeit.
„Die genaue Beobachterin sozialer Ungleichheit nimmt […] präzise wahr, wie bereits Kinder […] in Habitus und Ausdruck von ihrer Herkunft geprägt sind. Ihr Blick auf Frauen ist weicher, verständnisvoller als der auf Männer. Ihr bevorzugter Ausschnitt ist die Halbtotale, Menschen sozial höherer Schichten fängt sie – verdeckt
und unbemerkt – auch mal in Untersicht, aus dem sozialen Netz Gefallene in Aufsicht ein. Doch am liebsten richtet sie die Kamera direkt auf die Dargestellten.“1
Die Aufnahme aus dem Jahr 1961 entstand in jener Zeit, als Maier als Kindermädchen für die wohlhabende Familie Gensburg (von 1956 bis 1972) tätig war. Lane Gensburg sagte später über Maier „Sie war wie eine echte, lebende Mary Poppins“ die den Kindern die Welt außerhalb der wohlhabenden Vororte zeigte.2 Die Familien berichteten, dass sie ihre freien Tage damit verbrachte, durch die Straßen Chicagos zu spazieren und zu fotografieren, meist mit einer Rolleiflex-Kamera.3 Häufig nahm sie die kleinen Kinder, die sie betreute, zum Fotografieren mit ins Zentrum von Chicago.
Christoph Fuchs
1 Meret Ernst, „Die Fotografin Vivian Maier in der Photobastei“, 2016, https://www.hochparterre.ch/nachrichten/kultur/die-fotografin-vivianmaier-in-der-photobastei (abgerufen 3.9.2024)
2 Richard Cahan und Michael Williams (Hg.), „Vivian Maier: Out of the Shadows“, Chicago 2012, S. 86–87
3 Mary Houlihan, „A developing picture: The story of Vivian Maier“, The Chicago Sun-Times, 2.1.2011
Vivian Maier
geb. 1926 in New York (US), gest. 2009 in Chicago (US)
„Chicago“, 1961 (späterer Abzug)
Gelatinsilberabzug, 30,5 × 30,5 cm
Sammlung SpallArt, Inv. Nr. S-2774, © Estate of Vivian Maier, Courtesy Maloof Collection and Howard Greenberg Gallery, New York

Der Begriff „Inszenierung“ stammt aus dem Bereich des Theaters und steht für die visuelle Bühnengestaltung, das Licht, die Kostüme und die Maskenbildnerei. Eine inszenierte Fotografie beschreibt die bewusste Gestaltung und Planung eines Bildes, um eine bestimmte Stimmung, Botschaft oder Geschichte zu vermitteln. Es wird eine Abfolge präsentiert, die eine narrative Struktur aufweist. Diese impliziert, dass es für die dargestellte Szene ein „Vorher“ und ein „Nachher“ gibt.
Identitäten werden manipuliert und neue mittels Rollenkonstruktion erschaffen. Die Fotograf:in und Künstler:in übernimmt hierbei die Aufgabe der Regisseur:in und oftmals auch die der Darsteller:in vor der Kamera.
Die inszenierten Fotografie ist somit eine bewusste Verfälschung der Realität. Im Unterschied zur Malerei wird dem fotografierten Bild oft mehr Glaubwürdigkeit geschenkt. Das Medium als Beweis für Vergangenes – die Fotografie sagt: Das ist gewesen. Dadurch wird der Zweck der Wirkung erfüllt. Es geht um eine Zersplitterung der Identität und des Selbst. Die Künstler:innen schlüpfen in andere Figuren und schaffen fiktive Charaktere. Sie machen sich diese zunutze, um aus gesellschaftlich zugeschriebenen Rollen auszubrechen und diese auch kritisch zu hinterfragen. Dabei wird eine künstliche Welt erschaffen, die über die Grenzen des Realen hinausgeht und surreal, fantastisch oder metaphorisch wirken kann.
Cäcilia Steinkellner
Ob dieses Porträt die bekannte Tänzerin und Schauspielerin
Josephine Earp – langjährige Lebensgefährtin des WildwestRevolverhelden Wyatt Earp – abbildet oder nicht, ist im Laufe der Geschichte zu einem Streitpunkt geworden. 1914 wurde das Vignettenbild einer schönen jungen Frau, die in einem hauchdünnen
Gaze-Peignoir kühn für die Kamera posierte, populär. Es trug den Titel Kaloma und wurde ursprünglich als Kunstdruck produziert. Das gewagte Bild war beliebt und verkaufte sich gut. Noch im gleichen Jahr erschien das Bild am Cover eines Klavier-Solostücks von Gire Goulineaux Kaloma, Valse Hesitante, es erfreute sich großer Beliebtheit als Pin-up-Girl im Ersten Weltkrieg und der Nachkriegszeit und vielleicht am bekanntesten als Motiv für ein Plakat für das Konzert von Vanilla Fudge und The Charles Lloyd Quartet im Avalon Ballroom in San Francisco am 29. September bis 1. Oktober 1967. Der Autor Glenn Boyer war es dann, der den Mythos entstehen lies, es handle sich bei der abgebildeten Frau um Josie Earp.
Er verwendete eine Version des Bildes, bei der der Morgenmantel mit Airbrushtechnik abgedunkelt wurde, für das Buchcover des 1976 erschienenen Sachbuchs I Married Wyatt Earp über das Leben von Josephine Earp an der Seite des bekannten und berüchtigten
Revolverhelden Wyatt Earp. Tatsächlich wäre Josephine jedoch zum Zeitpunkt der Aufnahme 1914 bereits 53 Jahre alt gewesen. Erst in den späten 1990er Jahren stellte sich heraus, dass das gut verkaufte
Sachbuch über das Leben der Josephine Earp eine erfundene Geschichte des Autors war. Das Auktionshaus Sotheby's verkaufte das Bild noch im Jahr 1998 als Josephine Earp um sagenhafte
2.875 Dollar.
Earp oder nicht, das Bild ist dennoch ein schönes, frühes
Zeugnis für die verführerische Kraft der Fotografie sowie die Inszenierung und Macht des Bildes.
Christoph Fuchs
unbekannt
„Kaloma“, 1914
Gelatinesilberabzug, handkoloriert, 26,3 × 10,7 cm
Sammlung SpallArt, Inv. Nr. S-2785


• unzensurierte Szene in „Der Blaue Engel“, 1930
Sammlung SpallArt, Inv. Nr. S-275

• Helmut Berger in „Die Verdammten“, 1969
Sammlung Simak, Inv. Nr. 1518
Seltenes zensuriertes Werbefoto des deutschen Films Der blaue Engel aus dem Jahr 1930. Marlene Dietrich als verführerische Lola Lola war für die Veröffentlichung in der Werbung für den Film dann doch zu freizügig inszeniert. Die ufa (Universum Film AG)
retuschierte ihr kurzerhand einen dunklen Rock um die Zensur zu umgehen, wie der rückseitige Stempel der „Film-Prüfstelle Berlin“ mit „Genehmigt“ zeigt.
Der blaue Engel gilt als einer der ersten bedeutenden Tonfilme des deutschen Kinos und wurde von Josef von Sternberg inszeniert. Der Film basiert auf dem Roman Professor Unrat (1905) von Heinrich Mann. Der Film erzählt die tragische Geschichte von Professor Immanuel Rath (gespielt von Emil Jannings), einem strengen Gymnasiallehrer, der sich in die verführerische Kabarett-Sängerin Lola Lola (Marlene Dietrich) verliebt. Seine obsessive Leidenschaft für sie führt zum sozialen und persönlichen Absturz. Der blaue Engel zeigt in der Inszenierung von Körperlichkeit und Moral einen Kampf zwischen Disziplin und Trieb, zwischen gesellschaftlicher Ordnung und individuellem Verlangen. Der Film ist damit nicht nur eine Tragödie über eine unmögliche Liebe, sondern auch ein Spiegelbild der gesellschaftlichen Umbrüche seiner Zeit. Der Film und vor allem das bekannte Lied „Ich bin von Kopf bis Fuß auf Liebe eingestellt“ machten Marlene Dietrich zum Weltstar.
Auf diese Szene bezog sich einige Jahre später auch Luchino Visconti in seinem Film Die Verdammten (1969), während jedoch Der blaue Engel einen individuellen Niedergang zeigt, wird in Die Verdammten der kollektive Verfall einer ganze Eliteklasse thematisiert.
Christoph Fuchs
• unbekannt
„Der Blaue Engel“ (Film-Still), 1930
Gelatinesilberabzug, 21 × 27 cm
Sammlung SpallArt, Inv. Nr. S-274


• Arnulf Rainer
geb. 1929 in Baden (AT), lebt und arbeitet in Wien (AT)
„Mythos Marilyn - Sitzend II“, 2002
Fotoradierung, 26 x 19.5 cm
Edition Galerie Ernst Hilger © Arnulf Rainer
In meiner Neuinterpretation Marilyn-typischer Posen berühre ich in meiner Serie Marilyn revisited 40 Jahre nach ihrem Tod den Mythos und überprüfe ihn am Heute. Diese Arbeiten bilden auch die Grundlage einer spannenden Serie von Foto-Überarbeitungen und Heliogravür-Auflagen, die Arnulf Rainer für die Galerie Hilger geschaffen hat. In der österreichischen Schauspielerin Babsy Artner lebt der Mythos der unvergesslichen Marilyn Monroe weiter.
Robert Zahornicky
• Robert Zahornicky
geb. 1952 in Wien (AT), lebt und arbeitet in Pressbaum (AT)
„Mythos MM“, 2002 aus der Serie: „Marilyn revisited“
Heliogravüre, 25,5 × 19,5 cm
Sammlung SpallArt, Inv. Nr. S-859, © Robert Zahornicky / Bildrecht, Wien

Caffè Florian am Markusplatz in Venedig: Im Saal der berühmten Männer (Sala degli Uomini Illustri) hängen zehn Ölgemälde von Giulio Carlini (1826–1887). Dessen posthum gemalte Porträts der berühmter Venezianer – von Marco Polo über Tizian bis Goldoni –konfrontiert Irene Andessner mit zehn Venezianerinnen, darunter der berühmtesten Komponistin der Stadt (Barbara Strozzi), der Malerin (Rosalba Carriera) und der teuersten Kurtisane (Veronica Franco), sowie der ersten Doktorin (Elena Lucrezia Cornaro Piscopia) und der ersten Frauenrechtlerin der Welt (Moderata Fonte). Mit dieser Intervention verwandelt sich die Sala degli Uomini Illustri in die Sala delle Donne Illustri (Salon der berühmten Frauen). Eine vexierbildartige Irritation: Von Maske, Garderobe, Licht, Dekoration und Bildausschnitt abgesehen, weichen Andessners Darstellungen von den historischen Bildreferenzen der zehn Frauenfiguren ab: Sie hat nicht die Haltung und Blicke der Frauen, sondern der Männer aus den zu überhängenden Porträts nachvollzogen. Damit ist das Selbstverständnis, die Präpotenz, der männlichen Pendants gebrochen.
Das Bild zeigt Irene Andessner als Agnesina Morosini, Äbtissin von San Zaccaria im 9. Jahrhundert.
Das Adelsgeschlecht Morosini zählt zu den Gründerfamilien Venedigs. Agnesina Morosini wird Äbtissin des reichen Klosters San Zaccaria zur Zeit des Dogen Pietro Tradonico (ab 836). Der Legende nach kreiert sie eine edle Kopfbedeckung, die sie dem Dogen zum Geschenk macht. Der „Corno ducale“, eine perlenund edelsteinbesetzte Mütze mit massivem Goldrand und einem Hornmotiv, ist fortan das markanteste Attribut der Dogen. Auf den feierlichen Dogenprozessionen, die alljährlich am 13. September, am Vorabend der Weihe von San Zaccaria, vom Dogenpalast zur Klosterkirche führen, wird die schwerwiegende Dogenmütze dem Dogen auf einem Kissen voran getragen. Für Tradonico wird der 13. September 864 zum Unglückstag: Gedungene Attentäter überfallen ihn mitten in der Kirche und töten ihn auf der Flucht.
Irene Andessner
Irene Andessner
geb. 1954 in Salzburg (AT), lebt und arbeitet in Köln (DE), Wien (AT) und Venedig (IT)
„Agnesina Morosini (9. Jhdt.)“, 2003 aus der Serie „Donne Illustre, Venedig“ Duratrans Abzug auf Acrylglas (Leuchtkasten), 101 × 77 cm
Sammlung SpallArt, Inv. Nr. S-995, © Irene Andessner

Im Jahre 1965 wagte die Galerie der Jungen Generation (Wien, Börseplatz) einen halbherzigen Versuch, den „Wiener Aktionismus“ aus dem Untergrund zu holen. Man gab mir die Chance, eine Selbstbemalung in den Räumen der Galerie durchzuführen. Freilich verstand man das Ereignis mehr als ein Eröffnungsspektakel für meine Ausstellung Malerei-Selbstbemalung-Selbstverstümmelung.
Gezeigt wurden die im Jahre 1963 entstandenen Bilder der Malerei in einem labyrinthischen Raum, einige Zeichnungen und etliche Fotografien meiner Aktionen von Ludwig Hoffenreich. Zur Abrundung des Ganzen ließ man nach der Aktion eine Diskussion mit einem „Expertenteam“ ablaufen.
Die Vorbereitung dieser Aktion war freilich von einer mehr oder minder großen Nervosität begleitet. Otto Muehl half mir beim Einfärben meiner Gestalt. Ludwig Hoffenreich sagte zwischendurch seufzend: „Kinder, Kinder, das gibt entweder Irrenhaus oder Gefängnis!“ Ich gebe zu, daß ich von seinen Visionen nicht ganz frei war. John Sailer beförderte das lebende Bild vom Perinetkeller zum Heldenplatz, wobei ich mich bei jedem Halt vor einer Ampel niederduckte. Aufgeregt verfolgten meine Frau und einige Freunde aus einer angemessenen Entfernung das Geschehen. Hoffenreich und Ronald Fleischmann fotografierten, Muehl und Schwarzkogler filmten mit einer Schmalfilmkamera. Von einer tieferen Bedeutung dieser Aktion wollte die Presse natürlich nichts wissen. Sie betrachtete meinen Auftritt als einen lustigen Werbegag für meine Ausstellung.
Zur Eröffnung lud die Galerie am 30. Juni 1965 mit folgenden Worten: „Liebe Freunde der Galerie, Am Dienstag, dem 6. Juli 1965 wird Günter Brus in unserer Galerie um 19 Uhr anläßlich der
Eröffnung seiner Ausstellung eine Selbstbemalung durchführen. Wir sind uns der Problematik dieser Grenzfälle zeitgenössischer Malerei durchaus bewußt, halten aber ein einfaches Verschweigen dieser Dinge schon aus Prinzip für schlecht. Darüber hinaus aber mißt es diesen Bemühungen mehr Bedeutung bei als ihnen unserer Ansicht nach zukommt. Wir haben daher nach der Selbstbemalung zu einer Forumdiskussion geladen, an der unter meiner Leitung Herr Primarius Dr. Retter, Dr. Albert Massiczek und Dr. Robert Waissenberger teilnehmen werden. Wir erhoffen uns davon eine Objektivierung der Problematik.“
Am Tag vor dieser Ausstellungseröffnung mit Aktion und Diskussion beschloß ich, dem Kompromißcharakter dieses Unternehmens gewissermaßen vorzubeugen, um meinen künstlerischen Absichten mehr Eindeutigkeit zu verleihen. Man könnte sagen, die zwittrige Aktivität dieser Galerie trieb mich von den Rattenkellern auf die Straße. Ich beschloß, als gleichsam lebendes Bild durch Wiens Innenstadt, vorbei an etlichen historisch bedeutsamen Bauwerken, zu spazieren. Ausgangspunkt meiner Wanderung war der Heldenplatz. Durch das Burgtor, an der Spanischen Hofreitschule und am Dorotheum vorbei, sollte meine Route bis zum Stephansplatz führen. Was dort geschehen sollte, darüber gab ich mir keine Auskunft, zu Recht ahnend, daß bald das wachsame Auge eines Hüters der öffentlichen Ordnung das lebende Gemälde erblicken und festnehmen würde. Dies geschah Ecke Bräunerstraße/Stallburggasse. Ein Polizist führte mich zum Gaudium der Passanten in eine naheliegende Wachstube. Man nahm meine Personalien auf und ließ ein Taxi vorfahren.
Günter Brus1
Günter Brus
geb. 1938 in Ardning (AT), gest. 2024 in Graz (AT)
„Wiener Spaziergang“, 1965 (Abzug 1989)
Fotograf: Ludwig Hoffenreich
1 aus dem Begleitblatt zur Mappe „Wiener Spaziergang“, herausgegeben von der Galerie Heike Curtze und der Galerie Krinzinger, 1989
Gelatinesilberabzug auf Karton, 39,2 × 39,2 cm
Sammlung SpallArt, Inv. Nr. S-1810, © Günter Brus

Michaela Pöschl, „Körper in Aktion, Film und Video. Einige Anmerkungen zu ‚Oh Sensibility‘ und ‚Der Schlaf der Vernunft‘“, 2006, https://igkultur.at/theorie/koerperaktion-film-und-video-einige-anmerkungen-zu-oh-sensibility-und-der-schlaf-der (aufgerufen 3.2.2025)
Otto Muehl war einer der Hauptvertreter des Wiener Aktionismus, einer radikalen Kunstbewegung, die in den 1960er und 1970er Jahren in Wien entstand. Diese Bewegung war bekannt für ihre extremen, oft provokativen Performances, die gesellschaftliche Tabus brachen und den Körper als künstlerisches Ausdrucksmittel nutzten.
Muehl bezeichnete Aktionen wie Oh Sensibility als „Revolution der Wirklichkeit“. Während er den Körper zum Material erklärte und auf der Selbstreferentialität des Materials beharrte, waren es hauptsächlich nackte Frauen, die Muehl als Material dienten. Die 1969 realisierte Aktion Oh Sensibility erzählt Geschichten von Leda (die von Zeus in Gestalt eines Schwans vergewaltigt wird, weil sie ihn als Liebhaber verschmäht) und der Fixierung einer imaginären Identität des Künstlers. Die Kunst der Sechziger war auch Ausdruck der Situation weißer Künstler, die ihr exklusives Konzept von „Freiheit“ absolut setzten und mit Marcuse betonten, dass nicht das Bild einer nackten Frau, die ihre Schamhaare entblößt, obszön sei, sondern das eines Generals in vollem Wichs, der seine in einem Aggressionskrieg verdienten Orden zur Schau stellt. Auch Otto Muehl erklärte die Nacktheit von Mica Most und Romilla Doll, das Nudelholz in Ledas Scheide und den abgeschnittenen Schwanz/Gänsehals des Vergewaltigers/Gottes, zum anti-bürgerlichen Statement. Indem er auf der Natur „des Körpers“ beharrte, ignorierte Muehl aber die unterschiedlichen (Un-)Möglichkeiten, Bedeutungen von Körpern und Körperbildern festzuschreiben.
Michaela Pöschl 1
Otto Muehl
geb. 1925 in Grodnau (AT), gest. 2013 in Moncarapacho (PT)
„oh sensibility, wien 70“, 1970 (Abzug 1977–1984)
Fotograf: Ludwig Hoffenreich
Gelatinesilberabzug auf Karton, 40 × 30 cm
Sammlung SpallArt, Inv. Nr. S-1680, © Archives Muehl / Bildrecht, Wien

1
Der jüngste der Wiener Aktionisten ist fast ebensolange tot, wie er gelebt hatte. Rudolf Schwarzkoglers früher Abgang hat ihm das Schicksal der künstlerischen „Normalisierung“ erspart, wie es ihm die Legendenbildung um seine Person eingebracht hat. Wenn er um die Wandlung vom Staatsfeind zum Staatskünstler herumkam, so nicht um das standhafte Klischee vom Märtyrer für die Kunst. Die Legende von Selbstmord und Selbstkastration als „konsequente“ Folge radikaler körperlicher Selbstbefragung schreibt man bis heute auch in seriösen Publikationen fort. Dies ist gerade insofern bemerkenswert, als die Opferrolle demjenigen zugeschanzt wird, der dafür die geringsten Voraussetzungen mitbringt, war doch Schwarzkoglers Kunst die am wenigsten expressive und in ihrem theatralischen Gehalt zurückhaltendste aller Aktionisten. Und im Gegensatz zu Günter Brus etwa, der den Körper als Substitut der Leinwand begriff und nach dessen Bemalung (kunstgeschichtlich folgerichtig) tatsächlich sezierte, spielte sich Schwarzkoglers Analyse von Körpererfahrungen immer auf der Ebene des Symbolischen ab. Abgesehen von toten Fischen wurde niemand verletzt, nicht einmal das ästhetische Empfinden des Publikums. Dieses war – mit Ausnahme weniger Freunde – zu Schwarzkoglers Aktionen nicht zugelassen.
Christian Kravagna 1
• Rudolf Schwarzkogler
geb. 1940 in Wien (AT), gest. 1969 in Wien
„3. Aktion“, 1965 (Abzug 1975)
Gelatinesilberabzug, 39 × 29,5 cm
Sammlung SpallArt, Inv. Nr. S-1167, © Nachlass Rudolf Schwarzkogler / Galerie Krinzinger

Am Montag, den 3. August 1998, begann mit Sonnenaufgang im niederösterreichischen Schloß Prinzendorf die 100. Aktion, das 6-Tage-Spiel, des Wiener Aktionskünstlers Hermann Nitsch. Der Künstler nutzte das inmitten der idyllischen Landschaft des Weinviertels gelegene Schloß, das er seit 1971 bewohnt, als idealen Ort für sein Orgien Mysterien Theater.
Das 6-Tage-Spiel war ein sich über sechs Tage und sechs Nächte erstreckendes Fest, das sich nach Willen des Künstlers in Schloß, Garten und Umgebung ereignete. Den detailliert in einer Partitur festgelegten Handlungsablauf koordinierte der Münchner Regissseur Alfred Gulden. Das 150-köpfige Orchester leitete der Salzburger Komponist Clemens Gadenstätter. Weiters wirkten Blasund Heurigenmusiker:innen sowie ein Chor mit. Die Proben für die insgesamt 150 Akteur:innen der Aktionen begannen Mitte Juli.
Die Organisation des Festes erforderte eine aufwendige Logistik, da während der gesamten Spieldauer auch für die Verpflegung der 1.000 aus aller Welt gekommenen Gäste gesorgt wurde.
Das Fest war der Höhepunkt des künstlerischen Schaffens von Hermann Nitsch, das in der Happeningkunst und im Aktionismus seinen Ausgang genommen hatte. Das zentrale Anliegen: die Sensibilisierung und Intensivierung aller fünf Sinneseindrücke und deren synästhetische Kombination – dazu gehören auch Essen und Trinken. Nitsch verstand das Fest als Gesamtkunstwerk in der Tradition von Richard Wagner und Skrjabin. Aktionen mit Fleisch und Blut stehen im Zusammenhang mit der mythenaufarbeitenden Psychologie von Carl Gustav Jung. Erste Ideen des Künstlers zum 6-Tage-Spiel datieren aus dem Jahr 1958.
Symphonie in sechs Tagen
„Das 6-Tage-Spiel ist eine Komposition von realen Geschehnissen, das über alle fünf Sinne erfahrbar ist“, sagte Hermann Nitsch über das Gestaltungsprinzip seiner bislang größten Aktion. „Die sechs Tage und sechs Nächte sind vergleichbar einer sechssätzigen Symphonie, in der dramatische und meditative Sätze einander abwechseln und ergänzen.“
So folgte dem ersten Tag und seiner dramatischen Exposition (Stierschlachtung) ein ruhiger zweiter Tag, an dem zwei große Malaktionen im Mittelpunkt standen. „Der dritte Tag ist der Tag des Dionysos, der Tag des gebotenen Exzesses“, erklärte Nitsch. „An diesem Tag sollen sich, wie in einem Scherzo, Ausgelassenheit und Tragisches vermischen“.
Am vierten Tag folgten Ausstellungen und Installationen in allen Räumlichkeiten und im Park von Schloß Prinzendorf. Der fünfte Tag entsprach der Katastrophe des klassischen Dramas, dem „Abstieg in den Grundexzeß“, wie Nitsch das nannte. Auf die Schlachtung eines Stieres folgten Aktionen mit Fleisch, mit Gedärmen, mit Obst, Gemüse und Blumen. Der letzte Tag schließlich sollte nach Willen des Künstlers mit Musik und Prozessionen in die unbeschwerte Stimmung eines Volksfests münden.
Die Nächte seines Orgien Mysterien Theaters verglich Nitsch, der seit den 1960er Jahren seine Aktionen wie ein Komponist in Partituren genau festlegte, mit dem meditativen Adagio einer Symphonie: „Während ein Streichquintett unter dem nächtlichen Sternhimmel in der Kastanienallee spielt, verarbeiten die Zuhörer ihre Sinneseindrücke und versuchen Zugang zum Ganzen zu finden.“ 1
• Hermann Nitsch geb. 1938 in Wien (AT), gest. 2022 in Mistelbach (AT)
„Das 6-Tage-Spiel“, 1998
Fotograf: Heinz Cibulka C-Prints auf Karton, je 51 × 72 cm
Sammlung SpallArt, Inv. Nr. S-2016, © Nitsch Foundation / Heinz Cibulka / Bildrecht, Wien

In der Serie Körperkonfigurationen (1972–1982) nutzte valie export ihren Körper als Mess- und Zeigegerät, schmiegte sich an die Kurve eines Bordsteins oder orientierte sich an dem Winkel einer Treppenstufe oder schmiegt sich an die Rundung einer Säule, um soziale Machtstrukturen zu hinterfragen. Die gescheiterte Übereinstimmung mit den architektonischen Strukturen, die geometrischen Linien auf den Fotografien und die unruhige Gymnastik der Figur betonen die Spannung zwischen dem Individuum und den ideologischen und sozialen Kräften, die die urbane Realität prägen und die psychologischen Auswirkungen der gebauten und natürlichen Umgebungen registrieren.1
Die Aufnahme entstand 1982 am Theseustempel am Heldenplatz in Wien. Der Theseustempel wurde zwischen 1819 und 1823 von dem Hofarchitekten Peter von Nobile errichtet und sollte ein einziges zeitgenössisches Kunstwerk beherbergen: Antonio Canovas aus weißem Marmor geschaffene Skulptur Theseus besiegt den Kentauren. Fast siebzig Jahre lang stand das Meisterwerk allein im Theseustempel, bis es 1890 in das gerade fertiggestellte Kunsthistorische Museum übersiedelt wurde, wo es sich noch heute auf der Prunkstiege findet.
Christoph Fuchs
1 MoMA, Beschriftung aus der Ausstellung „The Shaping of New Visions: Photography, Film, Photobook“, 16. April 2012–29. April 2013
2
Johanna Schwanberg, „Kunst(re)aktionen: Günter Brus - VALIE EXPORTJulius Deutschbauer“, in: Maria Welzig, Anna Stuhlpfarrer (Hsg.), „Kulturquatiere in ehemaligen Residenzen. Zwischen imperialer Kulisse und urbaner Neubesetzung“, 2018, S. 71
Der Heldenplatz und die Hofburg sind in der bildenden Kunst nach 1945 mehrfach thematisiert worden, vor allem auch in performativen Arbeiten: Unter anderem beginnt Günter Brus Wiener Spaziergang hier, valie export hat sich im Dialog mit dem Gebäudekomplex fotografiert, und Julius Deutschbauer inszenierte eine Aktion in den Räumlichkeiten der Präsidentschaftskanzlei. Als Einzelpersonen haben Künstlerinnen und Künstler an diesem Ort eine Gegenüberstellung oder Konfrontation subjektiver, künstlerischer Wahrnehmung mit der Symbolik des Sieges von Monarchie und Staatsmacht inszeniert und die Mittel zeitgenössischer, performativer Medien mit einer Architektur kontrastiert, deren dominierend barocke und klassizistische Zeichenwelt unter anderem die „gottgewollte“ katholische Ordnung des Heiligen Römischen Reiches artikulierte. Ihre spezifische Komplexität entfalten diese Arbeiten dadurch, dass sie sozusagen vor einer verlassenen Kulisse spielen, einer, die nach dem Untergang des Habsburgerreiches auch dem Dritten Reich als Bühne diente. Immer noch steht dieses Ensemble von Prachtbauten für eine Macht, die bis in die Zellen des individuellen Körpers herrscht. Sie ist weniger greifbar geworden und wird von den Künstlern und der Künstlerin mittels dieser Kulisse ins Bewusstsein gerufen. Nach seinen vielfältigen Inkarnationen erlebt der Heldenplatz so seine düsterste, nämlich die des Mahnmals.
Johanna Schwanberg 2
VALIE EXPORT
geb. 1940 in Linz (AT), lebt und arbeitet in Wien (AT)
„A Despota“, 1982 (Abzug 2023) aus der Serie „Körperkonfigurationen“
Gelatinesilberabzug, 40 × 60 cm
Sammlung SpallArt, Inv. Nr. S-2622, © VALIE EXPORT / Bildrecht, Wien

„Ich habe mich nie wirklich für Politik interessiert oder sie verstanden, aber dieses Jahr war es anders. Obwohl ich zwei Wochen zu jung war, um wählen zu gehen, war ich alt genug, um zu sehen, was passiert, und mich darüber zu informieren. Ich weiß nicht, warum Donald Trump im Amt ist oder wie es überhaupt dazu kam, aber er ist es. Was wir mehr denn je brauchen, ist, zusammenzukommen. Gemeinsam sind wir stärker.“ Aria Watson, 2017
Aria Watsons Serie #SignedByTrump entstand aus ihrer Frustration darüber, dass sie zu jung war, um während der Präsidentschaftswahlen wählen zu gehen. Aus dieser Enttäuschung heraus sammelte sie frauenfeindliche und beleidigende Äußerungen von Donald Trump, die während seiner Kandidatur öffentlich geworden waren. Da sie nicht in der Lage war, sich Gehör zu verschaffen und ihre Stimme abzugeben, beschloss sie, seine Aussagen auf nackte Frauenkörper zu malen und so einen intelligenten feministischen
Kommentar zur aktuellen politischen Atmosphäre in den Vereinigten Staaten zu schaffen.
Aria Watson stellt nicht nur die Gräueltaten, die Trump über Frauen gesagt hat, visuell konsequent dar, sondern macht auch auf das Paradoxon aufmerksam, dass Menschen – vor allem Frauen –den Kandidaten nach seinen mehr als zweifelhaften und objektivierenden Äußerungen immer noch unterstützen. Der wütende weiße Mann scheint in der Lage zu sein, mit so gut wie jeder Übertretung davonzukommen, wie Watson anmerkt: „Als stolze Feministin hat es mich absolut krank gemacht, als ich hörte, wie Trump sagte ‚grab them by the pussy‘ und darüber sprach, dass er alles tun könnte, was er wollte. Frauen sind keine Objekte. Die Tatsache, dass er dies und andere Dinge wie diese gesagt und trotzdem gewonnen hat, macht mir Angst.“
Galerie Julian Sander
• Aria Watson
geb. 1998 in Tualatin (US), lebt und arbeitet in Astoria (US)
„#SignedByTrump No. 4“, 2016
Pigmentbasierter Tintenstrahldruck, 40 × 60 cm
Sammlung SpallArt, Inv. Nr. S-2003, © Aria Watson

Das unbetitelte Bild des japanischen Künstlers Nobuyoshi Araki zeigt die hohe Kunst der Fesselung. Die erotische Fesselungskunst im Japan der späten Edo-Zeit (1603–1868) wird „Shibari“ 縛り (wörtlich für binden, fesseln) oder „Kinbaku“ 緊縛 (strenges Fesseln) genannt. Die Fesselung entwickelte sich aus einer Kriegskunst, mit der Samurai Gefangene fesselten.
Araki nutz diese jahrhunderte alte Technik als zentrale Inszenierung weiblicher Körper, um Erotik, Macht und Vergänglichkeit darzustellen. Seine Bilder wurzeln in der japanischen Ästhetik von Eros und Vergänglichkeit – Mono no Aware 物の哀れ.
Araki bleibt jedoch ein umstrittener Künstler. Einerseits gilt er als visionärer Künstler. Andererseits bleibt die Kritik an seiner Darstellung von Frauen, seinen Arbeitsmethoden und der Vermarktung seiner Kunst nicht unbegründet. Ob man Arakis Werk als künstlerische Grenzüberschreitung oder als problematische Objektifizierung sieht, hängt stark vom persönlichen Standpunkt ab.
Christoph Fuchs
Nobuyoshi Araki
geb. 1940 in Minowa (JP), lebt und arbeitet in Tokyo (JP)
ohne Titel, 1997 (Abzug 2005) aus der Serie „Kinbaku“
Gelatinesilberabzug, 37 × 47 cm
Sammlung SpallArt, Inv. Nr. S-1272, © Nobuyoshi Araki

Das Bild ist Teil der Serie Newton Illustrated, die für eine Ausstellung in der Wiener Galerie Mezzanin im Jahr 2006 entstand. Für die Ausstellung wurden die beiden Künstler Jonathan Monk (geb. 1969) und Richard Prince (geb. 1949) eingeladen mit Re-Inszenierungen von bereits etablierten Bedeutungskomplexen zu arbeiten.
Für Jonathan Monk ist Wiederholung buchstäblich zu nehmen. Monk beschäftigt sich in seinen Arbeiten immer wieder mit Meisterinnen und Meistern der Minimal Art und Konzeptkunst. Seine „Wieder-Holungen“ bilden oftmals Verrückungen und Konsequenzen einer Idee ab. Ausführungen von zeichnerischen Handlungsanweisungen eines Sol Lewitt oder Umsetzungen von Ideen und Konzepten von Ed Ruscha oder Robert Barry legen Lücken ihrer Konzepte bloß und bilden dabei einen kritischen Loop in der Wahrnehmung ihrer Arbeiten. Sie sind relationaler Kommentar zu Fragen von Herstellung und Wahrnehmung.
Auf die Einladung seine Arbeit in Wien zu zeigen, reagiert Monk mit einer Serie von zwölf Dyptichen unter dem Titel Newton Illustrated, die eigens für diese Ausstellung entstanden sind. Monks Newton Illustrated ist eine Serie von Wieder-Fotografien des gleichnamigen Magazins, das Helmut Newton zwischen 1985 bis 1995 publiziert hat. Newton Illustrated ist in vier Ausgaben erschienen und versammelt neben manierierten Inszenierungen von typischen Newton-Modelen, Fotografien von Stars wie Sigourney Weaver, Kim Basinger oder Angelica Houston, sowie von aufgeladenen Symbolen der Avantgarde wie des Empire State Buildings oder einer Lokomotive. Angesiedelt zwischen populärer Magazinkultur und künstlerischer Reflexion ironisiert Newton Zuschreibungen von beiden Seiten. Monk bricht die Hochglanzästhetik von Newtons Fotografien, indem er nichts weiter tut, als das aufgeschlagene Magazin zu fotografieren. Er übernimmt das Layout von hoch- und quergestellten Fotografien und die Fotos verlieren ihren ursprünglichen Glanz, ihren Anspruch auf Perfektion. Das „Abknipsen“ der Hefte entspricht dem Vorgang des visuellen Konsums, es vermag aber auch die medial aufgeladenen Bilder Newtons zurechtzurücken. Mit Newton Illustrated wirft Jonathan Monk den Blick auf das Potential konzeptueller Strategien. Die Konstruktion von Identitäten bei Newton wird gebrochen. Monk gelingt es den Kategorien von Affirmation und kritischer Dekonstruktion eine weitere hinzuzufügen, die Herstellung von brauchbaren Bildern.
Eva Maria Stadler 1
1 Pressetext zur Ausstellung „Jonathan Monk und Richard Price, Newton Illustrated / Upstate“, Galerie Mezzanin, Wien 2006

•
„Locomotive, Omaha, Nebraska 1990“, 2006
• Jonathan Monk geb. 1969 in Leicester (GB), lebt und arbeitet in Berlin (DE)
„Smoking nude, Beverly Hills 1991“, 2006 aus der Serie „Newton Illustrated“ Gelatinesilberabzüg auf Karton, je 20 × 26 cm Sammlung SpallArt, Inv. Nr. S-1173 und S-1174, © Jonathan Monk


•
„59 Stellungen“, 1993
Video, 20 min
Sammlung SpallArt, Inv. Nr. S-1109
In der Videoarbeit 59 Stellungen von 1992 ließ Erwin Wurm die Protagonisten in Kleidungsstücke hineinsteigen, in unterschiedlichen Verrenkungen verharren und so Gebilde erzeugen, in denen sich ihre eigene Körperlichkeit auflöste. Die grotesken und absurden Momente, die daraus resultierten, bildeten schließlich die Voraussetzungen für Wurms One Minute Sculptures. Dieser neu geschaffene Skulpturentypus spielt mit Elementen des Alltäglichen und thematisiert die Reproduzierbarkeit sowie die Interaktion als Handlungsform und Ereignis. Ihre mediale Dokumentation mit Hilfe von Fotos und Videos bildeten in dieser Konstellation eine völlig neue Interpretation des Skulpturenbegriffs.
Stefan Tasch
1
Stefan Tasch, „Zuschnitt 39: täglich Holz“, September 2010, S. 28
• Erwin Wurm
geb. 1954 in Bruck a.d. Mur (AT), lebt und arbeitet in Wien und Limberg (AT)
„59 Stellungen“, 1993
Gelatinesilberabzüge, je 39 × 48 cm
Sammlung SpallArt, Inv. Nr. S-1774 bis S-1787, © Erwin Wurm / Bildrecht, Wien




Fotografie hat von Anfang an versucht, flüchtige Momente des Lebens festzuhalten. Besonders faszinierend ist dabei die Darstellung des Körpers in Bewegung.
Der menschliche Körper ist in Bewegung mehr als bloße Anatomie. Er wird zum Instrument des Ausdrucks, zur Bühne für Emotionen und Geschichten. Um dieses Phänomen einzufangen wurden unterschiedliche Ansätze entwickelt. Stroboskopische Bilder zerteilen Bewegung in einzelne Phasen, während Langzeitbelichtungen sie in fließenden Spuren visualisieren. Solche Techniken offenbaren nicht nur die Schönheit der Bewegung, sondern auch ihre Struktur und Komplexität.
Historisch spielte die Bewegungsfotografie eine zentrale Rolle in der Wissenschaft. Eadweard Muybridge und Étienne-Jules Marey untersuchten durch ihre Aufnahmen die Mechanik des Laufens,
Springens oder Fliegens. Diese Studien revolutionierten das Verständnis von Bewegung und fanden bald Eingang in die Kunst. In künstlerischen Fotografien wurden diese wissenschaftlichen Ansätze aufgegriffen, wurden jedoch um emotionale und ästhetische Dimensionen erweitert.
In der modernen Fotografie wird der bewegte Körper oft in performativen Kontexten dargestellt. Tanz, Sport und alltägliche Gesten werden zu Sujets, welche die Grenzen von Raum, Zeit und Schwerkraft ausloten. Gleichzeitig eröffnen digitale Technologien neue Möglichkeiten, Bewegung auf eine innovative Weise sichtbar zu machen. Zeitlupenaufnahmen und Bildmanipulationen spielen mit unserer Wahrnehmung und intensivieren die Wirkung der Dynamik.
Cäcilia Steinkellner

„Animal Locomotion, Plate 395“, 1887

Animal Locomotion ist eine bahnbrechende fotografische Studie des britischen Fotograf und Pioniers der Fototechnik Eadweard Muybridge, veröffentlicht im Jahr 1887. Das Werk umfasst 781 Tafeln, die Bewegungsabläufe von Menschen und Tieren in aufeinanderfolgenden Momentaufnahmen festhalten. Muybridge entwickelte dabei eine frühe Form der Chronofotografie, die als Vorläufer des Films gilt.
Noch in jungen Jahren wanderte Muybridge von Großbritanien nach Amerika aus und kam Mitte der 1850er Jahre nach San Francisco. Er fotografierte den heutigen Yosemite-Nationalpark, die Leuchttürme der Pazifikküste und den Krieg gegen den Stamm der Modoc. Im Frühjahr 1872 beauftragte der Eisenbahnunternehmer Leland Stanford Muybridge mit Hilfe seiner Fotokamera die Frage zu beantworten, ob ein galoppierendes Pferd immer mindestens einen Huf am Boden hat oder ob sich kurzzeitig alle vier Hufe in der Luft befinden.
Sammlung SpallArt, Inv. Nr. S-136, S-138, S-139 •
Muybridge nutzte eine Reihe von Kameras, die in kurzen Intervallen ausgelöst wurden, um Bewegung in Einzelbilder zu zerlegen. Die Aufnahmen entstanden an der University of Pennsylvania, wo er 1884 eine wissenschaftliche Untersuchung zur Biomechanik der Bewegung begann. Die Serie zeigt Männer, Frauen und Tiere in verschiedenen Bewegungsabläufen auch nackte oder leicht bekleidete Personen zur Analyse der menschlichen Anatomie in Bewegung.
Auch wenn Animal Locomotion ursprünglich eine wissenschaftliche Studie war, hat sie sich als künstlerisches Meisterwerk erwiesen. Muybridge schuf eine neue visuelle Sprache, die Bewegung als Kunst sichtbar machte – eine Revolution für Malerei, Fotografie und Film.
Christoph Fuchs
• Eadweard Muybridge geb. 1830 in Kingston upon Thames (GB), gest. 1904 in Kingston upon Thames
„Animal Locomotion, Plate 312“, 1887 Collotypie, 24 × 30 cm

Robert Frank emigrierte 1947 von der Schweiz in die usa. 1954 bewarb er sich um ein Guggenheim-Stipendium, das ihm 1955 als erstem Europäer gewährt wurde. Er plante eine großangelegte Bildreportage über die Vereinigten Staaten. Die zwischen 1955 und 1957 aufgenommene Werkgruppe The Americans schrieb Fotogeschichte. Während seines Roadtrips durch die usa, dokumentierte Frank mit unkonventionellen, oft unscharfen und scheinbar zufälligen Momenten den „American way of life“ der Nachkriegszeit. In zum Teil trostlosen Schwarz-Weiß-Bildern zeigte Robert Frank eine weniger idealisierte, oft melancholische Seite Amerikas, geprägt von Rassismus, Gewalt und Konsumkultur. Da seine Fotos nicht dem Selbstbild der usa entsprachen, konnte das gleichnamige Buch zunächst nur in Europa veröffentlicht werden. Mit The Americans gelang Frank eine der einflussreichsten Fotoarbeiten der Nachkriegszeit, die nicht nur die Streetphotography nachhaltig erneuerte, sondern auch Generationen von Fotograf:innen prägte. The Guardian schrieb 2014, The Americans „veränderte die Art der Fotografie, was sie sagen kann und wie sie es sagen kann. Es bleibt vielleicht das einflussreichste Fotobuch des 20. Jahrhunderts“.
Im Sommer 1958, einige Monate vor der Premiere von The Americans in Frankreich, begann Frank mit bewegten Bildern zu experimentieren. Doch bevor er sich ganz dem Filmemachen zuwandte, machte er eine weitere fotografische Serie, From the Bus. Nach der unvergleichlichen Freiheit des Projekts The Americans schränkte Frank seinen Blickwinkel stark ein, indem er Bilder durch
das Fenster eines fahrenden New Yorker Stadtbusses aufnahm. Er fotografierte Fußgänger:innen beim Gehen, Warten und manchmal auch in Bewegung. Damit überbrückte er die Kluft zwischen unbewegten und bewegten Bildern.
Die Serie From the Bus knüpft stilistisch an The Americans an, zeigt jedoch eine noch subjektivere und fragmentiertere Sicht auf die Gesellschaft. Sie verdeutlicht Franks Faszination für den Zufall und die flüchtigen Momente des Alltags, während sie gleichzeitig eine gewisse Distanz zwischen Fotograf und Motiv bewahrt. From the Bus kann als eine Reflexion über Bewegung, Isolation und das moderne Stadtleben interpretiert werden.
Das Bild in der Sammlung SpallArt ist die Vergrößerung eines original Kontaktabzugs der Serie. Ein Kontaktabzug ist eine direkte Kopie des kompletten Negativstreifens auf Fotopapier, sodass alle Aufnahmen in ihrer ursprünglichen Reihenfolge sichtbar bleiben. Diese Methode ermöglichte es Fotograf:innen, ihre Bilder im Kontext zu betrachten, Vergleiche anzustellen und Entscheidungen über die besten Aufnahmen zu treffen. Für The Americans spielten Kontaktabzüge eine wesentliche Rolle, denn Frank fotografierte mehr als 27.000 Aufnahmen und wählte für seine finale Auswahl nur 83 Bilder aus. Diese Arbeitsweise prägte ihn wohl sehr, auch wenn er in der Serie From the Bus bedeutend weniger Aufnahmen machte. Frank fertigte von den Kontaktabzügen der Serie Vergrößerungen wie diese an und erhob sie damit in den Status eines eigenständigen Kunstwerks.
Christoph Fuchs
• Robert Frank geb. 1924 in Zürich (CH), gest. 2019 in Inverness (CA)
„From the Bus“, 1958 (Abzug 1970er) Gelatinesilberabzug, 50,2 × 39,4 cm Sammlung SpallArt, Inv. Nr. S-2879, © The June Leaf and Robert Frank Foundation

Unabhängig davon, wie verhalten Rudolf Koppitz' erste Versuche auf dem Gebiet der Aktfotografie waren, das Genre wurde schnell zu seinem Markenzeichen. Koppitz blühte in seiner neuen Rolle als künstlerischer Aktfotograf auf, und schon im Jahr 1925 schuf er sein mit Abstand erfolgreichstes Werk, die Bewegungsstudie. Sie wurde zahllose Male von ihm selbst sowie auch von seiner Frau abgezogen, schon zu Lebzeiten vielfach verkauft, war regelmäßig in Ausstellungen zu sehen, heimste eine Auszeichnung nach der anderen ein, erschien in den verschiedensten Publikationen und bekam durchwegs Lob von der nationalen und internationalen Presse. Bis zum heutigen Tag erzielt sie bei Auktionen Spitzenpreise. Sie war und ist sein größter künstlerischer, wie kommerzieller Erfolg und gehört zu den am meisten publizierten Bildern der Fotogeschichte. Umso erstaunlicher ist, dass über die Darstellung selbst und die Umstände ihrer Entstehung relativ wenig bekannt ist.
Drei Frauen in bodenlangen, schwarzen Kleidern schmiegen sich dicht aneinander, Sie bilden einen dunklen Hintergrund, vor dem sich eine nackte Frau, offensichtlich eine Tänzerin, akrobatisch nach hinten beugt. Der Körper hebt sich deutlich von der Szenerie ab: Koppitz erweist sich hier als gelehriger Schüler Karel Nováks, dessen Spezialität es war, die Protagonisten mit Licht und Schatten sowie malerischen Effekten – oder einfacher gesagt mit Retuschen –hervortreten zu lassen, Die trapezförmigen Kutten sind fast zur Gänze ins Bild hineingemalt worden, um die beabsichtigte harmonische Wirkung zu erzielen.1 Unter dem opaken Block schimmern bei genauer Betrachtung die Originalgewänder durch. Zeitgleich mit der Bewegungsstudie entstanden zwei weitere, motivisch ähnliche Darstellungen mit denselben Modellen. Um wen es sich bei den Dargestellten der drei Studien handelt, ist bis heute nicht zweifels-
frei geklärt. Nach Aussagen von Anna Koppitz stand das Ballett Issatschenko Modell, das auch tatsächlich Anfang 1925, also etwa zu der Zeit, als die Fotografie entstanden sein soll2, ein Castspiel im Wiener Apollo-Theater gab. Die Modelle waren wohl allesamt anonyme Mitglieder der Tanzgruppe.3 Ein Foto des Ensembles, das für Vermarktungszwecke benutzt wurde, zeigt drei von ihnen auf Zehenspitzen stehend, in einer ähnlichen Konstellation wie die Bewegungsstudie. Es ist gut möglich, dass dieses Bild Rudolf oder Anna Koppitz in die Hände fiel und sie zu ihrem berühmten Werk inspirierte. Anna war während der Entstehung des Fotos Anfang 1925 hochschwanger, ließ es sich aber nicht nehmen, ihren Gatten tatkräftig im Atelier zu unterstützen. Sie gab den Tänzerinnen Anweisungen zu Posen und war damit maßgeblich am Erfolg der Bewegungsstudie beteiligt. Wie eingangs angedeutet, war sie der Katalysator für Koppitz' erwachendes Interesse am Akt. Dass er nun regelmäßig an Ausstellungen teilnahm, wurde wahrscheinlich ebenfalls von ihr gefördert. Die Bewegungsstudie ist jedenfalls kein vereinzelter Glücksgriff, sondern Teil eines sorgfältig erarbeiteten Konzepts, das seinen Anfang im Jahr zuvor nahm, als Koppitz' erste große Einzelausstellung in der Handelskammer in Wien stattfand, Dort zeigte er unter anderem Studien junger Mädchen der "rhythmischen Schule Hilda Hagers und der gymnastischen Schule Trimmell".4 Es handelt sich dabei wahrscheinlich um die Darstellung dreier Mädchen in Gymnastikkleidung und einen freizügigen Gruppenakt. Sie wirken in Bezug auf die artifiziellen Posen, die Auswahl der Modelle und den reduzierten Bildhintergrund wie Vorarbeiten zur Bewegungsstudie.
Magdalena Vukovic 5
1 Die Retuschen wurden wohl von Koppitz' Frau durchgeführt, die Berichten der Familie zufolge meist die Nachbearbeitung der Fotografien übernahm.
2 Da Rudolf und Anna Koppitz' Tochter Liselotte im Mai 1925 geboren wurde, ergibt sich für die Entstehung der Aufnahme ein Zeitfenster von wenigen Monaten.
3 Claudia Issatschenko, die Leiterin des Balletts, ist mit Sicherheit nicht das zentrale Modell der Bewegungsstudie. Sie war zu dem damaligen Zeitpunkt weit über vierzig Jahre alt und entspricht physiognomisch nicht der Abgebildeten.
4 o. A., ‚Kamera-Kunst‘, in: „Der Tag“, 24. Jänner 1925, S. 8
5 Magdalena Vukovic, ‚Die Kunst des Körpers‘, in: Monika Faber (Hg.), „Rudolf Koppitz. Photogenie. 1884–1936“, Wien 2013, S. 31
• Rudolf Koppitz
geb. 1884 in Schreiberseifen (heute: Krbovice, CZ), gest. 1936 in Perchtoldsdorf (AT)
„Bewegungsstudie“, 1925 (Abzug 1928)
Heliogravüre, 23,6 × 17,3 cm
Sammlung SpallArt, Inv. Nr. S-2794

Die dramatische Körperhaltung des Modells, unterstrichen vom Titel der Arbeit Verzweiflung, ist stark von der Ausdruckstanz-Bewegung beeinflusst. Koppitz nutzt hier meisterhaft den besonders von Caravaggio genutzten Chiaroscuro-Effekt, der sich durch starke
Hell-Dunkel-Kontraste auszeichnet und sowohl der Steigerung des Räumlichen als auch der des Ausdrucks dient. Wahrscheinlich ist eine seitliche oder diagonale Lichtquelle eingesetzt, die den Körper plastisch modelliert und die Struktur der Haut und Muskeln betont. Der Kontrast zwischen Licht und Schatten verstärkt das Gefühl von innerem Kampf und Verzweiflung.
Im Gegensatz zu Koppitz’ berühmter Bewegungsstudie von 1925, die durch eine harmonische Anordnung und eine fast skulpturale Ästhetik besticht, ist Verzweiflung rauer, emotionaler und stärker auf die psychologische Wirkung ausgerichtet. Koppitz setzt gezielt visuelle Mittel ein, um Verzweiflung nicht nur darzustellen, sondern auch in der Betrachter:in nachhallen zu lassen. Die Figur steht möglicherweise für das allgemeine menschliche Ringen mit Leid, Verlust oder inneren Konflikten. In den 1920er Jahren verarbeitete Kunst oft die psychologischen Nachwirkungen des Ersten Weltkriegs. Die Darstellung von Verzweiflung könnte eine Reaktion auf das kollektive Trauma sein.
Die Inszenierung erinnert an ähnlich emotionale Werke wie Der Schrei (1889) von Edvard Munch oder Werke von Egon Schiele, die Emotion durch extreme Körperhaltungen verstärkten. Christoph Fuchs
• Rudolf Koppitz
geb. 1884 in Schreiberseifen (heute: Krbovice, CZ), gest. 1936 in Perchtoldsdorf (AT)
„Verzweiflung“, 1927
Gelatinesilberabzug, 12 × 9 cm
Sammlung SpallArt, Inv. Nr. S-199

Charlotte Rudolph war eine deutsche Fotografin, die insbesondere für ihre Arbeiten im Bereich der Tanz- und Theaterfotografie bekannt wurde. Ihre Fotografien der avantgardistischen deutschen Tänzerinnen der 1920er und 1930er Jahre zählen heute zu den wichtigsten Dokumenten des Ausdruckstanzes. Im Unterschied zu anderen Fotograf:innen nahm Rudolph die Tänzer:innen nicht in einer Pose, sondern in Aktion auf. Ihre Bilder von Sprüngen der Tänzerin Gret Palucca trugen 1924 wesentlich zur internationalen Bekanntheit Paluccas bei und waren gleichzeitig Charlotte Rudolphs Durchbruch.
Eine Vielzahl der Aufnahmen wurden in den frühen 1920er Jahren als Postkarte veröffentlicht. Diese wurden jedoch nicht von einem Postkartenverlag im Rasterdruckverfahren, sondern als handabgezogene Originalfotos auf Fotopapier mit rückseitigen
Postkartenlinien von der Fotografin selbst hergestellt. Bei den Tanzaufführungen in den Theatern Dresdens verkaufte Charlotte Rudolph ihre Postkarten dann selbst.1
Charlotte Rudolph gilt heute als einflussreichste Tanzfotografin ihrer Zeit. Sie legte die Grundlagen für spätere Generationen und Künstlerinnen wie Barbara Morgan oder Loїs Greenfield.
Gret Palucca (1902–1993) war eine der innovativsten Tänzerinnen des Ausdruckstanzes und gilt als dessen Ikone. Sie entwickelte einen einzigartigen Stil, der sich von ihren Zeitgenoss:innen wie Mary Wigman oder Rudolf von Laban abhob. Während Wigman oft auf schwere, erdverbundene Bewegungen setzte, war Paluccas Stil leicht, kraftvoll und voller Sprünge.
Christoph Fuchs
1
vgl. Frank-Manuel Peter, „Die Frau im Theaterfoyer mit dem Postkartentisch“, Deutsches Tanzarchiv Köln, https://www.deutsches-tanzarchiv.de/ archiv/nachlaesse-sammlungen/charlotte-rudolph (aufgerufen 4.2.2025)
• Charlotte Rudolph geb. 1896 in Dresden (DE), gest. 1983 in Hamburg (DE)
„Palucca“, 1920er Gelatinesilberabzug, getont (Postkarte), 8 × 13 cm
Sammlung SpallArt, Inv. Nr. S-284, © Charlotte Rudolph / Bildrecht, Wien

Franz Löwy war ein österreichischer Atelier- und Gesellschaftsfotograf, aktiv von etwa 1900 bis 1938. Er betrieb Ateliers in Jägerndorf (heute Krnov, cz), Wien, Paris und Karlsbad (heute Karlovy Vary, cz).
Löwy spezialisierte sich auf Porträtfotografie und erlangte insbesondere in Wien während der Zwischenkriegszeit große Bekanntheit. Neben Porträts fertigte er auch Theater-, Tanz-, Mode- und Aktaufnahmen. Seine Arbeiten wurden in illustrierten Zeitungen und Fachzeitschriften veröffentlicht.
Nach dem Anschluss Österreichs 1938, emigrierte Löwy über Paris nach Brasilien, wo er in Rio de Janeiro seine Tätigkeit als Fotograf fortsetzte. Sein Atelier in Wien wurde nach seiner Flucht von den nationalsozialistischen Behörden beschlagnahmt und sein verbliebenes Eigentum verkauft.
Im Bild die österreichische Tänzerin und Gymnastiklehrerin Bertl Komauer. Sie war in den 1920er und 1930er Jahren in Wien tätig und leitete die „Schule Bertl Komauer“ für Gymnastik und Rhythmik in Wien. Komauer arbeitete mit renommierten Fotografen ihrer Zeit zusammen, darunter Franz Löwy und Anton Josef Trčka. Komauer tanzt ausdrucksvoll zu Johann Sebastian Bachs Präludium in b-Moll (bwv 867) aus dem „Wohltemperierten Klavier“, wie rückseitig vermerkt. Bachs Musik besitzt durch ihre Struktur und Emotionalität eine tiefe Ausdruckskraft. Die Verbindung von Bachs Kompositionen mit Tanz ist historisch gewachsen, da viele seiner Stücke auf barocken Tanzformen basieren.
Christoph Fuchs
• Franz Löwy
geb. 1883 in Ostrau (heute: Ostrava, CZ), gest. 1949 vermutl. in Rio de Janeiro (BR)
Bertl Komauer, um 1924
Gelatinesilberabzug auf Karton, 22 × 10 cm
Sammlung SpallArt, Inv. Nr. S-577

1
Im Jahr 1971 studierte ich ein Jahr lang modernen Tanz. Im Jahr 2014 kehrte ich zum Tanz zurück und fotografierte die ucla Kunststudenten in einer Vielzahl von Tanzposen. Bei diesen Fotos habe ich Architektur- und Landschaftsbilder in die roten, grünen und blauen Farbkanäle von Photoshop eingefügt. Im Jahr 2015 begann ich, professionelle Tanzkompanien zu fotografieren.
James Welling
Drei kulturelle Einflusssphären sind der Ausgangspunkt in der Serie Choreograph von 2014–2017. Bislang wurde das Frühwerk von Wellings alle Bildmedien durchexerzierenden Studium bei John Baldessari her gelesen. Allerdings hat Welling, inspiriert von der Merce Cunningham Dance Company, auch ein Jahr lang Modern Dance in Pittsburgh studiert; dieses verborgene Wurzelwerk seiner Biografie hat er erst ungefähr zeitgleich mit der Entstehung von Choreograph in Interviews zu thematisieren begonnen. Als Roh-
material für die Serie dienten von ihm oder seinen Assistenten angefertigte Schwarz-Weiß-Fotografien von Tanzperformances, Landschaften und Architektur, die er in die verschiedenen Farbkanäle des Rot/Grün/Blau-Modus von Photoshop transformierte und miteinander zu unvermuteten Amalgamen zusammenstellte.
Die fotografische Option der Einebnung von Zeit trieb Welling, ähnlich wie bei Diary/Landscape mit Mitteln des Stiles und des Sujets, nun durch die technische Integration von ihm und seinen Assistenten mit Kamera bis Mobiltelefon aufgenommener Bilder auf ein neues Niveau. Auch produzierte er bei über zwölf Tanzkompanien in Los Angeles, Ottawa und New York zusätzliches Material.
Diese Collage unterschiedlicher Interessen- und Einflussgebiete stellte für Welling eine neuerliche Befreiung dar, indem er bereits berührte Felder wie die Architektur oder das Landschaftsbild auf der fotografischen Terra incognita des Tanzes reaktivierte.
Martin Germann 1
• James Welling geb. 1951 in Hartford (US), lebt und arbeitet in New York (US)
„8634“, 2015 aus der Serie „Choreograph“ pigmentbasierter Tintenstrahldruck auf Dibond, 106,7 × 160 cm Sammlung SpallArt, Inv. Nr. S-1922, © James Welling


•
„Renate Schottelius, New York“, 1954 (Abzug 2012)
Gelatinesilberabzug, 24,1 × 18 cm
Sammlung SpallArt, Inv. Nr. S-2547
Ellen Auerbach war eine deutsche Fotografin, die für ihren innovativen und einflussreichen Ansatz in der Werbe- und Porträtfotografie bekannt war. Auf dem Bild: die Tänzerin Renate Schottelius in argentinischer Landschaft an den Hängen der Sierra de los Comechingones in der Provinz Còrdoba, nördlich von Buenos Aires. Ellen Auerbach besucht ihren Schwager, der nach Buenos Aires ausgewandert war1, wohl in Begleitung der Tänzerin Renate Schottelius. Auerbach und Schottelius verband eine jahrelange, intensive Zusammenarbeit und wahrscheinlich auch Freundschaft, die sich besonders in der ikonischen Aufnahme Renate Schottelius, New York aus dem Jahr 1954 zeigt.
Christoph Fuchs
1
„Ellen Auerbach. Berlin, Tel Aviv, London, New York“, Biographie, München/New York 1998, S. 98
• Ellen Auerbach
geb. 1906 in Karlsruhe (DE), gest. 2004 in New York (US)
„Danzer, Renate Schottelius, Sierra, Argentine“, 1945 (Abzug 1970er)
Gelatinesilberabzug, 26 × 35 cm
Sammlung SpallArt, Inv. Nr. S-822, © Ellen Auerbach Estate / Bildrecht, Wien



Bislang gründete sich Kilians Nachruhm vor allem auf seinen hinreißenden Fotos vom Stuttgarter Ballett, die in der Ära Cranko um die Welt gingen. Doch nicht erst in den 1960er und 1970er Jahren zeigt sein Werk eine geniale Begabung, Bewegung in fotografische Momentaufnahmen zu übersetzen. Ein traumschönes Tanzbild aus den 1930er Jahren: Über einer Blumenwiese schweben zwei Mädchen im Sprung, während eine dritte im Überschlag auf den Händen balanciert. Alle drei sind in dem glücklichen Augenblick verewigt, da die Schwerkraft aufgehoben scheint. Die formale Perfektion dieses Fotos nimmt man erst auf den zweiten Blick wahr, so ansteckend wirkt seine unbeschwerte Lebensfreude.
1938, im Jahr der Aufnahme, drückte es eine Sehnsucht, aber sicher nicht die Befindlichkeit des jungen Fotografen aus. Widerstrebend kehrte er damals aus dem selbstgewählten Exil ins nationalsozialistische Deutschland zurück. 1909 in Ludwigshafen am Bodensee geboren, hatte er 1931 eine Fotoausbildung in der Schweiz abgeschlossen. Noch lieber wäre Kilian Kameramann oder Pilot geworden, aber dafür fehlte das Geld. Er arbeitete bei einer Fotofirma in Luzern und für ein Fotoatelier in Neapel, war 1937 während der Pariser Weltausstellung Reiseleiter und Kameraassistent in Paris, bis ihm die Arbeitserlaubnis entzogen wurde.
Michael Bienert 1
• Hannes Kilian geb. 1909 in Ludwigshafen (DE), gest. 1999 in Wäschenbeuren (DE)
„Drei springende Mädchen in der Wiese“, 1938 Gelatinesilberabzug, 32,5 × 42,7 cm
Sammlung SpallArt, Inv. Nr. S-2552, © Hannes Killian / Bildrecht, Wien

1 Wikipedia, https://de.m.wikipedia.org/wiki/Hans_Robertson (aufgerufen 31.1.2025)
2 Annette von Wangenheim, „Tanz unterm Hakenkreuz“, Dokumentation, Deutschland 2003, 60 min, http://www. annettevonwangenheim.de/film07.htm (aufgerufen 31.1.2025)
Hans Robertson war ein deutscher Fotograf, bekannt für seine Arbeiten in der Porträt-, Tanz- und Modefotografie. Um 1927 übernahm er das Atelier von Lili Baruch am Kurfürstendamm in Berlin, welches auf Theater- und Tanzfotografie spezialisiert war. Robertson avancierte zu einem der renommiertesten Porträtisten der Stadt, vor allem von Schriftsteller:innen, Künstler:innen und Politiker:innen wie Käthe Kollwitz, Heinrich Mann oder Gustav Stresemann. Besonders bekannt wurde er durch seine Aufnahmen moderner Tänzer und Tänzerinnen wie Harald Kreutzberg, Vera Skoronel und Mary Wigman, so wie des Boxers Max Schmeling.1 Aufgrund seiner jüdischen Herkunft musste er nach der Machtergreifung der Nationalsozialisten Deutschland verlassen und floh nach Dänemark und Schweden. Er übergab sein Atelier im Juni 1933 mitsamt dem Negativbestand an seinen früheren Mitarbeiter Siegfried Enkelmann.
Im Bild der deutsche Tänzer und Choreograf Harald Kreutzberg. Er zählte zu den wichtigsten Vertretern des Ausdruckstanzes in Deutschland der 1920er bis 1940er Jahre. Kreutzberg setzte seine Künstlerkarriere während der NS-Zeit ohne Unterbrechung fort. Selbst völlig unpolitisch, ließ Kreutzberg sich von den Nationalsozialisten als Aushängeschild für das deutsche Kulturleben benutzen und blieb auch in dieser Zeit einer der vom Publikum meist verehrten und gut verdienenden Tänzer.2
Christoph Fuchs
• Hans Robertson geb. 1883 in Hamburg (DE), gest. 1950 in Vangede (DK)
„Harald Kreutzberg“, um 1928 Gelatinesilberabzug, 21,5 × 15,6 cm Sammlung SpallArt, Inv. Nr. S-2791

Aus drei Meter Höhe fallen die Porzellanfiguren zu Boden, wobei das Geräusch ihres Aufpralls den Auslösemechanismus in Gang setzt. Es entstehen gestochen scharfe Bilder von irritierender Schönheit – temporäre Skulpturen, für das menschliche Auge sichtbar gemacht durch die Technik der Hochgeschwindigkeitsfotografie. Nicht so sehr die in Stücke zerspringende Porzellanfigur fällt dabei ins Auge, sondern vielmehr die neu entstehende, dynamische Figur, die an die Stelle der erstarrten Pose tritt. Im Gegensatz zur Leblosigkeit der noch intakten Kitschfigürchen, die Klimas sich als Motive gewählt hat, besitzen die Fotografien ihrer Zerstörung einen stark narrativen Charakter.
Martin Klimas
• Martin Klimas
geb. 1971 in Singen (DE), lebt und arbeitet in Düsseldorf (DE)
„o. T.“, 2006
pigmentbasierter Tintenstrahldruck, 127 × 183 cm
Sammlung SpallArt, Inv. Nr. S-1043, © Martin Klimas

Water Dance ist eine berühmte Sammlung von Unterwasserfotografien des renommierten amerikanischen Fotografen Howard Schatz, die in den 1990er Jahren veröffentlicht wurde. Die Serie verbindet die Eleganz des Tanzes mit den einzigartigen Eigenschaften von Wasser, wie Schwerelosigkeit, Klarheit, Reflexion und Lichtbrechung. Die Fotografien zeigen Tänzer und Tänzerinnen, meist aus der Welt des klassischen Balletts, in beeindruckenden und oft surrealen Posen, die durch die Schwerelosigkeit im Wasser möglich werden.
Schatz arbeitete mit technisch versierten und ausdrucksstarken Tänzer:innen und Modellen, um die Bewegungen und die Form des menschlichen Körpers in einer anderen Dimension darzustellen. Die Bilder zeichnen sich durch eine ästhetische Mischung aus Licht, Farbe, Design und Bewegung aus, die die Grenzen der traditionellen Tanzfotografie erweitert. Sie sind sowohl kunstvoll als auch mystisch und vermitteln das Gefühl, in eine Traumwelt einzutauchen.
Howard Schatz, ursprünglich Augenarzt, wechselte in die Fotografie und erlangte mit Projekten wie Water Dance und Pool Light internationale Anerkennung.
Christoph Fuchs
• Howard Schatz
geb. 1940 in US, lebt und arbeitet in New York (US)
„Water Dance“, 1990er Cibachrome, 19 × 24 cm
Sammlung SpallArt, Inv. Nr. S-2795, © Howard Schatz and Beverly Ornstein

Was passiert während des Schlafes zwischen sich liebenden Menschen? Schlafen sie nebeneinander, jede und jeder für sich, oder teilen sie doch gewisse Empfindungen, Orte oder Emotionen? Ist es ein nächtlicher Tanz von Liebenden, eine unbewusst ausgeführte
Art von Zuneigung, oder kehren sie sich den Rücken zu? Gibt es eine Vereinigung mit dem Anderen, eine mit dem Selbst?
Ich fotografiere Menschen und vielleicht die Spuren, die sie hinterlassen. Die intimen Momente des Schlafes in einem schwarzen Bett. Ich dringe also in die Intimsphäre der Liebenden ein. Ich bitte Freunde, Bekannte und Fremde mit einem oder zwei geliebten Menschen in mein Atelier zu kommen. Um in einem schwarzen Bett zu schlafen, in einem durch Kerzen erhellten Raum und während der gesamten Nacht von mir fotografiert zu werden. Tiefe Vertrautheit und Intimität herrschen nicht. Die Liebenden vertrauen mir, lassen dies alles mit sich geschehen, geben sich der Schutzlosigkeit hin. Einige sind nervös oder unruhig und schlafen nicht sehr gut. Andere berichten von einem ausgezeichneten Schlaf.
Paul Maria Schneggenburger
•
Paul Maria Schneggenburger
geb. 1982 in Freiburg (DE), lebt und arbeitet in Wien (AT)
„Der Liebenden Schlaf“, 2010
Gelatinesilberabzug auf Aluminium, 100 × 125 cm
Sammlung SpallArt, Inv. Nr. S-1355, © Paul Maria Schneggenburger

In der prozesshaften Auseinandersetzung mit der Fotografie und ihrem künstlerischen Diktat, entwickelt Anja Manfredi bereits seit mehreren Jahren vielfältige Körperkonzepte und untersucht durch den Kunstgriff der Inszenierung ihrer Protagonist:innen deren formales Zusammenwirken. Wie die bedeutendsten Künstler:innen in der Aufbruchsphase der heute klassischen Moderne, experimentiert sie mit spezifischen Bewegungen und Gesten, die sie in einem „Archiv der Bewegungen“ zusammenzustellen beabsichtigt. Heute wie damals war die Fotografie ein adäquates Mittel, um ausgewählte Momente des sich bewegenden Körpers in Posen und Gesten zu verbildlichen. Im Ausschneiden der Figuren und deren Entrückung aus dem eigentlichen Bild- und Lebenszusammenhang, gelingt es Manfredi mittels der Collage neue Wirklichkeits- und Beziehungsebenen zu definieren.
Alfred Weidinger
• Anja Manfredi
geb. 1978 in Lienz (AT), lebt und arbeitet in Wien (AT)
„Die Geste des Wendens“, 2007 C-Print auf Dibond, 85 × 66 cm
Sammlung SpallArt, Inv. Nr. S-582, © Anja Manfredi / Bildrecht, Wien


• Jan Vollmann
ohne Titel, 2000er
pigmentbasierter Tintenstrahldruck, 20,6 × 30,8 cm
Sammlung SpallArt, Inv. Nr. S-2484, © Jan Vollmann
• Joel Peck
ohne Titel, 2000er
C-Print, 32 × 21,2 cm
Sammlung SpallArt, Inv. Nr. S-2483, © Joel Peck


• Till Megerle
ohne Titel, 2000er
C-Print, 26 × 38,8 cm
Sammlung SpallArt, Inv. Nr. S-2485, © Till Megerle
Diese Serie spielt in Kalabrien in den Jahren 1984–1985 und wurde von Franco Costabiles Gedicht Il canto dei nuovi emigranti (Das Lied der neuen Emigranten) inspiriert, das die Wut und Verbitterung der Menschen beschreibt, die ihre Heimat verlassen mussten.
Giacomelli besuchte Cutro, Badolato, Pentedattilo, Caraffa di Catanzaro, Tiriolo und Copanello di Catanzaro und war von dem, was er vorfand, überrascht. „Pentedatillo hat mich beeindruckt, weil es sich wie ein anderes Land anfühlte – ein Ort, an dem Menschen geboren wurden, gelebt, gelitten haben, gediehen sind – und der jetzt verlassen ist. Auf der Durchreise schien es völlig verlassen zu sein. Aber als ich am oberen Ende der Straße ankam und hinunterblickte, sah ich, dass dort Salat und Zwiebeln gepflanzt waren... also muss es dort jemanden gegeben haben. Es fühlte sich verlassen an, abgeschottet von der Welt, aber ich war über das Leben gestolpert. [...] Dann wollte ich auf den Friedhof gehen. Ich stellte fest, dass jede Grabtafel poliert worden war. Ich dachte, die Blumen müssten aus Plastik sein, aber als ich näher kam und sie berührte, waren sie frisch. Und so dachte ich mir: Wir haben einen halben Tag gebraucht, um hierher zu kommen, wir haben unterwegs niemanden getroffen, alles schien verschlossen, tot, aber in Wirklichkeit gibt es hier Leben. Das gab mir ein seltsames Gefühl. Diese Berge mit diesen riesigen Löchern... in meiner Vorstellung
begann ich, die Löcher mit Menschen zu füllen: Wo waren diese Menschen? Und so regte sich etwas Geheimnisvolles in mir, etwas Magisches, Tragisches, etwas, das ich nicht erklären konnte. Auf diesen Fotos kann man sehen, dass die Häuser bereits etwas verlieren, es ist, als würden ihre Mauern zu Stein, zu Bergen, [als würden sie] verschlungen werden. Das Dorf zerbröckelt. Das Licht, das ich in dieser Serie verwendet habe, lässt es so aussehen, als würde die Sonne Löcher in die Häuser fressen, obwohl es in Wirklichkeit der Mond ist, und die Fotografien haben einen Hauch von Tod.“
Mario Giacomelli, in einem Video-Interview mit E. Castagna. Diese Vision des Südens unterscheidet sich stark von der in Giacomellis Serie Apulien, in der die Überbevölkerung und die Armut des Gargano im Jahr 1958 spürbar sind. Sie unterscheidet sich auch stark von der malerischen Ansicht des Südens, die wir in Giacomellis Fotografien von Scanno aus seiner Zeit dort in den Jahren 1957 bis 1959 finden. In Anlehnung an Costabiles Gedicht sah Giacomelli Kalabrien als einen Ort des Verlustes, gefangen zwischen Anwesenheit und Abwesenheit. Die vom Berg verschlungenen Häuser, der ausgehöhlte Felsen von Pentedattilo und die Menschen, die auf mysteriöse Weise in einem Zustand der Unbeweglichkeit zu verharren scheinen, sind die Protagonisten dieser Serie.1
1
Archivio Mario Giacomelli, https://www.archiviomariogiacomelli. it/en/1984-il-canto-dei-nuovi-emigranti/ (aufgerufen 11.2.2025), übersetzt mit deepL
• Mario Giacomelli
geb. 1925 in Senigallia (IT), gest. 2000 in Senigallia
„Calabria“, 1975–1985 aus der Serie „Il canto dei nuovi emigranti“ Gelatinesilberabzug, 20 × 27 cm
Sammlung SpallArt, Inv. Nr. S-640, © Archivo Mario Giacomelli, Senigallia

1 Ingeborg Lüscher, https://ingeborgluescher.com/works/videos/il876 (aufgerufen 11.3.2025)
Ein Abend in einer Pekinger Bar – eine Gruppe von Künstler:innen und Tänzer:innen spielt ein Spiel, das dem europäischen „SchereStein-Papier“ ähnelt. Aber die chinesische Version ist komplexer. Je nach Ergebnis (Gleichstand, Sieg oder Niederlage) begleiten die Spieler:innen ihre Gesten mit symbolischen Küssen oder Ohrfeigen ins Gesicht des Gegners in rasender Geschwindigkeit. Der Tumult steigert sich, bis er in brüllendem, ekstatischem Gelächter explodiert, um dann wieder an Intensität zu verlieren und abzusacken. Dann setzt ein neues Paar das Spiel fort.
Das Video wurde unter dem Pseudonym Ying-bo auf der 48. Biennale in Venedig 1999 von Kurator und Ausstellungsmacher Harald Szeemann (1933–2005) präsentiert. Szeemann war damals auch Lebensgefährte der Künstlerin und nur wenige Wochen nach der Eröffnung wurde Lüschers Autorenschaft vom findigen Kunstkritiker Karlheinz Schmid in seinem Informationsdienst Kunst bekannt gegeben: „Ingeborg Lüscher wollte, dass die Arbeit – und nichts als die Arbeit – gesehen wird, dass nicht erneut, wie früher so oft, der Zusammenhang mit Szeemann hergestellt wird … Das Geheimnis der diesjährigen Biennale, letztlich gar nicht als Geheimnis konzipiert, sondern nur als Werkschutz für die turbulenten Eröffnungstage, lässt sich (auch) als Antwort auf einen Kunstbetrieb sehen, der zunehmend von Namen und weniger von Werken bestimmt wird.“1
Christoph Fuchs
• Ingeborg Lüscher geb. 1936 in Freiberg (DE)
„FEI-YA! FEI-YA! Fly! Fly! (Our Chinese Friends)“, 1998–1999 Video, 8 min
Sammlung SpallArt, Inv. Nr. S-928, © Ingeborg Lüscher / Bildrecht, Wien




Die Fotografie hat die Fähigkeit Vergänglichkeit festzuhalten. Besonders deutlich wird dies in der Auseinandersetzung mit dem Thema Tod. Ob als dokumentarisches Zeugnis, künstlerische Inszenierung oder metaphysische Reflexion – der Tod und das Finale sind zentrale Motive, die in der Fotografie die Grenze zwischen Leben und Ewigkeit berühren.
Von den frühen Post-Mortem-Porträts des 19. Jahrhunderts, die Verstorbene in lebensechten Posen zeigten, bis hin zu modernen Arbeiten, die Verlust und Trauer abstrakt umsetzen, zeigt die Fotografie ihre Vielseitigkeit im Umgang mit dem Tod. Während frühe Bilder oft ein Ausdruck von Nähe und Abschied waren,
fragen zeitgenössische Werke nach der Bedeutung von Tod in einer zunehmend entkörperlichten Welt.
Das Finale in der Fotografie kann direkt oder symbolisch dargestellt werden. Bilder von Verfall, leerstehenden Räumen oder verblassenden Schatten sind subtile Hinweise auf das Unausweichliche.
Tod in der Fotografie ist oft eine Auseinandersetzung mit Tabus. Diese Bilder zeigen oftmals, wie provokant, aber auch heilend die visuelle Auseinandersetzung mit Sterben und Vergänglichkeit sein kann. Sie öffnen Räume für Emotionen, die zwischen Trauer, Ehrfurcht und Akzeptanz oszillieren.
Cäcilia Steinkellner


•
„Narre
1921
Eine fotografische Inszenierung des deutschen Fotografen Franz Fiedler eines kurzen Textes von Thea Giradelli. Die zehn Bilder der Serie Narre Tod mein Soielgesell stehen jeweils in direktem Bezug zu den zehn Absätzen des Textes. Zum Bild Nr. 5 heißt es: „guck meinen Zeh! Rosig – geschmeidiger als bei anderen die zärtlichste Hand.“ Franz Fiedler erschafft diese Serie in Zusammenhang mit dem Tod seines Vaters.
Christoph Fuchs
• Franz Fiedler
geb. 1885 in Proßnitz (heute: Prostějov, CZ), gest. 1956 in Dresden (DE)
„Narre Tod mein Spielgesell, Nr. 5“, 1921
Gelatinesilberabzug, 14 × 17 cm
Sammlung SpallArt, Inv. Nr. S-454, © Franz Fiedler Nachlass

Emil Brugsch stammte aus Preußen und war ein deutscher Archäologe. Nach einem abenteuerlichen Leben, das ihn nach Brasilien führte, schloss er sich 1870 seinem älteren Bruder Heinrich in Ägypten an. Zunächst war er Direktionsassistent des Museums in Bulaq und anschließend Konservator des Ägyptischen Museums in Kairo, wo er sich beim Verkauf von Artefakten bereicherte. Er wurde Assistent der bekannten französischen Ägyptologen Auguste Mariette und Gaston Maspero. Dabei war er besonders bei der Bergung der Mumien aus der Grabanlage von Deir el-Bahari in Theben beteiligt. Unter den hier entdeckten Mumien befand sich auch die von Ramses ii.
In zweifacher Weise wurde aus den Köpfen von Ramses ii. und Choutmés ii. für den heutigen Betrachter ein expressives Gebilde: Einerseits durch die Verformung und Schrumpfung des Gesichts beim Mumifizieren, andererseits durch das Vergilben der Albuminabzüge.
Christoph Fuchs & Fritz Simak
• Émile Brugsch
geb. 1842 in Berlin (DE), gest. 1930 in Nizza (FR)
„Ramessés II, Choutmés II“, um 1881
Albuminabzug auf Karton, 46 × 41 cm
Sammlung SpallArt, Inv. Nr. S-766


• unbekannt
L’Inconnue de la Seine, 1920er
Gelatinesilberabzug auf Karton, 15 × 22 cm
Sammlung SpallArt, Inv. Nr. S-146
L’Inconnue de la Seine (Die Unbekannte aus der Seine) war eine unbekannte junge Frau, deren Totenmaske Anfang des 20. Jahrhunderts an den Wänden vieler Künstlerinnen- und Künstlerwohnungen in Paris zu finden war. Die Maske war Inspiration für zahlreiche Literat:innen und Motiv für viele Fotograf:innen. Der Legende nach handelt es sich bei der unbekannten Frau um eine Selbstmörderin, deren Leiche um 1900 in Paris aus der Seine geborgen wurde. Ein Mitarbeiter der Pariser Leichenschauhalle soll von ihrer Schönheit so angetan gewesen sein, dass er einen Gipsabdruck ihres Gesichts nahm. Er ließ eine Totenmaske anfertigen, von der in den folgenden Jahren zahlreiche Kopien gemacht wurden, die in der Pariser Bohème als morbides Einrichtungsaccessoire in Mode kamen.
Der rätselhaft friedvolle Gesichtsausdruck der Toten war Anlass für zahllose Spekulationen über ihr Leben, ihre Todesumstände und ihre Befindlichkeit im Jenseits.
Mediengeschichtlich interessant ist die damalige Popularität dieser Abbildungen. Sie hängt mit der Mehrfachreproduktion zusammen: Dass die Abdrücke der Totenmaske fotografiert und von den Negativen wiederum reproduziert wurden, schien ihre Authentizität zu verstärken. Das Wasser schien den letzten Gesichtsausdruck ihres Lebens wie ein Foto gebannt zu haben, was bei Wasserleichen nicht der Fall ist.
Elisabeth Bronfen überliefert in ihrem Buch Nur über ihre Leiche. Tod, Weiblichkeit und Ästhetik (1994) eine andere Entstehungslegende, gemäß der ein findiger Hamburger Gipsfabrikant einen Abdruck vom Gesicht seiner lebenden Tochter herstellte.
Wikipedia 1
• Albert Rudomine geb. 1892 in Kyjiw (UA), gest. 1975 in Paris (FR)
„Vierge_inconnue“, 1927
Gelatinesilberabzug, 29 × 23 cm
Sammlung SpallArt, Inv. Nr. S-19, © Albert Rudomine Estate


•
„The mothers of Naples lament their sons’ death“, 1943
Gelatinesilberabzug, 24 × 18 cm
Sammlung SpallArt, Inv. Nr. S-287
1
vgl. Operation Avalanche, Wikipedia, https://de.wikipedia.org/wiki/ Operation_Avalanche_%28Zweiter_Weltkrieg%29(aufgerufen 14.2.2025)
Robert Capa ist eine Ikone der Kriegsfotografie, bekannt für seine riskanten Einsätze und seine ungeschönte Darstellung der Kriegsrealität. Geboren als Endre Ernő Friedmann in Ungarn, emigrierte er in den 1930er Jahren nach Paris, wo er sich als Fotograf etablierte.
Um mehr Aufmerksamkeit für seine Arbeiten zu gewinnen, erschuf er die fiktive Figur „Robert Capa“. Capa war ein Pionier der modernen Kriegsfotografie und Mitbegründer der berühmten Fotoagentur Magnum Photos (1947).
Das Bild zeigt amerikanische Soldaten in der Nähe des Chiunzi Passes, oberhalb der Amalfiküste – ein strategischer Punkt während der alliierten Invasion Italiens im September 1943. Die Operation „Avalanche“ galt der Eroberung von Salerno als Brückenkopf für den Vormarsch auf Neapel und Rom. Britische und us-amerikanische Truppen landeten an verschiedenen Stränden um Salerno. Die deutschen Verteidiger zogen sich in die Berge zurück und sicherten wichtige Passübergänge, darunter auch den Chiunzi Pass. Der Pass war ein Schlüsselpunkt auf dem Weg nach Neapel. Die 36. us-Infanteriedivision versuchten, die deutschen Stellungen auf den Höhenzügen zu umgehen. Es kam jedoch zu intensiven Gefechten in diesem schwierigem Berggelände. Nach mehreren Tagen schwerer Kämpfe, gelang es den Alliierten den Pass zu sichern und den Vormarsch nach Neapel fortzusetzen.1 Robert Capa fing die Härte der Kämpfe und die Opfer der allierten Soldaten eindrucksvoll ein und begab sich dabei selbst in Lebensgefahr.
Doch auch auf der anderen Seite gab es zahlreiche Opfer. Capa zeigt neapolitanische Frauen, die um ihre verlorenen Söhne trauern. Die Aufnahme fängt den tiefen Schmerz und die Verzweiflung ein und verdeutlicht damit die zivilen Leiden des Krieges.
Christoph Fuchs
• Robert Capa
geb. 1913 in Budapest (HU), gest. 1954 in Thai-Binh (VN)
„Along the road to Naples, American troops carrying a wounded near Chiunzi Pass“, 1943
Gelatinesilberabzug, 19,1 × 24 cm
Sammlung SpallArt, Inv. Nr. S-1882

Nguyen Ngoc Hanh war ein vietnamesischer Fotograf und Offizier der südvietnamesischen Armee. 1956 absolvierte er die École de Photographie in Toulouse in Frankreich und wurde anschließend professioneller Fotograf. Er gründete die Fotografieabteilung der vietnamesischen Armee und wurde 1961 zum Kriegsfotografen der südvietnamesischen Streitkräfte, insbesondere der FallschirmjägerEinheit. Nach dem Fall Südvietnams 1975 wurde Hanh inhaftiert und verbrachte über acht Jahre in verschiedenen Umerziehungslagern der fortan sozialistischen Republik Vietnam. 1983 setzte sich die Royal Photographic Society of Great Britain für seine Freilassung ein und es gelang ihm die Ausreise in die usa, wo er sich in San Jose, Kalifornien niederließ.
Seine eindrucksvollen Kriegsfotografien dokumentieren das Leben der Soldaten und die Schrecken des Krieges. Dieses Bild zeigt den Wiederaufbau einer zerstörten Straße. Durch die geschickte Bildkomposition des nahsichtig gesehenen Soldaten, dessen Kopf sich in einer Linie mit der Reihe seiner Kameraden befindet, fügt sich dieser in die Fluchtlinie der zu bauenden Straße ein. Hahn zeigt uns einen Blick zurück auf die Zerstörung des Krieges, aber auch auf ein Leben danach. Der Schweiß, am Rücken des Soldaten im Vordergrund, lässt uns nur erahnen, wie schwer die Arbeit für die Soldaten im Hintergrund sein muss.
Christoph Fuchs
• Nguyen Ngoc Hanh
geb. 1927 in Hà Đông (VN), gest. 2017 in San Jose (US)
„Reconstruction“, 1960er Gelatinesilberabzug, 37 × 48 cm
Sammlung SpallArt, Inv. Nr. S-778, © Nguyen Ngoc Hanh Estate

Manuel Álvarez Bravo wurde 1902 in Mexiko-Stadt geboren. Um seinen Beitrag zum Familieneinkommen beizusteuern, verließ er die Schule mit zwölf Jahren und arbeitete in einer Textilfabrik. Sowohl sein Großvater als auch sein Vater waren Amateurfotografen. Dadurch bekam Bravo früh Kontakt mit der Fotografie, die er sich durch das Experimentieren mit verschiedenen Techniken selbst beibrachte. In seiner Ethik als Fotograf prägte ihn vor allem sein Vorbild, der deutsch-mexikanische Fotograf Hugo Brehme.1
Der Arbeiterstreik in Mexiko-Stadt im Jahr 1934, bei dem es zu Todesfällen kam, war Teil einer breiteren Arbeiterunruhe im ganzen Land. Die Arbeiterbewegung war in dieser Zeit in mehrere Fraktionen gespalten, darunter die dominierende Confederación Regional Obrera Mexicana (crom) und neuere, radikalere Organisationen. Präsident Lázaro Cárdenas, der 1934 sein Amt antrat, spielte eine Schlüsselrolle bei der Vereinigung der Gewerkschaften in der Confederación de Trabajadores de México (ctm), die einen erheblichen
Einfluss auf die Arbeitspolitik hatte. Der Streik in Mexiko-Stadt, der häufig mit Spannungen zwischen Industriearbeitern, der Regierung und den Arbeitgebern zusammenhing, fand vor dem Hintergrund wirtschaftlicher Not und sozialer Ungleichheit statt, die durch die Große Depression noch verschärft wurden. Die Bewegung war von gewaltsamen Zusammenstößen zwischen Arbeitern und Behörden geprägt, insbesondere als die Arbeiter bessere Löhne und Arbeitsbedingungen forderten. Diese Spannungen führten zu zahlreichen Streiks, Protesten und manchmal auch zu Todesfällen, vor allem in den Arbeiterklassen, die in der Industrie und der Landwirtschaft tätig waren.2
Diese Periode von Arbeitskonflikten fiel auch mit der größeren weltweiten Welle von Arbeiterstreiks in den frühen 1930er Jahren zusammen, wie dem us-Textilstreik von 1934, der ebenfalls Gewalt und Todesopfer forderte.
Christoph Fuchs
1 Manuel Álvarez Bravo, Wikipedia, https://de.wikipedia.org/wiki/ Manuel_%C3%81lvarez_Bravo (aufgerufen 18.11.2024)
2 Encyclopedia, Mexican Labor Confederations, https://www.encyclopedia.com/ history/encyclopedias-almanacs-transcripts-and-maps/mexican-laborconfederations (aufgerufen 18.11.2024)
• Manuel Álvarez Bravo
geb. 1902 in Mexiko-Stadt (MX), gest. 2002 in Mexiko-Stadt
„Striking Worker Murdered, Mexico“, 1934 (Abzug 1980)
Gelatinesilberabzug, 18,2 × 23,8 cm
Sammlung SpallArt, Inv. Nr. S-2799, © Manuel Alvarez Bravo / Bildrecht, Wien 2024


• Michelangelo Buonarroti
geb. 1475 in Caprese (IT), gest. 1564 in Rom (IT)
„Römische Pietà“, 1498–1499
Marmorskulptur im Petersdom, Rom
Die italienische Fotografin Isabella Gherardi zeigt mit ihrer Arbeit Maternity (Mutterschaft) die zweideutige Beziehung zwischen Mensch und Tier. Tiere sind manchmal unsere Haustiere, manchmal unsere Lebensmittel.
Sowohl der Titel der Arbeit, wie auch die Komposition, verweisen auf die Römische Pietà von Michelangelo. Obwohl die Marmorskulptur eine Momentaufnahme der Ruhe darstellt, erzeugt der Kontrast zwischen Maria und Christus eine subtile Dynamik. Die tiefen Falten in Marias Gewand vermitteln einen naturalistischen und lebendigen Körper in einer starren Pose im Gegensatz zur ungewöhnlichen Leichtigkeit der Positionierung von Christus auf Marias Schoß – der tote Körper scheint nicht in sich zusammengefallen, sondern wird zärtlich getragen – erscheint fast schwebend. Diese Spannung zwischen Ruhe und Bewegung verstärkt das dramatische Potenzial der Szene.
Diese Körperlichkeit inszentriert Gherardi übertragen in eine Mensch-Tier-Beziehung. Der Kontrast entsteht hier durch den weißen, reinen Mantel und dem inspezierenden Blick der Frau zum roten Fleisch und den teilweise hervorquellenden Gedärmen des Hasen. Unnatürlich zärtlich hält sie das abgezogenen Tier in ihren Händen.
Christoph Fuchs
• Isabella Gherardi
geb. 1960 in Florenz (IT), lebt und arbeitet in Rom (IT)
„Maternity 1“, 2008
C-Print, 50 × 50 cm
Sammlung SpallArt, Inv. Nr. S-929, © Isabella Gherardi

Dieser Katalog erscheint anlässlich der Ausstellung
BODIES – Körperbetonte Fotografie der Sammlung SpallArt
5. April bis 4. Oktober 2025 im Depot der Sammlung in Salzburg
Impressum
Herausgeberin
Sammlung SpallArt
Jakob-Auer-Straße 8, 5020 Salzburg mail@sammlung-spallart.at www.sammlung-spallart.at
Kuratorin
Cäcilia Steinkellner
Konzeption, Redaktion und grafische Gestaltung
Christoph Fuchs
Lektorat
Andra Spallart
Druck und Bindung
Holzhausen, Wolkersdorf, Österreich
© 2025 Sammlung SpallArt und die Autor:innen